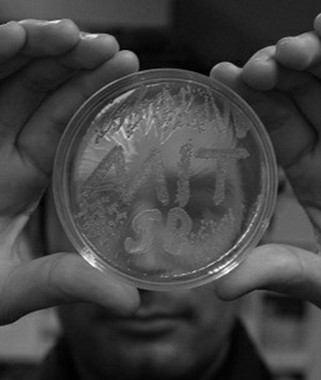

El ladrón de cerebros
Pere Estupinyà
El autor de este libro es capaz ahora de sugerir a sus lectores los diez mandamientos del mundo moderno. En primer lugar, que tiene algo de absurdo preocuparse sobremanera de saber si hay vida después de la muerte cuando acabamos de descubrir que hay vida antes de la muerte. Por primera vez en la historia de la evolución, los humanos tienen futuro: gracias al descenso alucinante de la mortalidad infantil, aunque no sólo a ello, su esperanza de vida se ha triplicado; disponen ahora de unos treinta años redundantes en términos biológicos, después de haber agotado parte de su vida sobreviviendo y perpetuando la especie. Pere Estupinyà es consciente también, al contrario de lo que ocurre con muchos de sus lectores, que la felicidad está en la sala de espera de la felicidad y que no tiene mucho sentido empeñarse en culminar el proceso que conduce a su fin, postergando en el camino los detalles y los compases de espera en los que yace gran parte de la felicidad ansiada. Mucho más que en su expresión final y pasajera. Tiene, además, la felicidad otra faceta desconocida hasta ahora que es la ausencia de miedo. A mis nietas nadie les ha enseñado en la escuela todavía a distinguir entre ansiedad —que pone en estado de alerta para competir o superar un desafío—, y miedo; el miedo que corroe e interrumpe el crecimiento de las uñas y de la adolescencia. Nadie nos ha preparado para lidiar con el miedo.
El mamullo que flota en el aire del ir y venir del equipo que tanto ha contribuido a acercar la ciencia a la cultura popular —el lugar de trabajo del autor durante muchos años— traduce la conciencia del error que han cometido, sin saberlo, muchos divulgadores de la ciencia. Hay que empatizar, efectivamente, y saber ponerse en el lugar del otro que escucha, pero no se puede olvidar que la reflexión predicadora de lo que viene no puede emitirse demasiado delante de las masas porque —como decía Maurice Thorez, secretario general del Partido Comunista Francés—, se corre el riesgo de encontrarse solo y gesticulando. Hay que estar justito delante, pero pegado a las masas, diría el dirigente francés.
Es más, el autor de este libro es perfectamente consciente de que en el proceso de empatía para colocarse en el espacio ocupado por los demás, la neurología moderna nos ha enseñado que no se puede exagerar la imitación de los sentimientos de otro si no se quiere correr el riesgo de desbaratar el proceso de empatía: su exceso desemboca en la pérdida del control de la ejecución de la obra. La dura realidad se lo ha enseñado a muchos artistas y competidores.
Después de tantas divagaciones inútiles o casi, sabemos ahora también que la belleza es la ausencia del dolor. El resto de los mamíferos nos ha enseñado que la belleza viene definida por el nivel de fluctuaciones asimétricas; cuando este nivel es inferior al promedio, quiere decir que el individuo examinado no ha conservado las huellas o rastros de enfermedades pasadas. Quiere decir, en otras palabras, que su metabolismo funciona a las mil maravillas; que no hay ni rastro de dolores previos como la malaria; que el organismo en cuestión puede competir con cualquiera.
En la escuela, en la universidad, en las empresas hemos aprendido todos en el equipo creado en su día con Pere Estupinyà, Miriam Peláez, Susana Pinar, Beatriz Barco, Cristina Sáez, Octavi Planelles, Magda Vargas o Javier Canteros y el autor de este prólogo, que el reconocimiento social es el mejor predictor de la salud. No sólo se ha comprobado que el último mono en la jerarquía social tiene muy mala salud, sino que el décimo o undécimo la tiene mucho mejor que el vigésimo. La práctica corporativa todavía no inculca el hecho elemental de que la empresa no puede sobrevivir sin la conciencia de que sus empleados o profesionales controlan algo de su vida. Tiene que ver con el gran descubrimiento de la inteligencia social. Lo que importa no es tanto lo que ocurre en el interior de un cerebro determinado sino la chispa que provoca su relación o contacto con otro cerebro. Cuando hablamos de redes sociales —Pere Estupinyà pudo corroborarlo en Harvard—, estamos aludiendo al único modo de innovar. La innovación hoy en día es social por encima de todo y multidisciplinar. Ahora resulta, millones de años después de haberla compartido, que la manada sigue siendo esencial en la vida de los organismos individuales. Sabemos de ella antes que de nadie y no la olvidamos hasta el día en que se descohesionan nuestros átomos. ¿Cómo si no pudo saber Wiliam James, el fundador de la psicología moderna, sin apenas datos en que sustentarlo, que la vida transcurre buscando el amor y el reconocimiento del resto del mundo?
En su peregrinar luego y en su punto de partida antes, el autor de este libro aprendió también y supo practicar enseguida que hay muchísimas preguntas que no tienen respuesta y que cuando la gente no tiene más remedio que constatar esta evidencia, busca respuestas que yo llamo conspirativas. Cuando no se sabe de quién es la culpa se atribuye a las multinacionales, a la CIA, a Dios o al Diablo. A cualquiera, menos admitir lisa y llanamente que no lo sabemos todavía.
Cuentan que, al comprobar el científico Laplace la teoría del equilibrio permanente de los cuerpos celestes, Napoleón le preguntó si había consultado el teorema con Dios. «Esto en concreto no me hace falta consultarlo —replicó Pierre Simon Laplace—. Esto ya lo he demostrado yo. Cosa distinta es todo el resto».
La anécdota encierra la humildad y la grandeza del método científico. La belleza de la ciencia consiste en intentar en todos los casos comprobar mediante la experimentación y la prueba las tesis sugeridas. Y cambiar de opinión cuando alguien demuestra lo contrario. A veces —no es el caso del autor de este libro, empapado del espíritu del equipo que supo crear y difundir—, las personas no quieren cambiar de opinión ni que los maten; lo consideran una traición no sólo a las tradiciones, sino a su condición ciudadana. La naturaleza, en cambio, nos enseña que hasta ella cambia su estructura mediante las transiciones de fase; lo que antes era sólido ahora es gas o líquido. Este libro es una prueba bien inteligente de ello.
EDUARD PUNSET.
Recuerdo estar sentado frente al océano en un lugar recóndito de la península de Zapata, cerca de Playa Girón. Antonio nos había conducido hasta allí con la promesa de mostrarnos una de las zonas costeras con más encanto de Cuba.
No había exagerado. El entorno natural era precioso, se respiraba una paz absoluta, y el mar se mostraba solemne. «Inmejorable», pensé para mis adentros. Entonces Antonio se acercó ofreciéndome unas gafas de bucear. «Muchas gracias, Antonio, pero ahora no me apetece demasiado. No soy muy diestro en el agua y me da un poco de pereza. Además, el paisaje en sí ya es idílico». Antonio insistió hasta convencerme. A los pocos minutos me puse las gafas y empecé a caminar hacia la orilla sin grandes expectativas, con el único objetivo de distraerme un poco. No tenía ni idea de qué me esperaba. Nada más sumergir la cabeza en el mar mis ojos se abrieron como platos. La roca sobre la que había estado descansando estaba rebosante de corales preciosos, varios peces de colores nadaban a mi alrededor, y al girarme divisé una tortuga alejándose pausadamente a escasos 25 metros. No recuerdo el tiempo que pasé absorto observando ese espectáculo inesperado, pero sí tengo muy presente mi reacción en cuanto salí de él: ¿cómo podía tener esa maravilla tan cerca y no ser consciente de ello? ¿Cómo podía haber estado a punto de perdérmela? No sé cuántas veces agradecí a Antonio su insistencia al ofrecerme las gafas y permitirme descubrir lo que para mí era un mundo desconocido. Cuando dirigí de nuevo la mirada al océano continuaba siendo precioso, pero ya no podía conformarme en observar sólo su superficie.
Esta experiencia refleja el mismo entusiasmo que siento por la ciencia. Para mí, la ciencia son las gafas que nos permiten escudriñar en la estructura del universo, descubrir el mundo microscópico, explorar el interior del cerebro humano, comprender nuestro comportamiento, y disfrutar de toda la complejidad y esplendor que oculta la naturaleza. Sin la ciencia, ni siquiera seríamos conscientes de la existencia de tales tesoros.
Estamos en un momento de la historia intelectualmente sobrecogedor. Los científicos están encontrando respuestas a infinidad de profundos interrogantes, pero sobre todo nos están ofreciendo nuevos y turbadores misterios con los que estimular nuestra inquieta curiosidad. Y, creedme, es una lástima perdérselo. Una vida sin ciencia es como una vida sin música. Puede ser igualmente maravillosa, pero sin duda desaprovechamos una de sus grandes ofrendas. Especialmente porque disfrutarla no requiere un lenguaje sofisticado ni grandes conocimientos previos. Sólo se precisa un cerebro receptivo. Por eso me gustaría emular a Antonio y proponeros que nos pongamos las gafas de la ciencia y me acompañéis en una expedición hacia las fronteras del pensamiento científico más actual. No saber bucear no es una excusa, sino una motivación añadida.
No perdamos más tiempo alejados de la explosión de conocimiento que tenemos frente a nosotros. ¡Lancémonos de cabeza a explorar el apasionante océano de la ciencia!
Escribí este texto en agosto de 2007 durante uno de los momentos más excitantes de mi vida. La inmersión científica que estaba a punto de emprender era realmente muy especial. Había sido elegido como uno de los diez periodistas científicos que iban a pasar un año en Boston becados por la Fundación Knight en el Instituto Tecnológico de Massachusetts (MIT), con el único objetivo de introducir en nuestros cerebros tanta ciencia como cupiera. Íbamos a recibir seminarios privados con los principales investigadores del MIT y Harvard, podríamos asistir como oyentes a las asignaturas que más nos interesaran, entrevistar personalmente a científicos, rastrear en profundidad cualquiera de sus laboratorios, y asistir a todas las conferencias o eventos que quisiéramos. Teníamos libertad absoluta. Se trataba de actualizar nuestros conocimientos sobre las temáticas científicas que más nos fascinaran, para así poder transmitirlos de manera más eficiente a la sociedad. Un lujo. No podía permitir que un cerebro ineficiente guardara toda esa preciosa información de manera desordenada, y acabara perdiendo o tergiversando las lecciones aprendidas. Tenía que almacenarla en algún lugar seguro y difundirla por el mayor número de mentes. Una vaga idea se transformó en una misión desafiante: debía recoger todas las reflexiones y enseñanzas acumuladas durante mis años previos como comunicador científico, añadirles la inestimable información que iba a recibir durante los nueve meses siguientes, y comprimirla en un libro sobre el fabuloso mundo de la ciencia. La ilusión era desbordante. Empecé el reto con gran entusiasmo, pero a las pocas semanas me di cuenta de que algo fallaba; pasaba demasiado tiempo encerrado en casa, perdiéndome sesiones científicas extraordinarias. Entonces alguien me dio un acertadísimo consejo: escribir un blog. Un blog me permitiría compartir la información de manera ágil, fresca, directa y desenfadada; ampliar los temas que más me interesaran, y encima recibir la interacción inmediata del lector. Escribir «Apuntes científicos desde el MIT» en elpais.com fue una satisfacción absoluta, y a estas alturas continúa siéndolo. El primer y muy sentido agradecimiento de esta introducción es para todos sus lectores, cuyos nombres, seudónimos, enlaces a páginas personales, mensajes o lecturas anónimas desde cualquier parte del mundo me han acompañado y motivado a continuar volcando ideas sin dueño en busca de acogida. A diferencia de la comida, compartir información no es dividirla sino multiplicarla.
Durante mi aventura científica en Cambridge el blog fue una compañía inestimable, un estímulo añadido para no saltarme ninguna conferencia, y la mejor excusa para seguir otro consejo colosal recibido durante la beca en el MIT y que aparecerá en la segunda mitad de este libro: «rascar donde no pica». Rascar donde no pica es dejarte seducir por nuevos intereses además de los que ya tienes, mantener un constante espíritu de búsqueda entre lo desconocido y permitir que la curiosidad sea la que guíe tu aprendizaje. Ése era el verdadero motor de los «Apuntes científicos desde el MTT». Pero era tanto el estímulo intelectual al que estaba expuesto que en ocasiones sentía cierta frustración. Por una parte, no tenía tiempo de redactar en el blog todas las ideas que recibía y, por otra, había temas inabordables en las escasas mil palabras que tenía una entrada. Creo que mi subconsciente estaba pensando: «Ya llegará el momento…». Ese momento apareció con fuerza un día en otoño de 2008, cuando con cierta nostalgia empecé a repasar las libretas con apuntes de las clases, seminarios o entrevistas. Al descubrir todas aquellas letras «B» inéditas que anotaba entre los apuntes cuando alguna idea novedosa podía convertirse en una entrada del blog, me convencí de que era el momento ideal para retomar el proyecto de escribir un libro. Por fin podría abordar todas esas reflexiones con la profundidad que merecían y buscar una forma coherente de presentarlas. Para ello me fijé en tres de mis grandes obsesiones: la primera era contextualizar la información, presentar los antecedentes que enmarcan a un determinado estudio científico y las historias recorridas hasta llegar a él. Saber por qué es especial. La segunda obsesión la cultivé en el MIT, actuando como un ladrón de cerebros promiscuo y desvergonzado que usurpaba los conocimientos que mentes privilegiadas habían tardado años en acumular. Cuando entrevistaba a algún científico siempre le exigía: «No me cuentes lo que ya puedo encontrar en internet. Dime en qué estás trabajando ahora mismo aunque no esté publicado todavía. Confiésame lo que más te intriga en tu campo, qué será noticia dentro de uno, cinco o diez años, y comparte tus ideas al respecto». Pero la tercera obsesión era quizá la más importante: para distribuir mi botín debía traducirlo a un lenguaje lo más natural y coloquial posible. Si no, no serviría de nada. Por eso, los textos que encontrarás a continuación intentan ser sencillos, frescos, con cierto toque informal, y rehúyen el detalle cuando ello pueda significar la desconexión con el lector. Soy consciente de que ciertas partes sabrán a poco y quizá desearás que hubiera perseguido un poco más el hilo científico de la historia. Reconozco que si tienes esa sensación, la percibo más como un éxito que como un inconveniente. No quiero que te sacies con un solo plato, por exquisito que sea; hay un bufet muy variado por degustar, y me gustaría que este libro tuviera el efecto endiablado de dejarte con más hambre de ciencia de la que ahora puedas tener. Si la lectura de estas páginas te incita a interesarte por un tema y buscar más información por tu cuenta, habrá sido un logro. También puede ser que, condicionado por mi pavor a resultar farragoso, eches en falta algunas definiciones básicas sobre conceptos científicos. Que no se enfaden los más puristas, pero no son tan imprescindibles como crees, y el libro se puede seguir perfectamente sin ellas. Si antes de entrar en una exposición de arte contemporáneo te forzaran a leer sesudas explicaciones para apreciar mejor las obras expuestas, quizá te darías media vuelta. Disfruta de la visita y, si no tienes muy claro qué es un gen o un nucleótido, te lo imaginas sin reparos. Estoy convencido de que por el contexto tú mismo lo averiguarás, lo encajarás dentro del relato, y lo asimilarás como un concepto propio. No le tengas miedo ni excesivo respeto a la ciencia; hazla tuya.
Confieso que es difícil salir de copas conmigo y que no te explique alguna anécdota científica que ese día tenga en la cabeza. Suelo hacerlo tan a menudo que he deducido un par de cosas: toda persona con un mínimo de curiosidad siente un gran interés por la ciencia. Menos algunos de los que trabajan once horas al día en ella, hay muy pocos que tras mencionar la palabra «neurona» o «quark» durante una cena no muestren disposición a escuchar más acerca de ellos. Pero también es verdad que la atención prestada tiene un límite. En una conversación cara a cara enseguida percibes cuándo toca cambiar de tema o enfocarlo de manera diferente. En un libro es más difícil. Por eso, si a pesar de mis buenas intenciones algún bloque se te hace pesado, ¡sáltatelo! Sé intelectualmente promiscuo. Ya regresarás a él, pero no permitas que nadie te aburra.
Rescato el paralelismo con el museo de arte para subrayar una cuestión: a nadie le interesa visitar una galería que exponga cuadros mediocres, ni bucear en aguas turbias. De la misma manera, aquí hablamos de las maravillas de la ciencia, abordamos los temas más estimulantes, nos fijamos en las publicaciones científicas de referencia y seleccionamos las mejores obras que han llegado a nuestras manos. Pero no pretendemos idealizar la ciencia. Como actividad humana que es, la investigación científica también tiene sus entrañas. Para infundir cierto sentido de la realidad, en algunos capítulos visitaremos también mares contaminados, perderemos la inocencia, y aportaremos de manera sutil una visión crítica de la ciencia y los actores que la construyen. Debo esta actitud recelosa y poco condescendiente a los protagonistas del segundo agradecimiento de esta introducción: mis compañeros periodistas John, Ivan, Julie, Jonathan, Keith, Molly, Kathy, Catherine, Esta, Zarina, Pam y nuestro ilustre director Boyce Rensberger del fantástico programa Knight Science Journalism Fellowship del MIT, donde aprendí más —a todos los niveles— que en ningún otro período de mi vida. Nunca olvidaré esa etapa, ni las personas que me acompañaron. La lista de científicos y amigos que aquí debería citar sería interminable y seguro que cometería la injusticia de olvidarme a más de uno, pero tengo una buena excusa para destacar al físico Roberto Guzmán de Villoria y a los neurocientíficos Miquel Bosch y Victoria Puig por compartir sus conocimientos en el blog además de su amistad. Miembros del Euroclub, contertulios y camareros del Miracle of Science y el River Gods: brindo la penúltima con vosotros una vez más. Sin salir de Estados Unidos, también quiero agradecer la flexibilidad y la confianza de mis jefes y compañeros de trabajo en la oficina de comunicación de los Institutos Nacionales de la Salud en Washington D. C. Lo aprendido inmiscuyéndome en los laboratorios del campus de los Institutos Nacionales de la Salud (NIH) en Bethesda está bien presente en este libro. Gracias Calvin, Sylvia, y científicos de esta descomunal institución.
La experiencia profesional fuera de España ha sido intensa y gratificante, pero no habría podido llegar al MIT sin el impagable aprendizaje recibido por quienes fueron realmente las piezas clave en mi formación. Trabajar cinco años directamente con el genial y carismático Eduard Punset en Redes, y ser durante dos temporadas editor de este programa televisivo, un referente en la divulgación de la ciencia en lengua española, transformó una aventura en una profesión. Mi más profundo y sincero agradecimiento a Eduard por darme esa oportunidad y depositar tanta confianza en un joven bioquímico de Tortosa formado en la Universidad Rovira i Virgili de Tarragona, que llegó a su oficina sin experiencia alguna pero armado con mucha ilusión. Gracias también a la ilusión, porque en momentos importantes es la que decide. Con mis ex compañeros de Redes me ocurre lo mismo que con mis amigos de Boston: resulta imposible citarlos a todos. Pero Miriam Peláez no puede faltar en esta entrega, y representa a todos ellos.
Los agradecimientos se complican todavía más cuando sales del ámbito profesional y empiezas a pensar en las personas que han participado de tu andadura científica. Que sirvan como representantes de mi estimado y nunca olvidado grupo de amigos: a Maite por abrir tanto los ojos cuando le hablaba de la expansión del universo; a Ramón por insistir en que primero pensara en imágenes y luego en texto (algún día le haré caso); a David por sugerir que fuéramos a bucear con Antonio; y al filólogo Elies por aparecer los mediodías por mi piso del casc antic de Tarragona provisto de moscatel a granel y ganas de compartirlo con mis almendras mientras discutíamos sobre los libros de ciencia que me traía, y los vídeos de un programa de ciencia que se emitía los domingos de madrugada y terminé mirando con libreta y bolígrafo en mano.
Marta… Nuestros caminos se separaron justo antes de empezar este libro, pero no hubiera llegado hasta aquí sin los maravillosos años que pasamos juntos. Tanto esta obra como su autor siempre lo recordarán.
Una bella economista con acento italiano ha estado presente durante la segunda parte de este libro. Gracias, Fazia, por tus consejos, por ser mi amor, por mostrarme que la vida es una película, y por dejarme que te acompañara a través de ella con un guión cargado de suspense, acción, humor, sensualidad, intriga, surrealismo y romanticismo.
Y cómo no, por último gracias al tremendo apoyo e incondicional cariño que siempre he recibido de Jaume, Consol, Ana y mis maravillosos padres Pepita y Pere. Vosotros sois con quienes más orgulloso me siento de compartir este libro.
Pero no perdamos más tiempo y, esta vez sí, ¡tirémonos de cabeza al océano de la ciencia!
Capítulo I
El cerebro que se investiga a sí mismo
§1. Cienciadicto
§2. Cerebro a trocitos
§3. Mintiendo bajo la fMRI
§4. Serotonina, oxitocina y el amor engañoso
§5. La mejora de tus capacidades cognitivas
§6. Fusión del cerebro con la máquina
§7. Neurofilosofía: buscando moralidad en la naturaleza humana
§8. Neuroarrogancia en los juzgados
§9. Tu libertad es una ilusión del cerebro
§1. Cienciadicto
Quizá fue resolviendo problemas de física en el instituto, o cuando sinteticé mi primer polímero durante unas prácticas de química orgánica, o al sentirme desbordado por la complejidad del sistema inmunológico en la licenciatura de bioquímica, ampliando fragmentos de ADN para mi interrumpida tesis doctoral, o leyendo libros sobre la elegancia del universo y el egoísmo de los genes; pero en algún momento de mi vida constaté que mi cerebro albergaba una curiosa peculiaridad: cuando consumía ciencia, las neuronas de mi nucleus accumbens recibían más dopamina de lo habitual.
El nucleus accumbens es el verdadero centro del placer en el cerebro. Cuando comes, bebes, haces el amor, practicas deporte, o realizas cualquier acción que permitió a tus antepasados sobrevivir y dejar descendencia, te recompensa con una sensación de bienestar inmediata. Es el premio que nos incita a repetir dicha actividad siempre que sea posible. Esta brújula de la supervivencia se encuentra integrada en lo más profundo de nuestro cerebro, en un conjunto de estructuras primitivas llamado sistema límbico cuya principal función es explicarnos mediante las emociones qué nos resulta positivo, a qué debemos tenerle miedo, qué olor nos generará repulsión, o cuándo merece la pena estar triste. Luego, gracias a nuestra moderna corteza cerebral, podemos decidir si le hacemos caso o no, pero ese instinto primario es la información básica de la que partimos, codificada poco a poco a lo largo de nuestra historia evolutiva.
Siempre que la parte instintiva y la racional formen un buen equipo y ninguno tome el mando por completo, todo se mantendrá en un relativo orden. Durante mucho tiempo lo conseguí.
Pero algo extraño me sucedió hace sólo un par de años, durante la etapa que pasé en Estados Unidos becado por el MIT, consumiendo fuertes dosis de ciencia en estado puro. El nivel de satisfacción que experimentaba al conversar con los científicos, visitar sus laboratorios, explorar sus métodos de trabajo, descubriendo anécdotas o asimilando fenómenos complejos, era muy superior a lo normal Y, además, las dosis eran cada vez más frecuentes. En lo más interno de mi cerebro, las neuronas del área ventral tegmental debían de estar segregando cantidades inusualmente altas de dopamina en dirección al nucleus accumbens, porque cada vez buscaba con más insistencia rodearme las veinticuatro horas de fuentes de conocimiento científico. Al principio no me pareció un problema; me sentía eufórico y encantado de la vida, pero empezó a preocuparme cuando advertí que estaba perdiendo interés por el resto de las actividades cotidianas. Las prisas por abarcar el máximo de ciencia posible hacían que introdujera alimentos en el estómago sin ninguna búsqueda de satisfacción a cambio, abandoné actividades recreativas que antes solían distraerme, otros tipos de información no científica llegaron a parecerme banales, e incluso el instinto reproductor se manifestaba en menos ocasiones y solía verse estimulado en momentos de euforia científica.
Me estaba enganchando. Mi cerebro estaba generando dependencia a la ciencia. Abrumadas por las elevadas dosis de dopamina que segregaba, las neuronas del circuito del placer habían reducido su cantidad de receptores celulares para no permitirme sentir un nivel de satisfacción constante. La brújula de las emociones sólo funciona bien cuando alterna momentos de bienestar con otros de indecisión; si fuera de otra manera, no serviría para orientarnos. La consecuencia final fue que la ciencia se convirtió en lo único que lograba darme verdadero placer. Me estaba transformando en un cienciahólico.
Si en ese momento hubieran analizado la actividad de mi cerebro con técnicas de neuroimagen, posiblemente habrían observado lo mismo que les ocurre a los enamorados o los ludópatas cuando observan las fotografías de su pareja o las máquinas tragaperras —o, en mi caso, ciencia—: la actividad cerebral aumenta en las áreas relacionadas con el deseo, y disminuye en las implicadas en el autocontrol, la toma de decisiones y la interpretación más racional del entorno que nos rodea.
De acuerdo, reconozco que quizá mi cerebro está utilizando ese viejo truco de sobredimensionar experiencias específicas del pasado, y estoy exagerando mis recuerdos. Ni en los momentos de máximo fervor científico el placer que sentía al entrar en un laboratorio debía de ser muy diferente al que puede experimentar un forofo del fútbol cuando va al estadio, un apasionado del arte cuando explora un nuevo museo, o un amante de la alta cocina cuando visita un nuevo restaurante.
Posiblemente no pasó de una obsesión sólo enfermiza en momentos puntuales; pero esta reconstrucción desenfadada del proceso de adicción me parecía una buena analogía para recoger algunas de las maneras de estudiar el cerebro de las que hablaré en las próximas páginas de este libro.
Por un lado, el circuito placer o recompensa es un vestigio evolutivo que muestra cómo la selección natural ha ido condicionando nuestro comportamiento además de nuestros cuerpos, y permite exponer el eterno debate sobre hasta qué punto somos dueños de nuestras acciones.
Por otro, comprender la química que regula la actividad cerebral nos ha conducido a diseñar fármacos como el Prozac, que bloquea los canales de recaptación de serotonina al final de las neuronas para así aumentar la cantidad de este neurotransmisor en el espacio sináptico y disminuir la tristeza en los pacientes afectados de depresión. Pero, sin duda, en un futuro cercano iremos mucho más lejos y la neurofarmacología permitirá diseñar sustancias que no sólo corrijan los cerebros maltrechos, sino que aumenten las capacidades de los sanos. El concepto de normalidad está en entredicho.
Y la otra gran revolución llegó con la capacidad de observar el funcionamiento del cerebro en tiempo real Más allá de las aplicaciones médicas, los escáneres de resonancia magnética funcional están siendo utilizados para investigar lo más profundo de nuestra personalidad. Algunos auguran que las imágenes cada vez más precisas de la actividad del cerebro podrán ser utilizadas para medir nuestra valía en ciertos trabajos, predecir los productos que vamos a comprar, detectar conductas inapropiadas, o llegar a exculparnos en un juicio si detectan que nuestras fechorías no son atribuibles a la voluntad, sino a una programación cerebral defectuosa.
No es ciencia ficción. Tras muchos siglos estudiando el cerebro ahora tenemos unas herramientas que permiten no sólo entender la base de nuestro comportamiento, sino también llegar a predecirlo y modificarlo.
En los capítulos siguientes analizaré adónde nos puede llevar esta neurosociedad. Pero antes de abordar lo más novedoso en la neurociencia actual, y apoyarnos en la optogenética, la conectómica o la estimulación eléctrica transcraneal para descender al nivel de moléculas y tejidos neuronales, no estaría mal que primero observáramos el cerebro desde cierta distancia.
§2. Cerebro a trocitos
En 1966 el neurocientífico Richard Gregory hizo famosa la siguiente frase aparecida en su libro Ojo y cerebro: «Una de las dificultades para comprender el cerebro es que es poco más que un grumo de papilla espesa».
Comprendí el pleno sentido de esta expresión durante un curso de neuroanatomía en el que nos llevaron a un laboratorio del MIT diseccionarlo.
Cuando pones ese pedacito de carne en la palma de tu mano y lo observas detenidamente, no puedes dejar de sorprenderte y pensar: funciones de su cuerpo, siente dolor, o coordina sus movimientos… Decides aceptarlo porque no se te ocurre ninguna alternativa mejor, y tarea.
Lo primero que hice fue mirarlo desde atrás, coger el trocito de tronco cerebral que quedaba de su conexión con la médula espinal y bajarlo para que el cerebelo sobresaliera y pudiera ser cortado con más facilidad. El cerebelo se encuentra justamente detrás de los hemisferios, y su principal tarea es la coordinación de movimientos, el mantenimiento del equilibrio, y el aprendizaje de habilidades motoras. Cuando alguien sufre alguna lesión en él, es incapaz de moverse correctamente o calcular distancias, pierde masa muscular, se tambalea, y cae con frecuencia. Quizá una de sus principales curiosidades es que, a pesar de representar sólo el 10 por ciento del tamaño de todo el encéfalo, posee el 50 por ciento de sus neuronas.
Una vez retirado el cerebelo, el siguiente paso fue cortar minuciosamente las fibras que conectan el hemisferio izquierdo y el hemisferio derecho del cerebro, y separarlos poco a poco para observar qué escondían debajo de ellos. Lo primero que ves son cuatro estructuras ovaladas con una especie de apéndice en medio. Las dos más grandes y centrales son el tálamo, la zona que recibe toda la información de los sentidos —a excepción del olfato—, y se encarga de enviarla al córtex cerebral. Las dos menores son los colliculus, relacionados con la percepción del movimiento y el campo visual Entre ellos y el tálamo sobresale un enigmático apéndice. Se trata nada más y nada menos que de la glándula pineal, cuya posición tan central hizo que René Descartes la definiera como el lugar donde residía el alma humana, el espacio donde el espíritu se unía con el cuerpo. Sorteando el erróneo dualismo cuerpo-mente de Descartes, la verdad es que ese casi insignificante cono rosáceo está implicado en el desarrollo sexual, la hibernación de los animales y la regulación de nuestro metabolismo, y es donde se produce la melatonina, una hormona que controla los ciclos circadianos del cuerpo que regulan el sueño y la vigilia.
Uno ya tiene ganas de empezar a diseccionar los hemisferios; pero antes conviene prestar un poco de atención a la parte que comunica el cerebro con la médula espinal. Suele pasar inadvertido, pero el tronco cerebral, además de ser un canal de fibras nerviosas procedentes de todos los rincones de tu  cuerpo, también es el que regula la respiración, el ritmo cardíaco y la sensación de dolor.
cuerpo, también es el que regula la respiración, el ritmo cardíaco y la sensación de dolor.
Ya no puedes más. Está muy bien analizar las áreas que hacen funcionar la máquina, pero los hemisferios están allí esperándote sobre la mesa para mostrarte dónde se esconden las preciosas funciones cognitivas.
La primera instrucción es separar con cuidado una capa con forma de lengua situada en la parte inferior del cerebro. Se trata del hipocampo, y es donde ahora mismo estáis guardando temporalmente las frases que vais leyendo. El grado de emoción que os susciten dichas frases hará que dentro de quince minutos se hayan consolidado de manera más o menos fuerte en otras áreas del cerebro, pero es la memoria temporal controlada por el hipocampo la que nos permite ir encarrilando una acción después de otra, o retener durante unos segundos el número de teléfono que nos acaban de dar. El hipocampo forma parte del sistema límbico, la parte más profunda y primitiva del cerebro. Ahí es donde se regulan las emociones básicas, la fuente del deseo, la agresividad, el miedo o la repulsión. En los últimos años los neurocientíficos están concluyendo que esta dicotomía entre emociones límbicas y razonamiento cortical es mucho menos nítida de lo que se pensaba, pero sin duda es ahí donde se alojan los instintos más elementales que compartimos con el resto de los animales.
 Cuando por fin llegamos al ansiado córtex cerebral, una pequeña decepción se adueñó de todos los presentes. Nos podían decir que con el lóbulo frontal se tomaban decisiones complejas, que la visión se procesaba en la parte posterior del cerebro, el tacto en la zona central, o que el lenguaje se situaba en el lado izquierdo, pero ya no resultaba tan obvio distinguir módulos claramente diferenciados. La apariencia de ese grumo de papilla espesa era más bien uniforme.
Cuando por fin llegamos al ansiado córtex cerebral, una pequeña decepción se adueñó de todos los presentes. Nos podían decir que con el lóbulo frontal se tomaban decisiones complejas, que la visión se procesaba en la parte posterior del cerebro, el tacto en la zona central, o que el lenguaje se situaba en el lado izquierdo, pero ya no resultaba tan obvio distinguir módulos claramente diferenciados. La apariencia de ese grumo de papilla espesa era más bien uniforme.
La pregunta inmediata que a uno se le ocurre es ¿y entonces, cómo saben los científicos con tanta precisión dónde está localizada cada función cognitiva? Al fin y al cabo, parece fácil alterar el cerebelo de un ratón y ver qué ocurre, pero averiguar en qué región se localiza el autocontrol, el aprendizaje, o el sentido musical parece un poco más complejo.
Junto con estudios electrofisiológicos en primates y animales de laboratorio, hasta hace poco una de las grandes herramientas eran las lesiones cerebrales. Los neuroanatomistas no debían de disgustarse demasiado cuando recibían un paciente que había sufrido un accidente, o una embolia localizada en un área concreta del cerebro que iba acompañada de una disfunción específica. Son famosos los casos del paciente H. M. que tras una lesión en el hipocampo pasó toda su vida sin poder consolidar los recuerdos. Era capaz de recordar varios aspectos de su vida anteriores al accidente, y era consciente de lo que estaba haciendo en cada momento, pero al cabo de unos pocos minutos olvidaba por completo dónde había estado, qué tarea había realizado, o con quién había conversado. Asociando estos problemas a su lesión, los investigadores pudieron ir escudriñando qué funciones albergaba el hipocampo. Por otra parte, el papel de la corteza frontal en el control de nuestros impulsos empezó a esclarecerse a mediados del siglo XIX, cuando una barra de metal atravesó el cráneo de un trabajador de la construcción llamado Phineas Gage. Su personalidad cambió por completo y pasó a comportarse como una persona violenta, impulsiva, e incapaz de planificar nada a largo plazo. El accidente le afectó el área del autocontrol. De esa época también datan los estudios de Paul Pierre Broca, quien descubrió que varios pacientes con problemas en el habla tenían lesionada una zona concreta del hemisferio izquierdo del cerebro. Desde entonces, el área de Broca se estableció como una de las principales regiones donde el cerebro procesaba el lenguaje.
Otra manera curiosa de identificar funciones en el cerebro ha sido activar zonas específicas y ver qué ocurría. Recuerdo vivamente cómo en un laboratorio de estimulación magnética transcraneal de Harvard pusieron a pocos centímetros de mi cabeza una especie de paella magnética que, al encenderse, activaba mi córtex motor y hacía mover mi brazo hacia arriba de manera totalmente ajena a mi voluntad. La estimulación magnética transcraneal se está utilizando como complemento en terapias contra la depresión, la rehabilitación de áreas lesionadas tras accidentes cerebrovasculares, el tratamiento de migrañas, la mejora de capacidades cognitivas, y como herramienta de investigación básica para observar cómo reacciona el cerebro cuando partes específicas se le encienden. Más espectacular todavía son los experimentos en que la activación eléctrica de zonas concretas de los lóbulos temporales del cerebro inducían experiencias místicas a los voluntarios que los probaban. Incluso el éxtasis religioso parecía estar localizado en un área del cerebro.
Sin embargo, la gran revolución llegó a principios de la década de 1990 con las imágenes de resonancia magnética funcional Significó un salto descomunal: por primera vez se podía estudiar cómo funcionaban los cerebros normales, además de los enfermos. El planteamiento básico de la fMRI es muy sencillo: cuando utilizas una zona de tu cerebro aumenta el flujo de sangre en ella. Por lo tanto, si eres capaz de medir estas variaciones de presión sanguínea mientras realizas una acción determinada, sabrás qué parte de tu cerebro es la responsable. Mientras escribo estas palabras un escáner de la fMRI mostraría actividad en las zonas prefrontales de mi córtex y en las relacionadas con el movimiento de mis dedos, mientras que durante vuestra lectura se encenderían las partes relacionadas con la visión, entre otras.
La fMRI es lo que ha revivido esta neo frenología por la que sabemos qué zona de nuestro cerebro es la responsable de una capacidad cognitiva determinada. Esto ha abierto las puertas a disciplinas emergentes como la neuroeconomía, que analiza nuestra toma de decisiones, el neuromarketing, que investiga el comportamiento del consumidor, la neuroteología, que estudia las zonas implicadas en las experiencias místicas o religiosas, la neurofilosofía, que intenta responder preguntas básicas sobre la naturaleza humana, y la neuroética, que pronostica cierta invasión de nuestra propia personalidad y vigila las futuras aplicaciones de la información que en el futuro pueda generar esta tecnología. Interesante. No podía leer tantos artículos sobre la fMRI sin someterme yo mismo a un escáner para ver qué eran capaces de averiguar sobre mi personalidad sin mi consentimiento.
§3. Mintiendo bajo la fMRI
Si te preguntan « ¿Has sido infiel a tu pareja?» y mientes, se activa una zona específica de tu corteza cerebral que no presenta actividad en caso de decir la verdad. ¿Es suficiente para construir el detector de mentiras más infalible que haya existido?
Eso es lo que intentaba averiguar el estudio de la Universidad de Harvard en el que participé como conejillo de indias.
Cambridge es un paraíso para los exploradores científicos. Sede del MIT y la Universidad de Harvard, si en cualquier bar de esta pequeña ciudad separada de Boston por el río Charles te presentan a alguien un miércoles por la noche, tienes bastantes posibilidades de que esté investigando un tema asombroso.
Rogier tenía tal pinta de científico que cuando me lo presentaron en el restaurante Cuchi-Cuchi le pregunté directamente por su campo de investigación. «Neurociencia cognitiva —me dijo—; analizar el sustrato más biológico de nuestros pensamientos y conducta». Le pedí un ejemplo y me explicó el siguiente estudio realizado pocas semanas antes en una universidad californiana: metieron a varios voluntarios en un escáner cerebral y les hicieron probar dos vinos diferentes. Ambos eran Cabernet Sauvignon, pero uno costaba 90 dólares la botella y el otro 5 dólares. Los participantes conocían el precio de cada vino antes de probarlo, y cuando les preguntaban cuál les había gustado más, la inmensa mayoría contestaba que el caro. No se trataba sólo de un juicio racional a posteriori, el escáner cerebral confirmaba mayor actividad en la zona del placer cuando los voluntarios tomaban el vino caro. ¿Cuál era la gracia del estudio? Pues que los científicos habían intercambiado las etiquetas de los vinos. Fantástico: conocer el precio del vino no sólo te condiciona de manera subjetiva; la sensación física de satisfacción que experimentas en tu cerebro también es considerablemente mayor. « ¡Impresionante!», pensé de inmediato, y le pregunté a Rogier en qué estaba trabajando él. Se quedó pensando un momento y dijo: «Espera… ¿te gustaría participar en uno de nuestros estudios?». «¡Claro que sí!», respondí «Pues entonces no puedo explicártelo todavía para no condicionarte. Pásate la semana que viene por el Departamento de Psicología de Harvard y lo preparamos». Así lo hice.
Durante esa reunión inicial Rogier no soltó ni el más ligero indicio sobre el contenido del estudio. De hecho, se limitó a pedirme que rellenara un montón de cuestionarios con datos de lo más eclécticos: nombres de personas conocidas, tests de habilidad visual, fechas significativas para mí, preguntas sobre mi pasado, aficiones. Pasados unos veinte minutos Rogier regresó y, sin grandes explicaciones, acordamos el día que debía presentarme en el Centro de Imagen por Resonancia Magnética del Massachusetts General Hospital.
Cuando un par de semanas después llegué a mi cita con la fMRI, volvieron a darme un listado de fechas para que confirmara cuáles eran realmente importantes en mi vida. Además me pidieron que también recordara el 24 de febrero como si fuera un día trascendental para mí.
Luego bata blanca, fuera metales, túmbate boca arriba, deja que te enclaustren la cabeza entre dos espumas para mantenerla completamente inmóvil, pregunta retórica sobre si estás cómodo, y hacia dentro de un estrecho aparato en el que se escuchaban ruidos muy extraños. Durante dos largas horas mi único contacto con los investigadores fue una pequeña pantallita por la que recibía toda la información, y dos teclas debajo de mi dedo índice y corazón con las que podía contestar «sí» o «no» a las preguntas que me realizaban.
El primer escáner realizado no medía actividad, era sólo para dibujar un mapa tridimensional de la estructura detallada de mi cerebro, sobre el que después insertarían las imágenes de actividad.
El segundo escáner ya empezó a medir en qué áreas de mi cerebro aumentaba el flujo sanguíneo cuando llevaba a cabo las pruebas que me solicitaban. La primera fue muy sencilla, simplemente iban apareciendo fechas y debía responder si tenían algún significado para mí. Pasaron las mismas varias veces en diferente orden, y las únicas que identifiqué como importantes fueron mi cumpleaños y el 24 de febrero. Luego me dieron otras instrucciones: cuando viera mi cumpleaños tenía que mentir y pulsar la tecla «no», como si fuera cualquier otra fecha sin sentido alguno.
En principio, al mentir de manera consciente una zona de mi cerebro se debía iluminar.
Pero ése no era el objetivo del estudio, ya que dicho efecto ya había sido demostrado con anterioridad. Lo nuevo llegaba en la tercera tanda de escáneres. Se trataba de repetir exactamente lo mismo, pero añadiendo una pequeña tarea adicional Al mismo tiempo que respondía debía realizar un pequeño gesto con la mano izquierda. Hice los tests de nuevo varias veces, y así terminó el experimento… ¿Ya está?
Luego Rogier me explicó mejor qué había sucedido: en realidad estaban comprobando si el escáner podía ser utilizado como detector de mentiras. Su hipótesis de partida era que no. En condiciones ideales, cuando alguien miente sí se puede distinguir claramente una zona iluminada bajo el escáner, pero sus sospechas eran que esa zona también podía verse afectada por otras acciones que realizaras al mismo tiempo. El grupo de Rogier quería ver si en la tercera prueba, el hecho de mover conscientemente la mano izquierda ya era suficiente para interferir en la señal que aparecía cuando negaba que mi cumpleaños era un día significativo para mí. Si fuera así de simple, las fMRI quedarían invalidadas como detectores de mentiras.
Regresé a casa pensando lo frágiles que parecían esos lectores de mentes, y sospechando que gran parte de los estudios conductuales publicados sobre la fMRI quizá no tenían una base demasiado sólida. Hallé la respuesta a mis dudas un par de meses después, cuando tras asistir a un seminario con Rebecca Saxe sobre sus estudios con la fMRI me acerqué y le pregunté: « ¿Se publican muchos estudios mal hechos?». Su respuesta fue contundente: « ¡Y tanto! El 90 por ciento. Ya sea por las pocas muestras, el escaso rigor, las condiciones experimentales erróneas. Incluso en las revistas de referencia». Quedé sobrecogido. « ¿Y cómo podemos distinguirlos? Por ejemplo, hace un tiempo me explicaron un estudio llevado a cabo con vinos caros y vinos baratos que parecía bastante simplista». «Pues no; ése era de los aceptables. La señal de que algo te guste o no es muy clara, porque emerge de una zona específica del cerebro. En cambio, cuando veas un estudio que se fije en alguna parte de la corteza prefrontal, desconfía, porque allí ocurren gran cantidad de acciones entremezcladas». « ¿Como los detectores de mentiras?». «¡Exacto! Eso no tiene ningún sentido».
§4. Serotonina, oxitocina y el amor engañoso
¡Claro que no somos sólo química! También somos… somos… ¡Seguro que debe de haber algo más! ¿O no?
Si por el motivo que sea esta noche tus niveles de testosterona se encuentran más elevados de lo normal, tu apetito sexual se verá incrementado y estarás más predispuest@ a buscar una aventura amorosa.
Si no tienes éxito, tranquil@, que no te vas a quedar ansios@, la testosterona sube y baja rápidamente sin grandes secuelas y al día siguiente todo empezará de cero otra vez. El «Así no me puedo ir a casa» es sólo un mito.
Pero si estás de suerte y sí tienes sexo satisfactorio con algún furtivo, entonces notarás el deleite que genera en tu cerebro el subidón de dopamim, la hormona del placer. Cuidado, porque si realmente es bueno te gustará tanto que querrás repetirlo a casi toda costa. ¡Pero que la dopamim no te engañe! En el fondo, a ella le da igual si vuelves con la misma pareja o no; incluso te permite sentirte enamorada de dos personas a la vez De acuerdo, de acuerdo, si ha estado tan bien, quizá al despedirte notes que han bajado un poco los niveles de serotonina, te sentirás desorientada y pensarás que esa persona es especial, tiene «algo» diferente, y el no estar con ella te generará intranquilidad. Empezarás a enamorarte.
Quizá tras varios chutes de dopamim notes cierta sensación de adicción Puedes relajarte y disfrutarlo tranquilo, en este estadio la testosterona y la dopamim no forman parte relevante de la historia. Desdecirse no sería traumático todavía. Lo serio de verdad llega cuando la oxitocina aparece en escena. Tu cerebro la segrega en grandes cantidades en cada orgasmo, y es la responsable del sentimiento de apego, de unirte definitivamente a tu nuevo compañero o compañera. Si hubiera una hormona del amor, ésta sería la oxitocina. Cuando estáis juntos os reduce el estrés, el miedo disminuye, aumenta la confianza, la generosidad, la sensación de bienestar en cada abrazo, es la esencia química del afecto. Y lo más importante: hace que te sientas feliz cuando observas a tu pareja feliz. Su satisfacción pasa a ser más importante que la tuya propia. Ahora sí que puedes decir honestamente «Te quiero», en lugar del «Te deseo» propio de la etapa dominada por la dopamim.
De todas formas, no te confíes. Asegúrate de mantener los niveles de oxitocina altos a base de orgasmos, porque si no, pueden ir decreciendo hasta perder el apego. Si esto os ocurriera a los dos a la vez, tampoco sería tan grave. La tristeza de la separación daría paso rápidamente a una sensación de alivio. Lo peligroso, desdichado, insano, funesto, devastador, es cuando por cualquiera de los miles de motivos diferentes que existen, la relación se rompe cuando los índices de oxitocina están al máximo. Entonces la química cerebral se vuelve loca. La serotonina baja por los suelos: te deprime, te desespera, pierdes la cordura, dudas constantemente de lo correcto e incorrecto, aparece la ansiedad, la obsesión.
Te separas y de repente tus neuronas encargadas del placer ya no segregan nada de dopamim. Notas un síndrome de abstinencia brutal. Tu cerebro pide a gritos sinápticos volver a ver a tu amado. No deberías hacerlo; es un suicidio hormonalmente hablando. Recaerás como el alcohólico que en el momento de más debilidad piensa «Será sólo una copa». Dale tiempo a tu química cerebral para que restablezca sus niveles normales. Además, allí ya no existe amor verdadero ni nada. Bueno, quizá sí lo hay, pero queda ofuscado por el deseo egoísta de sentirte mejor, de aliviar tu propio sufrimiento. En esos momentos no estás pensando en qué es lo mejor para él o ella. «Quiero continuar siendo tu amigo», puede decir el que haya salido más ileso de la desdichada ruptura. Científicamente es absurdo. Es como si pretendes curar al alcohólico diciéndole: «Debes dejar de beber. Pero puedes continuar yendo a los mismos bares, no hace falta que tires las botellas de tu casa, y dale un inocente beso al vino cada cierto tiempo». Los neurocientíficos expertos en adicción saben que eso no lleva a ningún sitio. Si les hiciéramos caso, la terapia del desamor incluiría borrar teléfonos, mails, y tirar fotos a la basura, por muy doloroso que sea.
Moléculas que condicionan nuestro comportamiento
Difícilmente aceptaríamos que este torrente de sustancias químicas en nuestro cerebro enamorado es la única justificación de nuestra conducta. Evidentemente no lo es, y uno puede pensar que toparse con una persona atractiva es lo que le hace subir la testosterona, y no al revés. Quizá, pero podemos encontrar múltiples ejemplos en los que claramente observamos que primero está la química, y luego la conducta. Tómate un café cargado cuando te sientas cansado y lo comprobarás: si estás fatigado, el aumento de adenosina en tu cerebro le indica a tus neuronas que convendría bajar el ritmo y empezar a prepararse para dormir. Pero si en ese momento introduces moléculas de cafeína en tu cuerpo, cuando lleguen a las neuronas bloquearán los receptores de adenosina impidiendo que su señal sea efectiva.
Tras un largo período de depresión, los niveles de serotonina que una neurona envía a la siguiente en las sinapsis están muy bajos. Una forma de subirlos es bloquear con antidepresivos los canales por los que la neurona emisora recapta algunas moléculas de serotonina. Si impides que algunas moléculas vuelvan a entrar en la célula, indirectamente estás aumentando la cantidad de serotonina en el espacio sináptico. Y milagro, te sientes mejor. Es rotundamente cierto que hablar con un psicólogo experto puede ayudarte tanto como los fármacos, pero si observas tus sinapsis comprobarás que por esa vía terapéutica tu serotonina también ha terminado aumentando.
Pero volvamos a la oxitocina y su trascendental función amorosa en nuestras vidas. Los investigadores sabían desde hacía mucho tiempo que esta hormona se segregaba durante el parto y estaba relacionada con el apego de las madres a sus hijos. Luego, cuando descubrieron que también se liberaba en grandes cantidades durante el orgasmo, pensaron que podría causar el mismo efecto de unión emocional en las relaciones afectivas de las parejas. Para averiguarlo, un grupo de científicos realizó una serie de experimentos con dos especies prácticamente idénticas de ratones de campo, pero que poseían una diferencia clave: los individuos de una especie llevaban una vida enteramente monógama, mientras que los de la otra no formaban ningún tipo de apareamiento permanente.
Primero los investigadores inyectaron oxitocina en los cerebros de los ratones promiscuos. Resultado: observaron anonadados que empezaban a formar enlaces estables. Luego bloquearon el efecto químico de la oxitocina en los ratones monógamos, ¿y sabéis qué?, al poco tiempo éstos dejaron de ser fieles a sus parejas. El vínculo entre «amor biológico» y oxitocina se estaba consolidando.
Pero si la oxitocina influía en el apego entre parejas y familiares, ¿por qué no en el resto de las relaciones sociales? En 2005 unos investigadores suizos se dedicaron a reclutar voluntarios, separarlos en dos grupos, suministrarles oxitocina por vía intranasal a uno de ellos, y ver si invertían más dinero en el proyecto que les proponía un desconocido. Los resultados publicados en Nature sugerían que, efectivamente, la oxitocina reducía los miedos y aumentaba la confianza en las relaciones sociales.

A base de entrenamiento, y sin contar con ninguna ayuda eléctrica, a los pocos días mi cerebro habría aprendido a realizar esta tarea con precisión y rapidez Pero la neurocientífica Heidi Schambra, que era la responsable del experimento, quería averiguar si con ese apoyo transcraneal mi habilidad motora mejoraba considerablemente más rápido. « ¿Es eso posible?», le pregunté con tono escéptico a Heidi « ¡Claro! ahora contigo estamos analizando otras áreas cerebrales, pero con este mismo experimento ya demostramos que los voluntarios cuyo córtex motor primario se estimulaba eléctricamente aprendían significativamente más rápido que el grupo control al que no enchufábamos las placas». Debí de mostrar una expresión incrédula, pues enseguida me mostró el artículo de la revista Proceedings of the National Academy of Sciences (PNAS,) donde en febrero de 2009 publicaron sus sorprendentes resultados

Y paradoja: llego a mi casa convencido de que tener un número ajustado de opciones es mejor, abro el ordenador, recibo un mail del fotógrafo que cubría el evento de los NIH a quien le había pedido un par de fotos para ilustrar el blog, y mi reacción inmediata es: «¡xxjfhs! ¡Me ha enviado sólo una! Podría haberme ofrecido unas cuantas más para poder escoger alguna en la que Barry Schwartz no pareciera dormido ni yo tuviera cara de empanado».
§5. Efectos negativos del pensamiento positivo
Visualizad un saltador de altura en un estadio abarrotado de público instantes antes de intentar superar su mejor marca personal. Escuchad las palabras que se repiten dentro de su mente: «¡Venga!, ¡venga!, ¡yo puedo hacerlo!», « ¡Soy el mejor!», « ¡Estoy preparado! ¡Éste es mi momento!». Quién sabe cómo, pero estos mensajes harán que sus músculos y su coordinación respondan mejor que si piensa: « ¡Uff! Qué alto está estooooo…», o «A ver, sé racional, si nunca has superado esta altura, ¿qué te hace pensar que vas a hacerlo ahora? Tú tranquilo, inténtalo, pero mejor no te hagas muchas ilusiones». Si fueras su entrenador, sin duda le gritarías mensajes positivos del primer estilo.
Ahora imaginemos un adolescente cuyo sueño es ser futbolista profesional y está dispuesto a entrenar lo que haga falta, e incluso sacrificar sus estudios si es necesario. Pero resulta que es un poco patata. ¿Le animaríais diciéndole que es el mejor, que querer es poder, y que algún día ganará un mundial con la selección española? Es obvio que no le pondríais el listón tan alto.
Pongamos un ejemplo intermedio, y que puede ser extrapolado a nuestras ambiciones profesionales, la búsqueda de pareja, conseguir un mejor aspecto físico, o cualquiera de los retos a los que nos enfrentamos en nuestra vida cotidiana: vuestro hijo va a jugar un partido de tenis contra un rival que es mucho mejor que él. Sus posibilidades de ganar son mínimas, pero sin duda existen. ¿Qué le decís? ¿Hacéis caso de los psicólogos defensores del «poder del pensamiento positivo», y le espoleáis diciéndole que puede ganar, que él es tan bueno como su contrincante, que va a conseguirlo, o cualquier otro mensaje positivo que aumente su estado de ánimo? En serio, ¿qué haríais? ¿Pensáis que ésta es la mejor estrategia para mejorar su confianza?
Según una investigación reciente de científicos canadienses, depende. ¿Y de qué depende?, ¿del color con que se mire? ¡No! Del nivel de autoestima de vuestro hijo. A las personas con autoestima alta el pensamiento positivo les refuerza y, efectivamente, sí provoca un efecto favorable. Pero en las que tienen baja autoestima, ocurre lo contrario de lo que aseguran la mayoría de los libros de autoayuda: el pensamiento positivo puede hacer más mal que bien.
El experimento que sustenta esta hipótesis fue publicado por unos investigadores canadienses bajo el título: «Positive self-statements: power for some, peril for others».

Otra pregunta: ¿qué tal estáis hoy?, ¿tranquilos?, ¿todo controlado? ¿O tenéis esa sensación de que algo se os escapa? Quizá no lográis sacaros el trabajo de encima, o estáis preocupados por el comportamiento desconcertante de vuestro hijo, o andáis metidos en algún lío ajeno a vuestra responsabilidad, u os notáis decaídos o enfermizos y no sabéis por qué. ¿Hay algo que os desasosiega sin que podáis hacer nada al respecto?
No pretendo despistaros. En la foto de la izquierda no hay ninguna imagen escondida, pero según un estudio realizado en la Universidad de Texas.

Al entrar en el despacho de Vera Rubin en la Carnegie Institution de Washington D. C., lo primero que vi fue una reproducción del diagrama que la convirtió en una de las astrónomas más reconocidas del siglo XX. « ¡Ésta es la fotografía de Andrómeda con la que usted descubrió la materia oscura del universo!», exclamé. «No, no, no, no. Yo no descubrí la materia oscura —replicó—. Yo observé que las galaxias giraban de una manera totalmente inesperada según las leyes de Newton y Kepler. Esto se interpretó como la primera evidencia de que la materia oscura existía, y continúa siendo la hipótesis más factible, pero también podría ser que arrastráramos un error fundamental en las ecuaciones que utilizamos para describir el movimiento de los cuerpos celestes».
Cuando a mediados de la década de 1960 Vera Rubin empezó a medir la velocidad de rotación de las estrellas de la galaxia Andrómeda, observó algo muy extraño: las situadas en los extremos giraban casi a la misma velocidad que las más internas. ¡Eso no tenía sentido! Las leyes de la física establecían que si las zonas centrales de las galaxias tenían una densidad de materia muy superior —como era el caso de Andrómeda—, allí la gravedad era mayor y las estrellas deberían rotar mucho más rápido. Era tan obvio que nadie antes se había preocupado en comprobarlo. La primera reacción de Vera Rubin al ver que esto no se cumplía en Andrómeda fue pensar que sus mediciones estaban equivocadas, o que quizá esa galaxia era especial Sin embargo, cuando realizó más mediciones y observó que en otras galaxias espirales tampoco disminuía la velocidad de rotación de las estrellas a medida que se alejaban del centro, se dio cuenta de que algo importante no encajaba. La publicación en 1970 de sus inequívocos resultados agitó a toda la comunidad cosmológica: si las estrellas en el exterior de las galaxias giraban a la misma velocidad que las centrales, eso implicaba que debían de estar rodeadas de la misma densidad de materia. Pero ¿qué materia? Los telescopios no veían nada. La interpretación de los resultados de Vera Rubin fue rompedora: confirmaban la extravagante idea expuesta en los años treinta por un astrofísico suizo muy peculiar.
Fritz Zwicky era un tipo irreverente, arrogante, de comportamiento agresivo, y que acumulaba problemas personales con la mayoría de sus colegas. Quizá por eso nunca llegó a recibir la fama que su intuición habría merecido. La principal aportación de Zwicky surgió de su tozudez en insistir que algo muy extraño ocurría en los extremos de las galaxias: según todas las observaciones sobre su rotación, las estrellas más alejadas deberían escaparse y dispersarse por el espacio. Sólo podían mantenerse bajo la influencia gravitacional de la galaxia si existía una cantidad de materia muchísimo mayor de la que veíamos con los telescopios. Y no podía tratarse de planetas u otros cuerpos «normales» que no emitieran luz. Se requería una cantidad de materia oscura tan descomunal que por fuerza debía ser de una naturaleza desconocida todavía.
Fritz Zwicky fue un visionario y sentó el concepto actual de materia oscura, pero su propuesta no fue tomada en serio hasta cuarenta años después, cuando desaparecieron sus enemigos y la astrónoma Vera Rubin aportó la prueba definitiva que demostraba la genialidad de Zwicky, y puso sobre la mesa uno de los grandes misterios de la física que, en contra de los pronósticos iniciales, más se resiste a ser solucionado.
Desde mediados de la década de 1970 se han ido encontrando muchas regiones del espacio donde existe materia oscura. Los astrónomos ven que la luz se desvía por el efecto de una gran masa invisible, u observan agrupaciones de galaxias cuya existencia requiere una concentración de materia muchísimo mayor de lo que podrían constituir planetas, estrellas, cuerpos opacos, o agujeros negros. Por fuerza debe ser algo muy diferente, ya que los cálculos más actuales aseguran que hay cinco veces más materia oscura que materia ordinaria (el universo estaría constituido por un 74 por ciento de energía oscura, un 23 por ciento de materia oscura, y un 4 por ciento de materia ordinaria). Pero ¿qué es esa materia oscura? Nadie lo sabe. Hay candidatos como el neutralino, los wimp’s, los neutrinos, los macho’s, u otro tipo de partículas tremendamente pesadas y nada interactivas, pero lo cierto es que los cosmólogos todavía no han averiguado de qué se trata. Aseguran que están muy cerca de conseguirlo, pero la ventaja de conversar con alguien como Vera Rubin, que ha vivido la historia de la ciencia de gran parte del siglo XX en primera persona, es que te puede responder: «Eso llevan diciéndolo desde hace treinta años. Precisamente a principios de los años ochenta asistí a un congreso en Harvard donde los físicos de partículas aseguraron que en cinco años averiguarían qué era la materia oscura. Lo mismo oí varias veces en los noventa, también en 2000, y hace unos meses aquí en Washington D. C. Y continúan igual de perdidos. Vale la pena que entiendan qué es la materia oscura pronto, porque algunos científicos ya empiezan a desconfiar de que realmente exista, y buscan otras explicaciones a los fenómenos extraños que observamos». Vera Rubin se refería a teorías que sugieren que las leyes de la dinámica de Newton contienen errores y deberían ser modificadas para acomodar las anomalías manifiestas en las observaciones astronómicas. La mayoría de los astrofísicos continúan apostando por la escurridiza materia oscura, pero hasta que no descubran de qué diantre está constituida, tendremos que continuar resignándonos a aceptar que no tenemos ni idea de qué materia y fuerzas constituyen y rigen al 96 por ciento del universo.
Hay personas que te inspiran, y Vera Rubin sin duda es una de ellas. De verdad es impactante estar con una persona que en su octava década de vida continúa apasionándose por el conocimiento científico, acude a diario a un centro de investigación donde todo el mundo la venera, y se sorprende de que alguien pueda mirar al cielo nocturno sin sentir deseo por conocer la estructura del universo. Cuando pretendes explotar su perspectiva y le preguntas si la astrofísica ha cambiado mucho desde que ella empezó a investigar hace más de cincuenta años, sonríe, mira hacia arriba, y es capaz de responder de un tirón: «En la primera década del siglo XX descubrimos que el universo se expandía; en los años veinte, que nuestro Sol no era el centro de la Vía Láctea; en los treinta, que había galaxias fuera de la nuestra propia; en las décadas de 1940 y 1950 aprendimos a interpretar las ondas que nos llegaban del espacio; en los sesenta descubrimos la radiación de fondo de microondas; en los setenta, la materia oscura; en los años ochenta vimos que en el centro de cada galaxia había un agujero negro; en los noventa llegó la energía oscura y la expansión acelerada del universo, y en esta primera década del siglo XXI estamos asistiendo a la explosión de los planetas extrasolares. Ha sido un gran siglo, y no hay ninguna razón para imaginar que esto vaya a parar». « ¿Y cuál prevé que será el gran descubrimiento de este siglo?», pregunto excitado y de inmediato. «Encontrar algún planeta con vida extraterrestre —responde convencida—. Nuestra galaxia tiene 200.000 millones de estrellas, y sabemos que existen como mínimo 200.000 millones de galaxias. No importa de cuántas maneras quieras combinar los elementos químicos. Me sorprendería muchísimo que no hubiera seres parecidos a nosotros, y muchos otros tipos de vida, en un cosmos tan descomunal».
§3. Exoplanetas: la búsqueda de vida extraterrestre
Olvidaos de encontrar vida en Marte, en los hielos del satélite Europa, o en cualquier rincón de nuestro sistema solar. Los alrededores de nuestro planeta parecen estar desiertos. Pero que esto no os deprima en absoluto; al contrario, estamos cada vez más cerca de descubrir vida extraterrestre.
El universo es tan extremadamente vasto que sería inverosímil que no existiera otra vida inteligente preguntándose si hay alguien habitando unos cuantos años luz más lejos. El problema es que en lugar de unos cuantos años luz quizá sean miles y tardemos un poquito en ponernos en contacto. Sin embargo, vida simple parecida a las bacterias que conocemos por descontado que debe haberla incluso en nuestra propia galaxia. Los astrobiólogos están cada vez más convencidos de que la vida no es un fenómeno tan complicado como hasta hace un tiempo se pensaba, y el universo debe de estar plagado de ella. Otra cosa es que podamos llegar a percibirla. A pesar de que algunos mantienen una ligera esperanza, no parece que Marte ni ningún otro rincón del sistema solar albergue vida en estos momentos. No obstante, las esperanzas de descubrir vida fuera de la Tierra en algún momento del siglo XXI son cada vez más altas. ¿Cómo puede ser eso? Porque ahora podemos buscarla de manera indirecta.
Imaginemos que una civilización inteligente con telescopios ligeramente mejores que los nuestros fuera capaz de escanear a distancia las características básicas de los principales planetas de nuestro sistema solar. Vería que Marte tiene una gran cantidad de hierro, Venus un efecto invernadero tremendo, Mercurio una atmósfera tenue de potasio y sodio, y cuando observara la Tierra se preguntaría ¿una atmósfera con oxígeno?, ¡eso es imposible! La atmósfera de este planeta es completamente inestable. ¡No tiene ningún sentido tanta presencia de oxígeno! Claro, a no ser que haya algún proceso vivo generándolo. Esa civilización acabaría de descubrir vida fuera de su planeta. Incluso si hubieran mirado a la Tierra mucho antes de nuestra llegada, en cualquier momento desde que hace dos millones de años las cianobacterias oxigenaron la atmósfera, habrían llegado a esa conclusión irrefutable según las leyes de la química.
¿Podremos hacer eso nosotros algún día? Al ritmo que avanzamos, muy pronto.
Descubrir un nuevo planeta extrasolar ya ha dejado de ser noticia. Fue un gran hito en 1995, cuando se descubrió el primero; pero ahora que ya se conocen varios centenares dando vueltas alrededor de estrellas lejanas, ¿qué es lo realmente relevante en ese campo? ¿Cuál es el contexto de las investigaciones? Recuerdo una mañana en Boston en que leí una noticia publicada en Nature sobre el descubrimiento de metano en un planeta extrasolar. Todavía no había escrito en el blog sobre los planetas extrasolares y ésa parecía una buena excusa, pero enseguida me di cuenta de que no sabía muy bien cómo ubicar el estudio: ¿era un gran hallazgo o no? Y si lo era, ¿por qué? En ciencia, cuando una disciplina avanza muy rápido, es difícil seguirle la pista y mantener una idea clara del contexto global en el que se enmarcan las píldoras que nos llegan por los medios de comunicación. El estudio de exoplanetas es algo muy nuevo, donde es fácil perderse. Por eso contacté con Joshua Winn, el principal experto del MIT en el estudio de planetas extrasolares. Nos había impartido un seminario meses antes en el que insistió en que nos atendería encantado si teníamos dudas. Comprobé que lo decía en serio. El café que tomamos duró dos horas.
Empezó resaltando que el principal objetivo de la búsqueda de planetas extrasolares es encontrar pistas en atmósferas lejanas que indiquen existencia de vida, pero había otro objetivo por el que quería empezar a hablar Joshua: entender cómo se forman los sistemas solares, y comprobar si el nuestro era tan extraño como parecía.
Me explico. A partir del único ejemplo de sistema solar que teníamos (el nuestro) se construyó la siguiente teoría: grandes cantidades de materia se acumularon formando un disco giratorio alrededor del Sol En él las partículas se iban agrupando, creando estructuras más grandes. El disco se aceleraba, se producían grandes colisiones y algunas de esas estructuras adquirían una masa crítica que les permitía atraer todavía más materia, hasta acabar convirtiéndose en planetas. Esta explicación concuerda muy bien con el hecho de que los planetas pequeños y rocosos estén cercanos a la estrella, y los gigantes gaseosos estén lejanos. Así es nuestro sistema solar; ningún problema por el momento. Sin embargo, ¡sorpresa! A medida que se han ido descubriendo planetas, un par de detalles no encajan del todo: hay una gran cantidad de planetas gaseosos (estilo Júpiter) en posiciones muy cercanas a su estrella; demasiado cercanas según la teoría del disco giratorio. Y, además, se han observado órbitas exageradamente elípticas. Comparado con lo que estábamos observando, parece como si nuestro sistema solar fuera atípico. ¿Habríamos construido una teoría que explicaba una excepción? No del todo. Según Josh, la teoría básica del disco giratorio es correcta, pero debe haber otros procesos que acerquen los planetas grandes a las estrellas, y que no se habían tenido en cuenta. Él está estudiando posibles colisiones durante la formación de los sistemas solares que, como si fueran canicas, moverían a los planetas de sitio. La «anormalidad» de nuestro sistema solar se debería a que no sufrió esos efectos «extra» a lo largo de su historia. Para Josh, esos nuevos ejemplos de sistemas solares representan una herramienta fantástica para entender mejor la formación planetaria.
Pero, sin duda, la segunda gran pregunta que se quiere responder es saber si alguno de esos planetas alberga vida. Para ello, los astrofísicos analizan la composición de la atmósfera de los planetas. La idea es simple: buscar biomarcadores, elementos que no puedan haberse originado en un mundo inerte. Si en una atmósfera se descubre oxígeno, por ejemplo, indicará que allí hay algo que lo está generando. Se trata de encontrar moléculas «extrañas» en la atmósfera que nos indiquen que allí hay algún tipo de metabolismo. Pero esto no ocurrirá de manera inmediata. De momento, la mayoría de los planetas descubiertos son gigantes gaseosos como Júpiter, y se encuentran demasiado cercanos a su estrella para poder albergar una vida parecida a la que conocemos. Para encontrar planetas más pequeños, y en órbitas más grandes, los telescopios y los métodos de observación deben mejorar un poco. En el camino hacia la búsqueda de vida, el primer gran paso (y que sí merecerá estar en las portadas de los periódicos) será encontrar un planeta rocoso de tamaño máximo diez veces la masa de la Tierra, y situado en la «zona habitable» (lo suficientemente apartado de la estrella como para tener agua líquida). A los científicos no les gusta especular, pero Josh pronostica que el primer planeta de estas características se podría descubrir bastante pronto, en unos cinco años. El siguiente paso será intentar analizar con detalle su atmósfera. Esto requerirá bastante más tiempo, con lo que el descubrimiento de vida extraterrestre no está a la vuelta de la esquina.
Hasta cierto punto, casi más que los propios descubrimientos, en este campo parece más fascinante plantearse cómo diantre se puede detectar un planeta tan lejano cuando hace escasamente cincuenta años parecía del todo inaudito. Vemos fácilmente las estrellas porque emiten luz, pero un planeta es un cuerpo opaco, oscuro, en apariencia invisible para cualquier telescopio. ¿Cómo podemos ver un planeta? La clave está en detectarlo de forma indirecta, midiendo los efectos que ejerce sobre la estrella que orbitan. La principal herramienta es el efecto Doppler: cuando un planeta da vueltas a una estrella, ejerce sobre ella una fuerza de gravedad que la hace oscilar levemente. Es decir, por momentos se acerca un poquito a nosotros y luego se aleja, y esto afecta ligeramente al espectro de luz que recibimos de la estrella. Es un efecto muy sutil, pero sirve para ver si hay una masa invisible dando vueltas en torno a la estrella. Una segunda metodología más simple pero menos efectiva es mirar directamente si en algún momento cambia la intensidad de la luz de la estrella, ya que si un planeta transita por delante de ella afectará a su brillo. La limitación de este método es que sólo permite descubrir planetas muy grandes. Para los mundos más pequeños —y con mayor posibilidad de ser habitables—, existen otros métodos, como el de las micro lentes gravitacionales, que mide distorsiones en la luz procedente de estrellas distantes al pasar junto a objetos masivos.
Y entonces tendremos que analizar su atmósfera. Esto parece todavía más inconcebible. ¿Cómo podemos saber qué gases hay en el aire de un planeta situado a varios años luz de distancia? Su explicación también se basa en las propiedades de la luz, pero en este caso de la que rebota en el planeta y llega a nosotros. Si estuviéramos en el espacio y miráramos a la Tierra, a simple vista podríamos distinguir el océano azul del desierto amarillento, ¿verdad? Esto es porque la luz emitida (rebotada) por el mar tiene unas características, y la emitida por la arena, otras. Por eso vemos diferentes colores. Pero el espectro electromagnético es muchísimo más amplio que el rango de luz visible, y los detectores pueden discernir variaciones infinitamente más precisas que nuestro ojo. Mirando la luz que proviene de un planeta pueden detectar los elementos que lo constituyen, o saber la temperatura a la que se encuentra. Es así como muy pronto encontraremos vida fuera de la Tierra.
Después de tanta divagación, finalmente le pregunté a Josh si la noticia del metano era importante o no. Hizo esa típica mueca en la que se levanta el labio superior y se arruga la nariz, y empezó a ladear la cabeza. Dijo que el descubrimiento en sí no era lo importante. No hay nada inesperado en que una atmósfera tenga metano. Lo relevante era demostrar que técnicamente se podía llegar a medir esa molécula en una atmósfera tan lejana. La metodología era lo trascendente. Y es que los grandes hallazgos vendrán precedidos de mejoras en las técnicas de medición.
Quién sabe cuándo quedará anticuado este texto. La búsqueda de planetas extrasolares es uno de los campos más activos de la astrofísica actual Si vas a un congreso anual de investigación sobre el cáncer, posiblemente no oigas avances revolucionarios respecto al año anterior. En cambio, en ciertas disciplinas, como es el caso de los exoplanetas, las novedades son constantes. En 1995 se encontró el primer planeta extrasolar. Luego empezaron a descubrirse más gigantes gaseosos cercanos a las estrellas, hasta el punto de que dejaron de ser noticia. El siguiente objetivo era encontrar planetas pequeños de tamaño similar a la Tierra. Los métodos mejoraron hasta que en febrero de 2009 se encontró a Corot-7b, un planeta rocoso como el nuestro con la diferencia de que alcanza los 2.000 grados de temperatura por estar muy pegado a su sol. El descubrimiento de Corot merecía de nuevo ser noticia, pero merecerá portada el día que encuentren un planeta de características similares que además esté en una zona habitable. Y significará una revolución si consiguen analizar su atmósfera y descubrir que algo no encaja en ella. Nadie se arriesga a predecir cuándo ocurrirá esto, pero podría convertirse en la noticia más importante del siglo XXI: la confirmación experimental de que los habitantes de la Tierra no estamos solos en el universo.
§4. Qué diantre es la antimateria
Estando con unos amigos en casa de Antonio y en plena sobremesa me preguntaron si yo sabía qué era la antimateria. «Sí, claro: la materia formada por antipartículas», contesté. « ¿Y qué son las antipartículas?», prosiguió mi contertulio. «Partículas como las que conocemos, pero con carga opuesta. Por ejemplo, un antiprotón es un protón con carga negativa». Me detuve al darme cuenta de que en realidad no tenía ni idea de qué diantre era la antimateria…
Por suerte, en el grupo había un físico. Le preguntamos. Tras el típico «No es mi campo» que suelen responder los investigadores que pasan años confinados estudiando un detalle minúsculo de su ya fragmentada disciplina (la mayoría), logramos arrancar la siguiente explicación: «La antimateria es como la materia ordinaria, pero con partículas de carga contraria. Como el positrón, que es un electrón con carga positiva». Y se quedó tan ancho. «Pero ¿¿qué es??, ¿de dónde salen esas partículas?», insistimos. «Ya os he dicho que no era mi campo».
Alguien sacó un iPhone y leyó la entrada de Wikipedia: «La antimateria se compone de antipartículas, de la misma manera que la materia de partículas. Por ejemplo, un antielectrón (electrón con carga positiva) y un antiprotón (protón con carga negativa) podrían formar un átomo de antihidrógeno».
Desesperado, al llegar a casa envié un mail a Gonzalo Merino, físico de partículas que trabaja con el CERN, preguntándole cuándo podíamos charlar por Skype. Fue una de las conversaciones más estimulantes intelectualmente que recuerdo.
Pere: Gonzalo, ¿qué es la antimateria?
Gonzalo: Es la materia hecha de antipartículas.
P: ¡Espera! Ya sé, como el antiprotón y el antielectrón. Pero ¿qué es un antiprotón?, ¿de dónde sale? Yo quiero entenderlo a un nivel fundamental.
G: Pues entonces debemos remontarnos a 1928 y hablar de Paul Dirac. De hecho, es una historia muy bonita. Paul Dirac era un genio, el típico físico teórico que se pone a hacer cálculos y con sus ecuaciones predice la existencia de algo que nadie ha visto antes.
P: ¿La antimateria?
G: Sí, en aquel momento sólo fue una predicción matemática. Su existencia real se observó años después.
P: ¿Como la búsqueda del bosón de Higgs con el LHC, que estáis seguros de su existencia a pesar de no haberlo visto todavía?
G: Exacto, pero lo de Dirac fue mucho más notorio.
P: ¿Cómo «descubrió» la antimateria?
G: Uff… es difícil de explicar. A ver. A principios del siglo XX había varias revoluciones en marcha en el mundo de la física. En 1905 Einstein presentó su teoría de la relatividad especial, que daba lugar a la famosa E = mc2 de las camisetas, según la cual la materia y la energía eran intercambiables. La otra gran revolución era la cuántica de Heisenberg, Bohr y compañía, que describía el comportamiento de las partículas subatómicas. Ambas funcionaban muy bien, pero eran teorías separadas.
Lo que Paul Dirac intentaba hacer era unirlas matemáticamente; crear una mecánica cuántica relativista. En concreto, lo que pretendía era poder describir el electrón, lo más sencillo que uno se podía imaginar. Entonces, al combinar las ecuaciones de la relatividad y la cuántica le apareció la «ecuación de Dirac», cuyo resultado describía el electrón. Pero había algo curioso: la ecuación de Dirac tenía dos soluciones matemáticas, una negativa (que era el electrón de toda la vida) y otra idéntica, totalmente simétrica, pero con carga positiva. Concluyó que si sus ecuaciones eran ciertas, en algún sitio debía de existir una partícula idéntica al electrón pero con carga positiva.
P: ¡Uau!… ¿y más tarde se descubrió?
G: Sí, sí, cuatro o cinco años después de que Dirac lo predijera, se observaron experimentalmente los positrones (electrones positivos) en los rayos cósmicos.
P: …
G: ¡Claro! Y luego se buscaron el resto de antipartículas. Dirac lo hizo para el electrón, pero si las matemáticas establecían que la naturaleza debía respetar esa simetría, para un protón también debía de existir un antiprotón. Y así para toda la materia. Es un postulado.
P: Pero, a ver… yo tengo ante mí un ordenador hecho de átomos, que están constituidos de protones, de quarks, de electrones… ¿aquí hay antipartículas también?
G: No, no. Todo lo que nos rodea es materia, no antimateria Imagino que tú querrías saber dónde están las antipartículas, ¿no?
P: Qué perspicaces sois los científicos…
G: Entonces. Estoooo… ¡¡¡big bang!!!
P: ¿¿¿Big bang???
G: ¡Sí!, big bang.
P: Háblame del big bang.
G: Bien. Tal y como lo conocemos ahora, toooooodo empezó hace 13.700 millones de años, en una concentración de temperatura y densidad infinita. Al principio todo era energía concentrada en un punto. Luego, cuando el universo empezó a expandirse, se fue enfriando, y por E = mc2 cierta energía comenzó a transformarse en materia. Pero, claro, según lo que he comentado de Dirac, en teoría se formaron tanto partículas como antipartículas. Pero, y esto es muy importante, otra cosa que sabemos es que cuando una partícula se encuentra con su antipartícula, ambas se aniquilan y transforman en energía.
P: ¿Y?
G: Vale. Si en el big bang todo hubiera sido absolutamente simétrico, la energía habría generado partículas y antipartículas por igual, que luego se habrían destruido formando más energía hasta llegar a cierto equilibrio térmico, en el que ni nosotros ni nada existiría. Entonces, el hecho de que tengas delante un ordenador hecho sólo de materia nos dice que en el origen del universo hubo algún tipo de asimetría entre materia y antimateria. Es decir, las leyes de la naturaleza contienen alguna asimetría que favoreció a la materia frente a la antimateria. Lo que sabemos ahora es que, a ver que no me equivoque en ningún cero, por cada mil millones de antipartículas se formaron mil millones más una partículas. Estos miles de millones se aniquilaron entre ellos, y las partículas «sueltas» de materia, las desapareadas, son las que empezaron a formar átomos, galaxias, tu ordenador y el mundo tal y como lo conocemos.
P: ¿Y esto sabéis seguro que fue así?
G: Sí, sí, esto fijo, fijo (risas). La prueba experimental viene del fondo de radiación de microondas. Este fondo son los fotones (paquetes de energía pura sin masa) que nos llegan del otro extremo del universo y que se originaron durante la aniquilación de la sopa de partículas y antipartículas. Hoy en día, por cada partícula de materia que vemos en las galaxias, o donde sea, podemos contar mil millones de fotones de energía del fondo de radiación de microondas.
P: Qué te iba a decir, por lo tanto, en principio ahora no queda nada de antimateria.
G: Bueno, la que los físicos creamos.
P: Explícate.
G: Es lo que se hace en el CERN, o en otros laboratorios de partículas. Hoy en día, si juntas suficiente energía en un punto puedes crear materia por la E = mc2.
P: ¡Y antimateria!
G: Claro, en cada colisión del CERN siempre se forman partículas y antipartículas. Las antipartículas se destruyen enseguida cuando chocan con las paredes del detector, pero nos da tiempo de registrarlas para estudiarlas.
P: En Ángeles y demonios iban guardando la antimateria en una cajita para luego crear una bomba.
G: Ya, pero eso es imposible. Confinar antimateria es algo tremendamente complicado, porque se aniquila inmediatamente al encontrarse con cualquier átomo de materia. Se puede conseguir con campos magnéticos, haciendo que no toque nada, pero es dificilísimo. Hay experimentos en el CERN que generan antielectrones y antiprotones, los enfrían hasta prácticamente frenarlos, los mantienen aislados de la materia, y llegan a construir átomos de antihidrógeno.
P: ¿Eso se ha logrado?
G: Sí, se han creado antiátomos de hidrógeno. Con ellos intentan averiguar cosas muy curiosas. Por ejemplo, ¿cómo les afecta la gravedad?, ¿caen hacia arriba o hacia abajo?, ¿existe la gravedad negativa? A priori se deberían comportar igual, pero todavía no hay ninguna comprobación experimental.
P: Alucinante…
G: Sí, son experimentos pequeños pero muy cachondos. El LHC roba toda la atención del CERN, pero hay un montón de grupos pequeños haciendo investigaciones muy fundamentales que podrían generar grandes sorpresas. ¡Imagínate si contrariamente a lo esperado resulta que un antiátomo de hidrógeno sube por la gravedad en lugar de caer!
P: Fantástico. Entonces tener para una bomba de antimateria queda descartado, ¿no?
G: Totalmente. Porque aun suponiendo que se pudiera confinar, si el CERN se hubiera dedicado a guardar antimateria durante sus cincuenta años de historia, como máximo habría generado unos pocos nano gramos. Para fabricar la bomba de Ángeles y demonios se necesitaría como mínimo un gramo. Tardaríamos mil millones de años en reunir esa cantidad. No tiene ningún sentido.
P: Oye, ¿y lo de la PET (tomografía de emisión de positrones?).
G: Exacto. En la vida real también hay antipartículas, y el caso más típico es la PET que encontramos en los hospitales, que utiliza antipartículas para diagnosticar el cáncer.
P: ¿Cómo se generan?
G: Con radiactividad. Hay elementos que son radiactivos por naturaleza y se desintegran siguiendo una reacción nuclear. La PET es eso; te inyectan una sustancia radiactiva que al desintegrarse emite un positrón Ese positrón inmediatamente encuentra un electrón de tu cuerpo y se aniquila generando energía, fotones. Lo que detecta el aparato son esos fotones, y con ellos genera una imagen del interior de tu cuerpo.
P: Qué grande es la antimateria… Gonzalo, eres un crack.
§5. El tamaño de una supernova
Te deslumbran las preciosas imágenes del universo que a menudo vemos en la prensa o los documentales? No te conformes sólo con el gozo estético. Prueba a interpretar la información que contienen, y les añadirás una capa de belleza que te dejará realmente sobrecogido.
En plena visita a la sala de operaciones del telescopio espacial Chandra de Rayos X, su director Claude Canizares nos mostró la preciosa imagen de una supernova captada por dicho telescopio. La primera pregunta que se le ocurrió a mi compañero del MIT John Fahey fue simple « ¿Cuánto mide?». Reconozco que para mis adentros pensé: «Vaya pregunta, John…», pero entonces Claude Canizares respondió: «Varios años luz de diámetro. Nuestro sistema solar entero sería un puntito indistinguible en esta fotografía».
¿¿¿Cómo??? ¿Esa nube de gases consecuencia de la explosión de una estrella tenía, nada más y nada menos, diversos años luz de diámetro? (13 para ser exactos). Nunca hubiera imaginado que pudiera ser tan descomunal De repente me di cuenta de que había estado apreciando la belleza de multitud de imágenes del cosmos, pero mi limitada capacidad para interpretarlas hacía que no pudiera disfrutar del todo de su espectacularidad. Un sinfín de preguntas colapsaron mi mente. ¿Los colores tenían algún significado?, ¿qué veía un telescopio de rayos X, uno óptico y uno de infrarrojos?, ¿qué ventajas y desventajas había entre los telescopios espaciales y los terrestres?, ¿qué imágenes eran más relevantes desde el punto de vista científico?, ¿eran todas reales, o algunas de las que recreaba en mi memoria eran ilustraciones? ¿Qué más me estaba perdiendo por contemplar estas bellas fotografías sin hurgar de verdad en su contenido científico?
Dos días después fui al Harvard-Smithsonian Center for Astrophysics cargado de curiosidad y en busca de respuestas. Allí Megan Watzke me explicó algunos aspectos básicos para poder apreciar mejor la información que contienen las imágenes astronómicas. Comentamos algunas en concreto, y terminó regalándome un póster que habían editado recientemente describiendo las más significativas. Ese mismo fin de semana tuve visita en Cambridge y, en un momento determinado, descubrí a mi par de amigos prendados comentando el póster: «A mí ésta es la que más me gusta», «Qué colores más espectaculares», «Esto parece Marte». El disfrute visual duró unos pocos minutos, pero el intelectual, al rellenar sus lagunas sobre el significado real de lo que estaban viendo, nos llevó casi una hora. Y —parafraseando a Carl Sagan— dejó «sembrada la semilla del asombro», pues cuando meses después nos reencontramos ya en tierras peninsulares, me confirmaron que habían seguido indagando en el asunto. El Premio Nobel y gran divulgador Richard Feynman habría dicho: «Entender los procesos bioquímicos y las leyes físicas que generan el color en una flor no le resta en absoluto ningún atractivo. Todo lo contrario, ¡le añade!». Lo mismo ocurría al observar las imágenes del universo captadas por los telescopios. ¡Qué bonita e interesante es la ciencia!
La primera imagen que comentamos con mis amigos fue justo la mostrada por Claude Canizares: la supernova Cassiopeia A. Pero si os fijáis, seguro que distinguiréis cierta textura más difusa y unos puntos que no aparecían en la fotografía anterior. Esto se debe a que en realidad esta segunda imagen es una composición de fotografías hechas con tres telescopios espaciales: el Chandra de rayos X, el Hubble que captó el fragmento de luz visible, y el Spitzer de infrarrojos. Y cada uno ve una cosa diferente. El tono difuso esparcido por el contorno de la supernova es polvo a unos 10 °C captado por el Spitzer. La imagen original del Hubble está coloreada con tonos amarillentos y corresponde a las estrellas del fondo y a las estructuras filamentosas de gases a 10.000 °C. Las brutales colisiones entre átomos de los gases más calientes (10 millones de grados centígrados) emiten rayos X que son captados por el Chandra, y están representados en la foto por los colores azul y verde. La temperatura es clave. Cuanto más caliente está un objeto, emite radiación a longitudes de onda más energéticas. Nuestros ojos sólo distinguen un pequeño fragmento de toda la luz que recibimos, la que llamamos fracción visible. Por debajo están los infrarrojos, microondas… y por encima los ultravioletas, rayos X, rayos gamma. Con detectores específicos podemos observar estas longitudes de onda y ver fenómenos que no percibiríamos con un telescopio óptico «convencional». Por ejemplo, las supernovas son eventos tremendamente energéticos, que se captan muy bien con el Chandra de rayos X. En cambio, la radiación infrarroja captada por el Spitzer resulta ideal para identificar regiones de gas en las que se están formando planetas y naciendo nuevas estrellas. Poder combinar las imágenes de los diferentes telescopios nos da información mucho más precisa sobre la estructura y evolución de los objetos del universo.
La galaxia del Sombrero está situada a 28 millones de años luz de distancia, y es un buen ejemplo de qué podemos aprender al combinar imágenes. El Chandra (arriba, a la derecha) capta los quasars de fondo y el gas caliente y les asigna un color (en este caso, azul). La imagen del centro (verde) es la luz óptica captada por el Hubble; si la ampliaras, podrías distinguir un borde de materiales en el contorno de la galaxia que bloquean la luz de las estrellas interiores. Ese material se aprecia muy bien con la imagen infrarroja del Spitzer (inferior derecha). Superponiendo las tres imágenes, los científicos pueden entender mejor la composición de la galaxia del Sombrero. Quizá os hayáis percatado de que aquí los astrofísicos han coloreado de verde la imagen óptica, y en la fotografía anterior el mismo color correspondía a los rayos X. El color de las imágenes astronómicas no es completamente arbitrario, los tonos azulados siempre representan energías superiores a los verdes, y éstos superiores a los rojizos. Pero no hay necesariamente una relación de color entre las diferentes fotografías. El objetivo en cada caso es distinguir de la forma más clara lo que se pretende mostrar.

Quizá no se trate de una fotografía tan espectacular, pero esta combinación de imágenes de rayos X nos muestra el centro de nuestra propia galaxia.
Se pueden ver cientos de enanas blancas, estrellas de neutrones y agujeros negros inmersos en una niebla incandescente a muchos millones de grados centígrados.
Según Megan Watzke, en su momento fue muy reveladora porque permitía entender cómo la región central de la Vía Láctea afectaba a la estructura entera, y se podía observar el agujero negro supermasivo en su epicentro, tres millones de veces más pesado que nuestro Sol.
Esta imagen fue la primera gran evidencia visual de la materia oscura. Lo que estáis observando son dos enormes agrupaciones de galaxias en plena colisión, el tipo de evento más energético que puede suceder en el universo después del big bang. El tono más intenso del centro (rosáceo en la fotografía original) es gas caliente detectado por el Chandra de rayos X, y representa el lugar donde se encuentra la materia «normal».

Sin embargo, los astrofísicos utilizaron otra técnica llamada «lentes gravitacionales» para detectar dónde se encontraba la mayor cantidad de materia, y vieron que no coincidía con la imagen del Chandra. Las nubes más exteriores (azuladas) representan dónde los astrónomos perciben que se encuentra en realidad la mayor concentración de materia. La explicación de esta diferencia es que existe mucha más materia oculta de la que podemos observar: una materia oscura que no interactúa con nada y por tanto no emite radiación (no la ve el Chandra), pero sí genera gravedad (la detectan las lentes gravitacionales). La idea básica de las lentes gravitacionales es la siguiente: los científicos miran las estrellas situadas en el fondo de la imagen (con el Hubble, puntos amarillos y anaranjados). En principio ellos saben su posición «teórica» exacta. Si ven que están en un sitio distinto a lo esperado, es que hay «algo» en medio que ha distorsionado la luz que nos llega de ellos. Si este «algo» es invisible, es decir, no lo detectamos de ninguna otra forma, es que se trata de materia oscura.

Al ver la imagen anterior uno de mis amigos me dijo: « ¡Ésta me suena!, pero es un dibujo, ¿no?». Realmente lo parece. Sin embargo, es absolutamente real, y quizá la imagen más famosa del Hubble. Se llama «los pilares de la creación», porque muestra una gigantesca nube de polvo en cuyo contorno se están formando estrellas y sistemas solares completos. Sí he dicho bien; en las puntitas de estas figuras se están creando estrellas y sistemas solares enteros. También es conocida como la nebulosa del Águila, y es la imagen astronómica más reproducida en películas, representaciones artísticas. Tanto, que mucha gente la confunde por una ilustración. Imágenes posteriores con el Chandra de Rayos X y el Spitzer permitieron precisar los lugares donde se estaban creando estrellas, e indicaron que de hecho se estaban creando menos de las que inicialmente se había creído.
En internet podéis encontrar galerías enteras de imágenes astronómicas espectaculares. De planetas, galaxias, agujeros negros, estrellas de neutrones, algunas son más bellas, otras más informativas, pero todas ellas despiertan nuestra curiosidad, la fascinación por el descubrimiento, y nos estimulan a intentar comprender científicamente el universo. Observarlas sin más es como ir a un museo y valorar los cuadros sólo por su belleza estética. Sin duda es un factor importante, pero todas esconden una historia, connotaciones, matices. Saber descifrar la información que contiene la fotografía de una supernova le añade un nivel superior de satisfacción a su contemplación.
§6. ¿Para qué viajar a Marte? El previsible atasco de la carrera espacial
Si antes de llegar al MIT me hubieras preguntado qué opinaba sobre la exploración del espacio con seres humanos, te habría respondido un rotundo « ¡Adelante!». Habría argumentado que conlleva un sinfín de adelantos técnicos, colma nuestras ansias de conocimiento, resulta inspirador, despierta vocaciones científicas entre los jóvenes… en definitiva, que el programa Constelación de la NASA, puesto en marcha en 2004 para enviar humanos de vuelta a la Luna con vistas a plantear un siguiente viaje tripulado a Marte, era una de las apuestas más elogiables del ex presidente George W. Bush. Los beneficios de la exploración humana del espacio justificaban con creces sus elevados costes.
Parecía que empezar una estancia en un centro como el MIT, que participó activamente en los adelantos técnicos que permitieron la llegada del hombre a la Luna, y que continuaba teniendo uno de los departamentos universitarios de ingeniería espacial líderes del mundo, no haría otra cosa que reforzar todavía más esta convicción. Sin embargo, nada más llegar varios episodios hizo que empezara a cuestionarme con mayor detenimiento si realmente merecía tanto la pena el esfuerzo de enviar astronautas a pisar Marte.
Era octubre de 2007 y acudía ilusionado a la presentación de la película documental In the Sado of the Mon. El documental contaba con imágenes inéditas de la llegada del Apolo 11 a la Luna, y reconstruía la carrera espacial de la década de 1960 con entrevistas a ingenieros, astronautas y políticos que protagonizaron esa aventura. Además, en el debate posterior participaron el director de la película, ingenieros del MIT relacionados con la construcción de las naves Apolo, el subdirector de la NASA en el momento del alunizaje, y dos antiguos astronautas. Todos estaban emocionadísimos al recordar el gran hito acontecido en 1969, y se mostraban entusiasmados con el inmenso reto que suponía para nuestra especie alcanzar Marte. Realmente, la ilusión se contagiaba y hacían que te sintieras partícipe del sueño. Te abstraías por un momento, vislumbrabas una futura tripulación saludándonos desde el planeta rojo, y suplicabas que esto ocurriera en algún momento de tu vida.
Un par de semanas después los Night Fellows asistimos a un seminario con David Mindell, director del Departamento de Ciencia, Tecnología y Sociedad del MIT, y que como ingeniero e historiador llevaba tiempo estudiando desde una perspectiva sociológica todas las connotaciones que rodean a la exploración espacial. Sembró dudas: no está tan claro que los beneficios científicos de enviar humanos al espacio sean tan relevantes, y las medidas de seguridad encarecen sobremanera las misiones. Si hablamos de ciencia, es mucho mejor seguir invirtiendo en robots.
Pasaron otras dos semanas y asistí a la conferencia «Cincuenta años en el espacio: reflexiones», que impartía John Logsdon, director del Instituto de Política Espacial de la Universidad George Washington, miembro del consejo asesor de la NASA que hizo posible el programa Constellation, y uno de los más acérrimos defensores de las misiones tripuladas al espacio con fines de exploración. Fue muy claro en su exposición. Para él, la ciencia o las aplicaciones prácticas derivadas de la investigación espacial no son lo realmente importante, sino la maravillosa experiencia que representa para toda la humanidad. Después de haber alunizado seis veces entre 1969 y 1972 y situado a doce astronautas sobre nuestro satélite, la NASA había perdido su rumbo durante las tres décadas siguientes. Sus telescopios, satélites artificiales y misiones robóticas estaban cosechando grandes resultados científicos, pero la misión para la que fue creada esta agencia gubernamental, explorar el espacio, había sido descuidada hasta la ambiciosa apuesta del programa Constellation. «Ha llegado el momento de que Estados Unidos realice los siguientes pasos, y extienda la presencia humana por el sistema solar», anunció George W. Bush durante su presentación en 2004.
Algo empezaba a chirriar, si lo que estaba en juego era el prestigio de Estados Unidos y el afán por explorar nuevos mundos, y el mismo dinero invertido en robots iba a darnos más conocimiento científico, ¿continuaba siendo la exploración tripulada algo tan loable? Recuerdo haber planteado esas mismas dudas a mi compañero John Mangels, que como periodista cubría desde hacía más de veinte años temáticas relacionadas con el espacio. « ¡Tú no habías nacido en el 69! —respondió convencidísimo—, fue uno de los momentos más fabulosos del siglo XX. Todo el mundo siguió expectante la llegada del hombre a la Luna. No puedes comparar el impacto social de que Marte sea pisado por un robot o por un ser humano. Debemos seguir con la exploración espacial». Qué difícil, necesitaba más opiniones para terminar de formarme la mía.
Un lunes, al terminar la clase de ciencia, tecnología y sociedad con David Mindell, me acerqué y le pregunté sin rodeos: «David, si tú fueras el único responsable de definir el programa espacial de la NASA, no te digo dentro de cincuenta o cien años, sino ahora, ¿enviarías humanos a la Luna de nuevo?». David Mindell tomó aire, y respondió: «No».
Mis dudas se hacían cada vez más serias. En septiembre de 2007 un agresivo artículo de The Economist, en el que revisaban los últimos cincuenta años de exploración espacial desde que en 1957 la Unión Soviética enviara su primer satélite Sputnik, decía textualmente: «Una escandalosa cantidad de dinero se ha malgastado con la presunción de que viajar por el cosmos es el futuro de la humanidad».
Pensándolo bien, la crítica tenía mucho sentido. El planteamiento de que «tarde o temprano la especie humana deberá abandonar este planeta» era tan absurdo a corto plazo como lo era a largo plazo el de «para qué gastar dinero en esto habiendo problemas más graves aquí en la Tierra». Los argumentos inteligentes se debían situar en algún punto intermedio. Aunque, puesto a decidir entre ambos, un año atrás hubiera defendido el primero, en esos momentos me sentía más próximo del segundo.
Y en un caso como éste las opiniones son muy importantes. John Mangels intuye que la mayoría de los estadounidenses aprueban que con dinero de sus impuestos se financie la conquista del espacio para satisfacer nuestra naturaleza exploradora. En Europa es diferente, y por eso pisar la Luna no entra en los planes de la ESA. En China no preguntan, y quizá por ello serán los próximos en pasear por nuestro satélite.
Cotilleos científicos en la nasa: necesitamos más dinero
Dejé aparcado el debate durante un tiempo. Al fin y al cabo, la decisión de la NASA de intentar viajar de nuevo a la Luna en 2020 ya se había tomado, y el programa Constellation estaba diseñando el cohete Ares y la cápsula Orión que iban a hacerlo posible.
Todo parecía seguir su curso. Pero cuando en junio de 2008 asistí al simposio «Forjando el futuro de la ciencia espacial: los próximos cincuenta años», en la sede de la Academia Nacional de Ciencias de Estados Unidos en Washington D. C., me di cuenta de que internamente había unos claroscuros muy considerables. La frase inicial en la presentación del director del Consejo de Estudios Espaciales, Lennar Fisk, fue: «Actualmente, la única certeza en la NASA es la incertidumbre».
Se refería, cómo no, a temas económicos. La NASA tenía un presupuesto anual de 17.000 millones de dólares, que se repartía básicamente entre la división de ciencia y la de exploración. El problema era que para cumplir los objetivos del programa Constelación se requerían muchísimos más millones de los que había asignado Bush. Y hasta saber qué presupuestos destinaría el futuro presidente de la Casa Blanca, de momento no cabía más que ir robando recursos de investigación científica en astrofísica, ciencias planetarias, astrobiología, y pasarlos a exploración. Evidentemente, muchos no estaban de acuerdo. El chismorreo era patente, y en conversaciones de pasillo voces importantes de la NASA consideraban que el programa para viajar a Marte había sido un error, y era preferible dar marcha atrás cuanto antes. Alan Stern, el ex jefe de la división científica de la NASA, ya había dimitido un par de meses atrás por discrepancias con las líneas y recortes en investigación básica seguidos por la agencia gubernamental. Si a todo esto le añadías que ir a la Luna requería inyectar una cantidad de dinero extra realmente considerable, el embrollo adquiría tintes casi cómicos. Entre quienes defendían que el conocimiento científico no era suficiente y que si se eliminaba el sueño de poner un humano en Marte la NASA perdería gran parte de su razón de existir, un ponente argumentaba que la exploración con robots todavía tenía trabas: «Un geólogo en Marte sería muchísimo más versátil que un robot», expresó, provocando la réplica inmediata y descarada de otro asistente: « ¿Tú sabes cuánto cuesta enviar un geólogo a Marte de manera segura y traerlo de vuelta? Eso no va a suceder».
Los más críticos con la exploración humana proponían un verdadero «cambio de rumbo» en la NASA. Le pedían que se olvidara de proyectos faraónicos como ir a Marte y ampliara horizontes científicos; que utilizara su sólida estructura y el indudable talento de sus científicos para profundizar en las investigaciones sobre el cambio climático, las nuevas energías, la aeronáutica civil y comercial, e incluso la tecnología militar.
La versión oficial, y lo que aparecía en los periódicos, era que los planes continuaban. Pero el cotilleo científico y el tono de algunas declaraciones hicieron que ya en julio de 2008, antes de la crisis económica y de saber quién residiría en la Casa Blanca, yo dejara textualmente escrito en el blog de El País: «Me atrevo a pronosticar que el próximo presidente de Estados Unidos dirá: “Tranquilos, que a Marte iremos, pero tardaremos un poco más de lo planeado. De momento, lo paramos”». Es exactamente lo que sucedió dieciocho meses después.
Obama y el fin de la carrera espacial: por lógica, no por la crisis
Barack Obama nunca mostró gran interés por enviar humanos al espacio. En su precampaña anunció que retiraría fondos del programa de exploración espacial para dedicarlos a la educación. Más tarde, al constatar sorprendido que esta intención recibía más críticas que elogios, rectificó y prometió que Estados Unidos liderara al mundo con un proyecto de exploración que incorporara humanos y robots. Pero en ninguno de sus discursos, incluso siendo ya presidente, se mostró decidido a mantener los planes de Bush. Más bien intentaba esquivar el asunto de cualquier manera. No lo mencionó ni de refilón en abril de 2009 durante el principal discurso en materia científica de su legislatura, pronunciado en la Academia Nacional de Ciencias. Sí dijo sin embargo: «El momento Sputnik de nuestra generación es romper nuestra dependencia de los combustibles fósiles». También fue muy significativo el sospechoso silencio que mantuvo en julio de 2009 en plena celebración del cuadragésimo aniversario de la llegada del hombre a la Luna. Hubiera sido el momento ideal para anunciar sus planes, pero no dijo ni mu. Reconozco que me parecía perfecto. Mi posición se estaba confirmando: no había motivos que justificaran enviar humanos de nuevo a la Luna o a Marte.
Asistí a un evento de dicho cuadragésimo aniversario organizado en la sede central de la NASA en Washington D. C., junto a siete de los doce astronautas que habían pisado la Luna con las misiones Apollo. Resultó obvio cuáles eran los motivos últimos de la conquista del espacio. Ni recoger materiales lunares como el helio-3, candidato a ser utilizado en fusión nuclear, ni poner telescopios en la cara oculta de la Luna para evitar las interferencias de la atmósfera terrestre, justificaban un viaje tripulado. Y estaba claro que en pocos años los robots dejarían de ser más limitados para ciertas tareas que el cuerpo humano. Las mejoras tecnológicas derivadas del proyecto no justificaban poner en tal riesgo a los astronautas, y en todo caso serían menores que si el mismo dinero se aplicaba directamente y sin rodeos a la innovación Había dudas de si el efecto inspirador que se logró en 1969 se iba a repetir en una sociedad donde la presencia física era cada vez menos importante. Incluso la búsqueda de nuevos territorios es parte de nuestros genes» está en entredicho; la ilusión intrínseca de nuestra especie por explorar nuevos mundos es uno de los argumentos más fuertes para los defensores, y más absurdos para los detractores. Además, volver a la Luna no tenía ningún aliciente si no era como preparación a un siguiente viaje a Marte. Nadie ocultaba que los principales motivos que le quedaban a Obama para asignar un dineral en mantener el plan Constellation eran los siguientes: afán explorador, orgullo nacional y liderazgo internacional. Estos tres eran los principales objetivos de los viajes tripulados. Las otras ventajas eran secundarias.
A mí, la carrera espacial ya no me motivaba en absoluto. Por lo menos tal y como estaba planteada. Estados Unidos, China, Rusia, la India y Japón estaban gastando dinero público en paralelo, «compitiendo» para plantar su banderita y sacar pecho a la antigua usanza. Era ofensivo. Si el principal motivo para enviar humanos a explorar el espacio era la tan codiciada inspiración social, y que la humanidad lograra una nueva gran hazaña, perfecto. Hagámoslo. Pero todos juntos en una misión internacional que aunara esfuerzos y representara no sólo a un país, sino a todos los pueblos del mundo. Se podían ahorrar su orgullo nacional y el miedo a dejar de ser los líderes en todo; sonaba a capricho caduco.
Pasó lo que todo el mundo esperaba: en enero de 2010 Obama frenó el programa Constellation. El presidente anunció que debían continuar utilizando la Estación Espacial Internacional, diseñar mejores vehículos e ir a Marte cuando realmente estuvieran preparados y pudieran hacerlo sin poner en tanto riesgo las vidas de los astronautas. La crisis económica fue una excusa ideal utilizada por el gobierno de Estados Unidos y recogida por la prensa como el motivo de la cancelación de los planes para ir a la Luna. Tras haber seguido con atención lo ocurrido durante los dos años y medio antes de que se tomara esa decisión, opino que no ha sido la crisis económica sino la lógica lo que ha frenado —que no detenido— la futura expansión humana por el espacio.
En las próximas décadas volveremos a la Luna, y seguro que algún día un representante de la humanidad alcanzará la superficie de Marte, dejando esa fecha e imágenes selladas como uno de los más grandes hitos de la historia. Continúo confiando en poder vivirlo, pero sin que la misión viaje acompañada de banderitas. Ahora imagínate que ambas monedas poseen esta peculiar propiedad: van alternando cara y cruz a su aire, pero nunca están ambas en la misma posición. Forman parte de un mismo orbital atómico y, por algo llamado principio de exclusión de Pauli, siempre que una esté en cara, la otra marcará cruz Si giro una, la otra se girará automáticamente a la posición opuesta. Espera, no te vayas, continúa leyendo, merecerá la pena, lo prometo. Te voy a explicar uno de los fenómenos más inverosímiles de la naturaleza.
Estábamos con esas monedas-electrones que van cambiando constantemente entre cara y cruz, pero que de alguna manera están entrelazadas: según las leyes de la cuántica, nunca pueden estar ambas en cara o en cruz a la vez. Es físicamente imposible.
Imaginemos un poco más: coges con delicadeza ambas monedas-electrones, las metes en sendas cajitas sin mirar todavía qué marca cada una, y sin romper su entrelazamiento cuántico te las llevas una a Nueva York y la otra a Bangkok. ¿Qué tendrás entonces? Dos monedas, una en Nueva York y la otra en Bangkok, que en teoría van pasando de una posición a otra, pero continúan conectadas entre sí. Si en un momento determinado abres la caja de Nueva York y ves la moneda en cruz, la de Bangkok se paraliza de golpe en cara. Y si hubieras abierto la misma caja unos milisegundos más tarde y te hubiese salido cara, la otra se habría colapsado en cruz inmediatamente (recalquemos el inmediatamente). Esto, en teoría cuántica. En la práctica, ¿creéis que esto podría llegar a suceder?
Vayamos ahora a ese apasionante primer tercio del siglo XX, en el que la relatividad de Einstein y la mecánica cuántica competían para ver la que explicaba mejor la realidad del mundo que nos contiene.
Einstein no se tragaba algunas de las asunciones de la cuántica, sobre todo ese principio de Indeterminación de un tal Heisenberg, según el cual en el mundo subatómico no había certezas y resultaba físicamente imposible conocer la posición y el movimiento exactos de una partícula en un instante determinado. O esas atroces ecuaciones de su estrambótico colega Schrödinger, implicando que las partículas estaban dispersas en varios lugares a la vez y su estado sólo quedaba definido en el momento que alguien las observaba. « ¡Claro que debían estar definidas en todo momento aunque nosotros no fuéramos capaces de medirlas! —pensaba Einstein—, y si la cuántica tenía Indeterminaciones, debía de ser porque todavía no estaba desarrollada del todo». Para demostrarlo, en 1935 Einstein propuso junto con Podolsky y Rosen el experimento mental EPR (por las siglas de sus nombres), que reflejaba una situación análoga a las cajitas con monedas cara y cruz separadas por miles de kilómetros de distancia.
En resumidas cuentas, lo que venía a decir Einstein era que si al abrir la caja de Nueva York ves la moneda en cara, y de golpe la de Bangkok aparece en cruz, será que, ¡siempre habían sido cara y cruz respectivamente! ¿Qué historia era ésa de que las partículas van cambiando de estado y comunicándose misteriosamente? Si al abrir la caja te hubiera salido cruz, pues esa moneda contenía la propiedad cruz; y la otra cara. Y punto. ¿Por qué lo tenía tan claro Einstein? Porque si era de otra manera se rompía un principio fundamental de las leyes de la naturaleza: «Si con la paradoja EPR coges dos partículas entrelazadas cuánticamente y te llevas una al otro extremo del sistema solar, físicos cuánticos locos, ¿me estáis diciendo que al observar una colapso inmediatamente la otra? ¡Imposible! pero ¿no os dais cuenta de que esto es una barbaridad?». Este inmediatamente rompe con el principio relativista de que nada puede viajar más rápido que la luz. Ni siquiera la información. « ¿O acaso tenéis alguna explicación coherente para el experimento EPR?», planteaba Einstein. En realidad, no la tenían. A lo único que podían aferrarse Bohr y otros físicos cuánticos era a sus ecuaciones matemáticas. La lógica en este caso estaba de parte de Einstein: si le dices a un tipo en Bangkok que abra una caja y ve una moneda en cruz, no le hagas creer que segundos antes era cara. Bueno… eso quizá podría ser, pero lo que no cuela de ninguna manera es que otra moneda en Nueva York vaya cambiando simultáneamente con la primera.
El planteamiento de Einstein es lógico, ¿no? ¡Ja! ¡¡¡Muerte a la lógica!!! ¡Que le den al sentido común! ¡¡¡Viva la ciencia!!! Por muy inverosímil que os parezca, ¡¡¡los físicos cuánticos tenían razón!!! Einstein andaba equivocado, y se hubiera comido su paradoja EPR si hubiera vivido más tiempo.
En 1964 el irlandés John Bell publicó un teorema que escondía un posible experimento para poner a prueba la paradoja EPR, y comprobar si la información podía viajar de manera inmediata entre dos partículas entrelazadas cuánticamente. En el fondo, Bell construyó su teorema pensando que terminaría dando la razón a Einstein, y probaría que dos partículas no podían estar correlacionadas hasta el grado que aseguraba la cuántica, pero nunca llegó a realizar el experimento definitivo. Fue en 1982 cuando sí pudo llevarlo a cabo el francés Alain Aspect. ¿Y sabéis qué? ¡Exacto! Contrariamente a lo que Bell y Einstein suponían, cuando por fin se pudo realizar el experimento EPR, quedó demostrado que dos fotones entrelazados cuánticamente sí podían comunicarse sus propiedades de manera instantánea a pesar de estar separados largas distancias. La paradoja EPR dio la razón a la cuántica, demostrando de nuevo que la realidad es más insólita de lo que podemos llegar a imaginar: si tienes dos electrones entrelazados, uno en Nueva York y el otro en Bangkok, y al mirar a uno ves que es cara (spin-up,) el otro inmediatamente será cruz (spin-down). Y si te hubieras esperado unos instantes y hubiese salido cruz, el otro sería cara. ¡Fantástico!
¡Ah!, y no hay truco. Esto se ha corroborado en muchísimas otras ocasiones.
Si os sentís incrédulos, perplejos, pensáis que algo no encaja, o creéis que no habéis terminado de entender el fenómeno en profundidad, no os preocupéis, a una gran parte de los físicos también les ocurre.
Quizá por eso, mientras unos intentan aprovechar las propiedades de este misterioso entrelazamiento cuántico en criptografía, computación cuántica, o teletransportación, otros nos quedamos simplemente ensimismados con las fabulosas elucubraciones filosóficas que sugiere sobre la estructura de la naturaleza, fascinados con las viejas y nuevas historias, y expectantes ante qué nuevas sorpresas nos irá deparando esta maravilla que es la comprensión científica del mundo.
§7. Qué diantre es un entrelazamiento cuántico
Imagínate un par de electrones como si fueran si fueran dos monedas idénticas, una marcando cara y la otra marcando cruz.

Ahora imagínate que ambas monedas poseen esta peculiar propiedad: van alternando cara y cruz a su aire, pero nunca están ambas en la misma posición. Forman parte de un mismo orbital atómico y, por algo llamado principio de exclusión de Pauli, siempre que una esté en cara, la otra marcará cruz Si giro una, la otra se girará automáticamente a la posición opuesta. Espera, no te vayas, continúa leyendo, merecerá la pena, lo prometo. Te voy a explicar uno de los fenómenos más inverosímiles de la naturaleza.
Estábamos con esas monedas-electrones que van cambiando constantemente entre cara y cruz, pero que de alguna manera están entrelazadas: según las leyes de la cuántica, nunca pueden estar ambas en cara o en cruz a la vez Es físicamente imposible.
Imaginemos un poco más: coges con delicadeza ambas monedas-electrones, las metes en sendas cajitas sin mirar todavía qué marca cada una, y sin romper su entrelazamiento cuántico te las llevas una a Nueva York y la otra a Bangkok. ¿Qué tendrás entonces? Dos monedas, una en Nueva York y la otra en Bangkok, que en teoría van pasando de una posición a otra, pero continúan conectadas entre sí Si en un momento determinado abres la caja de Nueva York y ves la moneda en cruz, la de Bangkok se paraliza de golpe en cara. Y si hubieras abierto la misma caja unos milisegundos más tarde y te hubiese salido cara, la otra se habría colapsado en cruz inmediatamente (recalquemos el inmediatamente). Esto, en teoría cuántica. En la práctica, ¿creéis que esto podría llegar a suceder?
Vayamos ahora a ese apasionante primer tercio del siglo XX, en el que la relatividad de Einstein y la mecánica cuántica competían para ver la que explicaba mejor la realidad del mundo que nos contiene.
Einstein no se tragaba algunas de las asunciones de la cuántica, sobre todo ese principio de Metermimción de un tal Heisenberg, según el cual en el mundo subatómico no había certezas y resultaba físicamente imposible conocer la posición y el movimiento exactos de una partícula en un instante determinado. O esas atroces ecuaciones de su estrambótico colega Schrödinger, implicando que las partículas estaban dispersas en varios lugares a la vez y su estado sólo quedaba definido en el momento que alguien las observaba. « ¡Claro que debían estar definidas en todo momento aunque nosotros no fuéramos capaces de medirlas! —pensaba Einstein—, y si la cuántica tenía Determinaciones, debía de ser porque todavía no estaba desarrollada del todo». Para demostrarlo, en 1935 Einstein propuso junto con Podolsky y Rosen el experimento mental EPR (por las siglas de sus nombres), que reflejaba una situación análoga a las cajitas con monedas cara y cruz separadas por miles de kilómetros de distancia.
En resumidas cuentas, lo que venía a decir Einstein era que si al abrir la caja de Nueva York ves la moneda en cara, y de golpe la de Bangkok aparece en cruz, será que, ¡siempre habían sido cara y cruz respectivamente! ¿Qué historia era ésa de que las partículas van cambiando de estado y comunicándose misteriosamente? Si al abrir la caja te hubiera salido cruz, pues esa moneda contenía la propiedad cruz; y la otra cara. Y punto. ¿Por qué lo tenía tan claro Einstein? Porque si era de otra manera se rompía un principio fundamental de las leyes de la naturaleza: «Si con la paradoja EPR coges dos partículas entrelazadas cuánticamente y te llevas una al otro extremo del sistema solar, físicos cuánticos locos, ¿me estáis diciendo que al observar una colapso inmediatamente la otra? ¡Imposible! pero ¿no os dais cuenta de que esto es una barbaridad?». Este inmediatamente rompe con el principio relativista de que nada puede viajar más rápido que la luz. Ni siquiera la información. « ¿O acaso tenéis alguna explicación coherente para el experimento EPR?», planteaba Einstein. En realidad, no la tenían. A lo único que podían aferrarse Bohr y otros físicos cuánticos era a sus ecuaciones matemáticas. La lógica en este caso estaba de parte de Einstein: si le dices a un tipo en Bangkok que abra una caja y ve una moneda en cruz, no le hagas creer que segundos antes era cara. Bueno… eso quizá podría ser, pero lo que no cuela de ninguna manera es que otra moneda en Nueva York vaya cambiando simultáneamente con la primera.
El planteamiento de Einstein es lógico, ¿no? ¡Ja! ¡¡¡Muerte a la lógica!!! ¡Que le den al sentido común! ¡¡¡Viva la ciencia!!! Por muy inverosímil que os parezca, ¡¡¡los físicos cuánticos tenían razón!!! Einstein andaba equivocado, y se hubiera comido su paradoja EPR si hubiera vivido más tiempo.
En 1964 el irlandés John Bell publicó un teorema que escondía un posible experimento para poner a prueba la paradoja EPR, y comprobar si la información podía viajar de manera inmediata entre dos partículas entrelazadas cuánticamente. En el fondo, Bell construyó su teorema pensando que terminaría dando la razón a Einstein, y probaría que dos partículas no podían estar correlacionadas hasta el grado que aseguraba la cuántica, pero nunca llegó a realizar el experimento definitivo. Fue en 1982 cuando sí pudo llevarlo a cabo el francés Alain Aspect. ¿Y sabéis qué? ¡Exacto! Contrariamente a lo que Bell y Einstein suponían, cuando por fin se pudo realizar el experimento EPR, quedó demostrado que dos fotones entrelazados cuánticamente sí podían comunicarse sus propiedades de manera instantánea a pesar de estar separados largas distancias. La paradoja EPR dio la razón a la cuántica, demostrando de nuevo que la realidad es más insólita de lo que podemos llegar a imaginar: si tienes dos electrones entrelazados, uno en Nueva York y el otro en Bangkok, y al mirar a uno ves que es cara (spin-up), el otro inmediatamente será cruz (spin-down). Y si te hubieras esperado unos instantes y hubiese salido cruz, el otro sería cara. ¡Fantástico!
¡Ah!, y no hay truco. Esto se ha corroborado en muchísimas otras ocasiones.
Si os sentís incrédulos, perplejos, pensáis que algo no encaja, o creéis que no habéis terminado de entender el fenómeno en profundidad, no os preocupéis, a una gran parte de los físicos también les ocurre.
Quizá por eso, mientras unos intentan aprovechar las propiedades de este misterioso entrelazamiento cuántico en criptografía, computación cuántica, o teletransportación, otros nos quedamos simplemente ensimismados con las fabulosas elucubraciones filosóficas que sugiere sobre la estructura de la naturaleza, fascinados con las viejas y nuevas historias, y expectantes ante qué nuevas sorpresas nos irá deparando esta maravilla que es la comprensión científica del mundo.
§8. Supercuerdas, agujeros negros, gravedad cuántica y el misterio de las dimensiones ocultas
Una de las discusiones más profundas en el mundo de la física entre teóricos, físicos de partículas, cosmólogos, cuánticos es, ¡¿por qué hay menos mujeres en esta profesión?! De los muchos e importantes factores que pueden influir en esta gran preocupación (para ellos), tuve la oportunidad de muestrear uno de los menos relevantes cuando Ivan Semeniijk nos envió un mail a los diez Knight Fellows del MIT preguntando si queríamos acompañarle a una cita privada con un físico teórico de Harvard interesantísimo, para hablar de gravedad cuántica, teoría de cuerdas, dimensiones ocultas, supersimetría y agujeros negros. Acudimos los cinco chicos, y ninguna de las cinco chicas. Estaba reflexionando sobre si —por algún motivo— ya desde un principio a las mujeres les interesaba menos la física teórica que a los hombres, hasta que de golpe, en cuanto empezó la conversación, el físico Nima Arkani-Hamed dijo: «A mí en realidad no me importan las partículas subatómicas con nombres estúpidos. Me da igual si algo está hecho de mesones K o Q. Eso de los ladrillos que constituyen la materia me deja indiferente, porque es como el alfabeto. A mí lo que realmente me interesa son las leyes que rigen la naturaleza. No es que las partículas no sean importantes, pero lo de verdad cautivador es la historia que nos cuenta, la novela. Eso es lo apasionante, y lo que queremos averiguar».
Su provocación nos introdujo de inmediato en la conversación, y no exagero al decir que viajamos por el mundo más inverosímil que os podáis imaginar.
Empecemos enfocando el problema fundamental que científicos como Nima Arkani-Hamed quieren resolver: qué diantre es algo tan corriente como la gravedad. Me explico. La relatividad general de Einstein define la gravedad como una deformación del espacio, y sus ecuaciones predicen con absoluta exactitud el movimiento de todos los cuerpos que puedas observar. Su precisión es impresionante. Sin embargo, cuando nos enfrentamos a un electrón orbitando dentro en un átomo, ahí la relatividad se pierde. Sus fórmulas matemáticas son incapaces de definir qué le ocurre a ese electrón, por qué no pierde energía y cómo es que no termina cayendo encima del núcleo. Estos enigmas, sin embargo, los explica con un grado de detalle exquisito la mecánica cuántica, quizá la teoría científica más corroborada que existe. Pero la física cuántica también sufre un grave problema: ni siquiera ha oído hablar de la fuerza de la gravedad. Como no la necesita para describir con exactitud cómo funciona el mundo subatómico, para ella es como si no existiera. Y claro, cuando utiliza sus ecuaciones cuánticas para intentar predecir algún sistema macroscópico que sí se ve afectado por la gravedad, falla estrepitosamente. Quizá estés pensando: « ¿Dónde está el problema? Si tan bien funcionan por separado, utilizad relatividad o cuántica cuando os convenga y sanseacabó». De hecho, es lo que se está haciendo; pero los físicos son caprichosos y no soportan tener que describir el mundo con dos paquetes de ecuaciones tan diferentes e incompatibles, aunque sean tremendamente exitosas por separado. Quieren una única teoría del todo. Cierto que a nivel práctico no es un gran problema, porque cuando algo es tan pequeño que se rige por las leyes de la cuántica los efectos de la gravedad son despreciables, y a la inversa. Pero esto no resulta intelectualmente satisfactorio. Y, además, hay excepciones. La más conocida son los agujeros negros, el paradigma de sistema que muestra efectos cuánticos y gravitacionales al mismo tiempo.
En realidad, el concepto de agujero negro es muy sencillo: según la relatividad general, se trata de una concentración de masa tan grande que deforma el espacio de manera extrema y se traga todo lo que pasa por allí. No deja escapar nada, ni siquiera la luz Sin embargo, en 1974 Stephen Hawking estableció que, debido a efectos cuánticos y al principio de Indeterminación, en la parte más exterior de los agujeros negros (lo que llaman horizonte), deben tener una temperatura mínima y emitir al exterior cierto tipo de radiación. Los científicos, en efecto, saben que esto ocurre así, pero no logran explicarlo matemáticamente. Para entender y poder caracterizar por completo un agujero negro deberían combinar las ecuaciones de la teoría de la relatividad y las de la mecánica cuántica. Y no encajan de ninguna manera.
¿Solución al «problema»? Aceptar que ambas teorías son incompletas, no se pueden unir, y buscar unas ecuaciones radicalmente nuevas que describan al mismo tiempo el mundo subatómico y la gravedad; una teoría de la gravedad cuántica. Fácil, ¿no? Bueno, ése fue el sueño de Einstein, y es lo que los físicos llevan buscando desde hace décadas. Pero el primer candidato firme no llegó hasta la década de 1960: la teoría de cuerdas.
Esta controvertida teoría que para algunos es física, para muchos matemáticas y para otros una pérdida de tiempo, parte de la base de que las partículas elementales que ves como un punto en un espacio de tres dimensiones en realidad son minúsculas líneas que se extienden por otras dimensiones que no puedes percibir. Imagínate que dejas un zapato encima de la acera, te alejas 200 metros de él, y al primero que pase por tu lado le preguntas: «¿Qué es ese bulto que ves allí?». Te dirá que no lo sabe, que lo único que ve es un punto oscuro. Os aproximáis un poco y le vuelves a preguntar, pero continúa viendo algo indescifrable. Sólo a medida que se acerque lo suficiente conseguirá finalmente distinguir la forma del zapato. Algo parecido ocurre cuando observamos partículas subatómicas como neutrones o protones. Para nosotros son puntos, pero algunos científicos creen que si lográramos acercarnos lo suficiente veríamos que en realidad están constituidos por cuerdecitas diminutas vibrando dentro de unas dimensiones extra invisibles. Pero no es sólo cuestión de forma externa; la manera en que estas cuerdas vibran dentro del espacio multidimensional es lo que las convierte en un electrón, un quark, un gluón, o cualquier otra partícula. Incluso, según los teóricos, uno de los modos de vibración fundamentales de las cuerdas es el de una partícula que sería la transmisora de la fuerza de la gravedad, y cuyas ecuaciones trasladadas a sistemas macroscópicos terminarían correspondiendo con las de la relatividad general de Einstein. Aquí aparece la tan ansiada fusión entre el mundo macroscópico y el nanoscópico.
Con todo este embrollo, al final los físicos de cuerdas han sido capaces de construir unas ecuaciones matemáticas que describen tanto a las partículas subatómicas como a la gravedad. Y la verdad, les cuadran bastante bien. Desde la década de 1970 las han estado puliendo, creando diferentes versiones de la teoría, y logrando describir con ellas una considerable serie de fenómenos físicos. Pero hay un par de problemillas; uno que concierne a los científicos, y otro que mosquea al resto de los mortales. Empecemos por el segundo: las ecuaciones de la teoría de cuerdas implican que a nivel microscópico existen otras dimensiones aparte de las arriba-abajo, izquierda-derecha y delante-detrás a las que estamos acostumbrados. Claro, esto parece una locura y desafía al sentido común: « ¿Nos estáis diciendo que vivimos en un universo lleno de dimensiones invisibles?», le preguntaríamos a un matemático de cuerdas, a lo que él respondería: «Bueno, sí, pero no te asustes; once como máximo. Y algunos modelos sólo prevén cinco». Tranquilo nos deja, pero el tipo continúa: « ¡Ah! Se me olvidaba un pequeño detalle: también existen universos paralelos. Cada uno en una membrana del espacio a las que llamamos branas, no me mires así, no lo digo yo. Lo dice la teoría M». Complicado, muy complicado. Suena increíble. Pero una manera de plantearlo es: ¿y por qué no? Al fin y al cabo la ciencia nos ha sorprendido en muchas otras ocasiones. Obvio, pero ante esto alguien también puede responder: ¿y por qué sí? Hasta que un tercero se harta y pone el dedo en la llaga: ¿tenéis alguna prueba? Entonces los físicos de cuerdas agachan la cabeza y confiesan el primer problemilla que mencionábamos: después de cuatro décadas de trabajo, no tienen ninguna prueba experimental que la demuestre. Tragan saliva ante las miradas inquisidoras. Pero enseguida recuperan de nuevo su bravura y replican que tampoco tenía pruebas Einstein cuando predijo matemáticamente que la gravedad no era una fuerza, sino una consecuencia de la deformación del espacio causada por la masa de los objetos. A pesar de que todos los indicios matemáticos decían que Einstein tenía razón, muchos se escudaban en el sentido común para asegurar que su teoría no tenía sentido físico alguno. No fue hasta 1919 cuando se pudo demostrar experimentalmente su relatividad general, aprovechando el eclipse más famoso de la historia. Los expertos en teoría de cuerdas se encuentran en una situación parecida; su formalismo matemático hace muy buenas predicciones, ha conseguido diversos éxitos en el campo de la física teórica, y es la única teoría conocida que reconcilia la cuántica con la gravedad. Y muchos están plenamente convencidos de la existencia de dimensiones ocultas a nivel microscópico, pero por el momento no hay un experimento que pueda probar su existencia real en el mundo físico.
Esto puede cambiar cuando el gran colisionador de hadrones (LHC) permita rastrear regiones del espacio extremadamente diminutas en que se puedan encontrar indicios de la existencia de otras dimensiones. En concreto, Lisa Randall, de Harvard, nos explicó durante una charla su sueño de hallar unas partículas llamadas Kaluza Klein que viajan entre esas dimensiones extras y significarían la prueba experimental de estas dimensiones ocultas. Nadie se atreve a predecir cuándo seremos capaces de comprobar qué partes de la teoría de cuerdas son ciertas y cuáles no. Quizá termine siendo una teoría de nada. Pero algunos estamos convencidos de que el siglo XXI nos regalará una revolución en nuestra concepción del cosmos, de mayor escala incluso que la protagonizada por Einstein. No me sorprendería en absoluto si un día los periódicos anunciaran la existencia de dimensiones ocultas y posibles universos paralelos.
Nima Arkani-Hamed tenía razón; el camino hacia encontrar una teoría del todo que describa el espacio que nos contiene, y en un solo modelo matemático relacione las cuatro fuerzas fundamentales (interacción fuerte, débil, electromagnetismo y gravedad) con todos los constituyentes de la materia, es una de las novelas más apasionantes que se puedan contar.
Capítulo IV
El sumiller científico
§1. Huevos para adelgazar: ¿creer al médico o al investigador?
§2. Acupuntura: ¿tienes alma de escéptico, médico o científico?
§3. Science y Nature acusadas de distorsionar la ciencia
§4. Los científicos también mienten
§5. Aprovechar la investigación básica: asignatura pendiente
§6. Los límites de la epidemiología
§7. Machismo inconsciente en la ciencia
§8. Animales de laboratorio en el metro
§9. Cuando la ciencia y Dios se buscan
§10. Creacionismo absurdo
§11. Liberados de los genes: Darwin no explica el amo
§12. Patentes: investigar para curar o para enriquecer
Adoro la ciencia. Es una fuente continua de novedades, nos aporta infinidad de beneficios, y dejarte llevar mentalmente por sus fascinantes parajes resulta muy estimulante. Pero cuando algo te apasiona, también te vuelves más quisquilloso. No es una contradicción. Imagina a ese experto en vinos que disfruta como nadie con los caldos de calidad, pero que considera horrendo un vino que nosotros catalogaríamos de aceptable. Varias veces durante mi periplo científico en Boston me sentí una especie de sumiller científico, deleitándome desmesuradamente en ocasiones, pero siendo cada vez más meticuloso con ciertas investigaciones que no me convencían o amenazaban esa supuesta integridad de la ciencia. Considerar la ciencia como un proceso popperiano casi perfecto constituido por una etapa libre de generación de hipótesis, seguida de una experimentación rigurosa para ponerlas a prueba y un análisis objetivo de los resultados que desemboque en unas conclusiones imparciales, es fijarse sólo en una parte muy restringida del método científico. Como cualquier otra actividad humana, la ciencia está influida por nuestras propias imperfecciones y por la sociedad que la contiene. El científico suele hacerse un tipo de preguntas dentro del laboratorio, y el sociólogo de la ciencia otras de carácter mucho más crítico sobre el entorno humano, social, ético y político que lo rodea. Por eso, y porque lo contrario al amor no es el odio sino la indiferencia, también hay momentos en los que toca ser un poco crítico con tus amigos más cercanos.
§1. Huevos para adelgazar: ¿creer al médico o al investigador?
Cuando un investigador consigue unos resultados que le parecen novedosos escribe un artículo científico. En él redacta una introducción, describe la metodología de los experimentos que ha realizado, presenta de manera muy clara los resultados obtenidos, y plantea unas conclusiones. Le añade la bibliografía de referencia, un resumen conciso al inicio del texto, los nombres de todos lo que participaron en el estudio, y lo envía a una revista científica de referencia para solicitar que sea publicado. Si al editor no le encaja, puede descartar el artículo directamente. Pero si le gusta, lo distribuye a una serie de expertos en ese campo de investigación que, de forma anónima, darán su opinión acerca del trabajo. Estos referees pueden vetar el artículo a la primera de cambio, pero lo normal es que pidan correcciones, más experimentos, aclaraciones. Entonces el editor se lo comunica al autor, que regresará al laboratorio para completar los datos o experimentos solicitados. Cuando los tiene, vuelve a enviar el artículo al editor, y éste a los referees. Si todavía no quedan satisfechos, el ciclo empieza de nuevo. Pero si dan su visto bueno, la revista acepta el artículo y lo prepara para su publicación. Este estricto sistema de revisión es el que en principio avala que la investigación publicada es rigurosa y merece ser compartida con toda la comunidad de investigadores que quieran consultarla.
Si además la revista científica considera que el nuevo descubrimiento también puede ser interesante para el gran público, distribuye notas de prensa anunciándolo. Eurekalert es uno de los servicios que las aglutina y envía por mail a los periodistas científicos dos o tres días antes de que sean publicadas. Estas noticias están «embargadas»; eso significa que el periodista puede documentarse, preparar el artículo, hacer entrevistas… pero tiene prohibido darlas a conocer hasta un día y hora determinado. La verdad es que las notas de prensa presentan el tema muy bien mascadito. Si os habéis preguntado por qué ciertas investigaciones atemporales aparecen el mismo día en varios medios a la vez y planteadas de forma tan similar, éste es el motivo.
Yo consulto los titulares de Eurekalert cada mañana cuando llegan a mi correo. Es una buena forma de ir siguiendo la actualidad, y siempre encuentras algún estudio que te llama la atención. Por ejemplo, me dejó intrigadísimo una nota de prensa diciendo que «desayunar dos huevos cada día ayuda a perder peso». En la investigación publicada por científicos estadounidenses en agosto de 2008, se comparó un grupo de personas cuyo desayuno incluía dos huevos al día y otro que ingería la misma cantidad de calorías comiendo una especie de bollos de pan que en Estados Unidos llaman bagels

Salgo del vagón y me encuentro de frente con un cartel de la asociación protectora de animales Personas por la Ética en el Trato de los Animales (PETA), quejándose de los mataderos, las cadenas de fast food, y los experimentos en laboratorios.
Continúo caminando, y a escasos 20 metros aparece un cartel de otra asociación llamada Centro para la Libertad del Consumidor, en el que leo: «Ratas de laboratorio contra niños enfermos: ¿sabes que PETA está utilizando tu contribución para boicotear la investigación contra el sida y el cáncer de mama, sólo porque utilizan animales de laboratorio?». Curioso. No hago mucho caso, pero me giro y en el andén de enfrente veo un nuevo anuncio de PETA resaltando una frase de su directora Ingrid Newkirk: «Aunque la investigación con animales conduzca a la cura del sida, estaremos en contra de ella». Reacción inmediata: « ¡Eso es pasarse!». Normalmente, cuando asistes como espectador a un debate en el que no tienes una idea bien formada, te posicionas inicialmente en el medio y vas dejándote influir por los argumentos de los dos bandos que polemizan. Es como si estuvieras atado a una cuerda elástica, de cuyos extremos unos y otros van tirando con fuerza para intentar desplazarte todo lo posible hacia su posición. Pero a veces ocurre algo contraproducente: si una de las partes se excede y esgrime un argumento claramente desmesurado, tensa demasiado la cuerda elástica, ésta se rompe y te abalanzas de golpe hacia su opositor. Algo así sentí cuando leí la frase de la directora de PETA; me hizo perder mucha confianza en su organización.
Apoyo incondicional a todo lo que suponga humanizarnos, procurar un trato más ético a los animales, avanzar siempre hacia más derechos en lugar de menos, y denunciar atrocidades que sin duda todavía se están realizando. Pero ¿incondicional?, ¿a todo? Mujer, tampoco nos excedamos. Puede ser loable plantarle cara a la industria peletera, a las innecesarias torturas con productos cosméticos, y promover el mejor trato posible a las condiciones de vida de cualquier animal; pero pretender vetar de cuajo la experimentación animal en biomedicina es intolerable. Si la directora de una organización realmente promueve algo tan radical, quizá sí pierda un poco de credibilidad.
Lo primero que hago al llegar a casa es comprobar si, efectivamente, ha dicho esa frase y no está sacada de contexto. Parece que sí la pronunció, junto con otras sentencias del mismo estilo. Lo segundo es visitar las webs de PETA y la asociación Consumer Freedom. La cosa se complica. Me da la impresión de que el contenido de la segunda es mucho más dudoso, manipulado y extremista que el de la primera. Algo me dice que la realidad se sitúa en algún punto intermedio entre ambos planteamientos, y debería regresar a una posición más ecuánime. Sí a la experimentación animal, pero con precauciones, y sin dar la espalda a las barbaridades que en ocasiones ha conllevado.
Sin alejarnos de las áreas científicas, una de las prácticas más denunciadas son las clásicas pruebas de cosméticos o detergentes como el test de Draize, en el que aplican dosis altísimas del producto a un ojo de un conejo para compararlo con el otro. O experimentos en los que se les hacen ingerir sustancias nocivas para analizar su efecto. En muchos de esos casos dichas pruebas son reemplazables y, de hecho, varias compañías lo han hecho sin disminuir la seguridad de sus productos ni los beneficios de sus ventas. Ante una crema anti arrugas etiquetada como «no experimentamos con animales» y otra convencional, muchísimas mujeres escogerían la primera aunque fuera un par de euros más cara. Las presiones de los activistas en ese campo están justificadas. Otro tema más peliagudo es la investigación biomédica y el desarrollo de fármacos más eficaces y seguros. Ahí en la gran mayoría de los casos la experimentación animal resulta todavía difícil de sustituir. No es un debate fácil, pues claramente hay un conflicto moral entre el rechazo al sufrimiento de unos animales y la mejora en la calidad de vida de otros. La ética se encarga de atajar estos juicios morales, dictando que debemos reducir al máximo posible el dolor y el número de los animales que se utilizan en los laboratorios. Eliminarlo resulta utópico y contraproducente por el momento.
Tú también decapitarías ratas
Si nunca has trabajado en un laboratorio quizá estés pensando: ¿no tienen remordimientos estos desalmados científicos que sacrifican ratas?
Durante mis tiempos de aprendiz de científico, en unas prácticas de la licenciatura de bioquímica nos tocó decapitar ratas in vivo para conseguir gran cantidad de sangre sin que un proceso de muerte lenta afectara a ciertos niveles de proteínas y metabolitos.
Las cogíamos con firmeza, metíamos su cabeza en una guillotina, y ¡flup!, la cortábamos de cuajo. Luego inclinábamos el cuerpo decapitado en un vaso de precipitados, recogíamos la sangre chorreando de su cuello, estrujábamos un poco con las manos para que saliera el máximo posible, y nos apresurábamos a extraer el hígado y congelarlo inmediatamente en nitrógeno líquido. Yo no soy un desalmado insensible; al contrario, siento empatía por los animales y abogo por evitar su padecimiento inútil, pero confieso que en aquel momento no me daba la sensación de estar haciendo nada atroz, ni siquiera injustificado. Ahora me doy cuenta de que estaba siendo víctima de algo parecido al experimento de Stanley Milgram sobre la obediencia a la autoridad, y que me atrevo a sugerir afecta a un gran número de investigadores. El experimento de Milgram fue uno de los más impactantes en la historia de la psicología, al demostrar que personas normales que participaban en un estudio eran capaces de infligir dolor a otras simplemente porque el protocolo lo exigía. Si buscas en internet las grabaciones de este experimento, verás como un investigador recibe a dos voluntarios y les explica que la tarea de uno será contestar un test, y la del otro suministrarle pequeñas descargas eléctricas inofensivas cada vez que se equivoque. Ambos aceptan, y empieza el experimento. Hay un problema: la intensidad de las descargas es un poco mayor a cada error, y al cabo de varios minutos el voluntario que las recibe empieza a quejarse. El voluntario que las suministra consulta varias veces al director del experimento qué hacer, y éste siempre le pide que continúe. Lo hace hasta extremos inverosímiles. Evidentemente, el voluntario que grita de dolor es un actor que no recibe descarga eléctrica alguna, pero el otro esto no lo sabe. Resulta impresionante comprobar hasta qué límites las personas normales son capaces de provocar dolor a otros voluntarios inocentes, a pesar de oír sus reiterados lamentos y signos de desfallecimiento, dejándose llevar sólo por las exigencias del procedimiento y la autoridad del director. Todos pensamos que nosotros seríamos incapaces de llegar a los límites del experimento de Milgram, pero los inesperados resultados demostraron lo contrario, provocando un enorme revuelo y convirtiendo este experimento en uno de los más famosos del siglo XX.
Te podría ocurrir algo parecido si trabajaras en un laboratorio. Yo conocía bien a una investigadora del Instituto Nacional del Cáncer de Estados Unidos que inyectaba células tumorales en los ratones, dejaba que crecieran los tumores, luego suministraba fármacos sólo a algunos, y comprobaba si evolucionaban de manera diferente respecto a los controles. Un día le pregunté cuántos ratones utilizaba al año. «Yo sólo unos ciento cincuenta», contestó. « ¿Sólo?». «Sí, no es mucho. Una compañera mía en estos momentos dispone de unos ochocientos exclusivamente para sus experimentos. Mi laboratorio se gasta el 15 por ciento de su presupuesto en ratones. Mucha gente utiliza más de mil cada año». «Utiliza». Creedme que dicha investigadora es una persona sensible, le encanta la naturaleza, y siente un enorme respeto por los animales. Pero, de nuevo, no tiene ni el más mínimo conflicto interior a la hora de trabajar con ratones. Considera que son imprescindibles como modelos de enfermedades. ¿Siempre? Ésta es también una de las cajas negras que a los científicos les cuesta horrores abrir.
Modelos animales inservibles
Un artículo publicado en agosto de 2008 en Nature pone el dedo en la llaga: la mayoría de los fármacos contra enfermedades neurodegenerativas como la esclerosis y el Alzheimer, que han funcionado en ratones, no tienen ni el más mínimo efecto en los estudios preliminares con humanos. Esto está más que observado. Hay dos tipos de explicaciones, y ambas son radicales por diferentes motivos. La primera es la más obvia: el modelo no sirve; el cerebro de ratón es demasiado diferente al del humano, y lo que han estado haciendo miles de científicos no lleva a ningún sitio. Parece preocupante, pero la segunda explicación también se las trae: muchos experimentos publicados en revistas científicas están mal hechos. A veces, las muestras son demasiado pequeñas y no están diseñadas con suficiente rigor. La presión por publicar induce a vacíos metodológicos, quizá alguna que otra distorsión de los resultados, y hacer oídos sordos a las diferencias básicas entre ratones y humanos respecto a las características fisiológicas de la enfermedad. Además, los resultados negativos no se publican. A la que rascamos un poco, no dejan de aparecer las imperfecciones humanas que le contagiamos a la ciencia.
Una de las conclusiones del estudio era que para ciertas enfermedades o estudios sobre el cerebro sería mucho más conveniente eliminar tanto estudio superfluo con ratones y buscar modelos animales con monos, incluso primates. Aunque mucho más caros y conflictivos éticamente, a la larga serían eficientes. Entramos en terreno pantanoso…
Los neurocientíficos contraatacan: ¿estás preparado para ver animales de laboratorio?
Recuerdo llegar una mañana de marzo de 2009 a mi oficina en el Departamento de Comunicación de los Institutos Nacionales de la Salud de Estados Unidos y encontrar a todos mis compañeros alterados, comentando las imágenes que habían visto la noche anterior en televisión: miembros de la Humane Society habían pasado nueve meses infiltrados en unos laboratorios de Luisiana grabando las terribles condiciones a las que eran expuestos chimpancés y otros primates. Se distinguían animales enloquecidos, autolesionándose, enjaulados y con heridas abiertas, siendo tratados violentamente por algunos cuidadores, y sometidos a experimentos que parecían muy dolorosos. Evidentemente, la institución se defendió diciendo que las imágenes estaban sacadas de contexto. No cabía duda alguna de ello, pero tampoco de que no en todos los sitios se cumplen las normas éticas de cuidado de los animales. El asunto aún resultaba más complejo porque el centro recibía ayudas del gobierno federal: 37 millones de dólares de los NIH, según su propia web. De inmediato se detuvo la actividad y se inició una investigación para descubrir la realidad de las irregularidades de ese centro, pero el daño ya estaba hecho. Por muchos progresos que se estuvieran logrando en las normas de protección de los animales, la difusión de esas imágenes fue un duro varapalo. Mostraba el margen de mejora que todavía queda por recorrer, pero, según los científicos, también transmitía a la opinión pública una visión completamente alejada de la realidad que se vive en los laboratorios de los países desarrollados, donde se siguen unas normativas éticas muy estrictas. De hecho, la comunidad científica empieza a estar harta de tanto ataque.
« ¿Has padecido alguna vez lepra? Gracias a la investigación con animales, nunca lo harás». Éste es el mensaje en un cartel que vi en Boston de la campaña Research Saves, cuyo objetivo era concienciar a la población estadounidense sobre la necesidad de la experimentación animal en biomedicina.
En Estados Unidos sólo el 52 por ciento de los ciudadanos se declaran a favor de utilizar animales en la investigación científica, posiblemente por las persistentes campañas de asociaciones como PETA o Human Society, que se oponen a cualquier tipo de investigación animal diciendo que sus resultados no se pueden trasladar a humanos y, aunque así fuera, no resulta ético matar un animal para salvar una vida humana.
Lo segundo puede ser discutible, pero lo primero rotundamente falso, y los científicos están empezando a contraatacar activamente con campañas como la de Research Saves. Pero ésta es la versión light y educativa que exponen al público. En realidad, están muy indignados y en sus discusiones internas se muestran cada vez más agresivos contra las asociaciones protectoras de animales. Empiezan a pensar que la mejor defensa es un buen ataque.
Un editorial publicado a mediados de 2009 en la prestigiosa revista Journal of Neuroscience decía textualmente: «Los activistas por los derechos de los animales engañan a la gente». Y añadía: «Sus tácticas son vergonzosas, ilegales e inmorales, y han sido etiquetadas de terrorismo por el gobierno de Estados Unidos»

No exageremos. Ellas mismas reconocían que la información obtenida todavía no iba a ser demasiado relevante como diagnóstico médico. De ciertas enfermedades sólo analizaban alguno de los muchos factores genéticos que todavía faltaban por conocer, y sus clientes más bien debían considerarlo un divertimento o simple curiosidad. Sin embargo, algunos invitados parecían tomárselo más en serio, y el artículo recogía frases como: «Si mi marido tuviera un gen que hiciera peligrar seriamente a mi hijo en el parto quizá adoptaríamos», «Quiero averiguar por qué tengo pecas», o «En principio no dejaría a un novio aunque descubriera que no somos compatibles genéticamente, pero depende de lo que salga». Entre los asistentes había quienes ya se habían sometido con anterioridad a un test genético de la compañía e iban promulgando: ««Me hizo extremadamente feliz saber que tenía pocas posibilidades de padecer obesidad», o ««Me tranquilizó averiguar que un gen asociado a la enfermedad cardiovascular venía de mi madre, que tiene noventa y nueve años; porque mi padre murió a los sesenta y siete de un ataque cardíaco».
No consideres muy lejanas estas expresiones, porque dentro de muy poco tú mismo podrías estar repitiéndolas. De hecho, la tarifa de 23andMe por esos análisis era de unos muy asequibles 399 dólares, y pocos meses después, otras compañías ya estaban ofreciendo precios más competitivos y con mayor número de datos obtenidos a partir del ADN. No te extrañes si algún día alguien te regala por tu cumpleaños un test genético, o la posibilidad de secuenciar tu genoma completo.
Si algo reflejaba la fiesta del análisis de ADN, es que la tan ansiada era de la medicina personalizada estaba acercándose sigilosamente. Ese viaje en autobús me hizo recordar y constatar las palabras pronunciadas unos meses atrás por el prestigioso genetista Eric Lander en el MIT, cuando frente a un auditorio repleto dispuesto a escuchar la historia de su vinculación al Proyecto Genoma Humano, nos dijo: «El futuro ya ha llegado».
Cuando en junio de 2000 Francis Collins y Craig Venter anunciaron junto a Bill Clinton la primera secuenciación del genoma humano, advirtieron que en esos momentos su valor todavía era más simbólico que práctico. Los genetistas tenían en sus manos un libro extensísimo escrito en un código que cada vez conocían mejor, pero «ahora toca leerlo y encontrar el sentido de las frases», decían. Ya se conocían bastantes mutaciones genéticas específicas que causaban por sí solas enfermedades como la fibrosis quística o la enfermedad de Huntington. Pero caracterizar todas las variaciones relacionadas con trastornos que dependían de múltiples genes como la diabetes, los cánceres o las cardiopatías era una tarea lenta, muy lenta. Primero debían identificar genes asociados a características físicas o procesos metabólicos, luego ver si esos genes eran idénticos en todas las personas o si entre la población habían distribuidas versiones del mismo gen con pequeños cambios, y por fin comprobar si dichos cambios influían de manera significativa en su correcto funcionamiento. Llegar a caracterizar todos los genes relacionados con nuestras características físicas y poder establecer un riesgo genético fiable para enfermedades comunes parecía una empresa titánica. Todavía lo es. Pero como en muchas otras ocasiones en ciencia, la llegada de una herramienta tecnológica poderosísima ha acelerado exponencialmente el proceso.
Eric Lander fue así de entusiasta y contundente: «En 1997 se diseñó el primer chip para leer el ADN capaz de analizar si un gen específico tenía una mutación determinada o no. En 2001 apareció un nuevo chip que identificaba diez posibles mutaciones a la vez En 2002 ya conseguían analizar 1.000 posiciones; en 2004, 50.000; en 2006, 500.000, y en 2007 se llegó a un millón de polimorfismos genéticos individuales detectados en un único chip. ¡Esto, en manos de los investigadores, abre unas posibilidades de muestreo enormes!».
Con estos chips genéticos era mucho más sencillo agrupar personas con características diferentes, rastrear sus genomas de forma más exhaustiva, y comprobar si existía alguna mutación claramente asociada a un grupo de pacientes determinado. Los chips de ADN han multiplicado la capacidad de los científicos de interpretar la información genética, y los resultados no se han hecho esperar.
«Vayamos al grano —dijo Lander durante su presentación—. Olvidémonos de detalles superficiales como la altura, la apetencia por el sabor amargo, el color del pelo, o las enfermedades genéticas que sean minoritarias y ya sepamos identificar con otros métodos más específicos y directos. Hablemos directamente de cuántos polimorfismos genéticos individuales relacionados con enfermedades comunes como la diabetes, el infarto de miocardio, el glaucoma, el cáncer, se han descubierto en los últimos años». La tabla que nos mostró fue impresionante: en 2000 se identificó uno (asociado a la diabetes); en 2001, dos (de la enfermedad de Crohn); otro en 2002; uno en 2003; uno en 2004; cuatro en 2005; ocho en 2006; pero, de repente, entre enero y septiembre de 2007 se llevaban confirmados nada más y nada menos que 57 nuevos polimorfismos genéticos asociados a enfermedades comunes como cánceres de pecho, colon y próstata, diabetes I y II, obesidad, infarto de miocardio, artritis reumatoide, esclerosis múltiple, asma, y el ritmo se estaba acelerando exponencialmente. Todo eso gracias a los chips genéticos. El 2007 fue el annus mirabilis de la genética humana. El futuro había llegado. Una vez localizadas tantas mutaciones asociadas a patologías, por fin empezaba a tener sentido diseñar un nuevo tipo de chips para detectar fácilmente si uno las poseía o no. Y eso empezaron a hacer empresas privadas como 23andMe, DeCode, o Navigenetics.
Cautela era la palabra que repetían los genetistas más serios. Aunque, efectivamente, la progresión estaba siendo espectacular, todavía faltaba mucho genoma por leer y piezas que encajar para tener una visión sensata de nuestra salud a través del ADN. Además, los chips utilizados por las empresas privadas contaban con bastantes limitaciones. Una muy importante era que sólo medían mutaciones individuales o SNP (Single Nucleotide Polymorphisms), y hay muchas más formas en que un gen puede estar alterado y conducir a un mal funcionamiento. Pero, sobre todo, la restricción fundamental era —y continúa siéndolo— entender que la mayoría de nuestras características físicas o enfermedades habituales no dependen de un único gen, sino de muchos a la vez Conocemos algunas variaciones genéticas asociadas al infarto de miocardio, pero seguro que existen muchas más no descubiertas todavía. La lectura del genoma será un proceso continuo que probablemente no terminará nunca, y esto nos conduce a la visión futurista con que abría este texto. Secuenciar el primer genoma humano completo costó 3.000 millones de dólares; el de James Watson «sólo» un millón; Craig Venter secuenció de nuevo el suyo por 300.000 dólares; y se convocó el Premio X de 10 millones de dólares al primer equipo que fuera capaz de secuenciar cien genomas humanos en diez días por menos de 10.000 dólares cada uno. Visitando un laboratorio del MIT en mayo de 2008, me mostraron el secuenciador que les había llegado la semana anterior diciendo: «Hace en dos semanas lo que todo el Proyecto Genoma Humano hizo en tres años y con un equipo de centenares de investigadores». Quién sabe cuánto costará secuenciar tu genoma cuando leas estas líneas, pero sin duda podrás permitírtelo. En junio de 2010 tuve la oportunidad de entrevistar personalmente a Francis Collins con motivo del décimo aniversario de la presentación del primer borrador del genoma humano. La frase que más me impactó fue: «Me sorprendería mucho que dentro de diez años, tú y yo —o cualquiera que tenga acceso al sistema sanitario— no tuviéramos nuestro genoma secuenciado. Los beneficios de conocer esta información serán enormes, y el coste se está desplomando». Quedan grandes retos científicos, técnicos, sociales y éticos que afrontar para poder sacar el máximo partido a dicha información. Pero, sin duda, se acerca el día en que el genoma formará parte de nuestro historial médico, estará informatizado, y se irá actualizando a medida que los científicos vayan descubriendo más asociaciones a enfermedades, características físicas, habilidades mentales o incluso predisposición a ciertos comportamientos: «Su colesterol es de 278, la presión sanguínea ligeramente alta, sobrepeso, no fumador, nivel de azúcar correcto, predisposición genética 62 por ciento por encima de la media», podría decirte tu médico.
Respecto a la predisposición genética y la prevención, tampoco tengas grandes expectativas. Salvo pocos errores fatales que condicionan fuertemente a ciertas enfermedades, como el BRCA 1 y 2 para el cáncer de mama y otros, la suerte genética quedará repartida. Me refiero a que los científicos están descubriendo tantísimos genes implicados en características comunes que en raras ocasiones la lotería genética te habrá castigado con todas las mutaciones dañinas, o premiado con una protección excepcional para evitarlas. En realidad, todos somos muy iguales, de la misma manera que poca gente sobrepasa los dos metros de altura o se queda en el metro cincuenta. Conocerás en mayor detalle tus riesgos, qué fármacos son los mejores para ti, y a qué aspectos de tu salud debes prestarles más atención. Pero en casos normales, el dato genético podrá quedarse en una simple línea más, y tu destino será decidido por cómo trates a tu cuerpo o elijas utilizar tu cerebro.
Otra historia es cuando tu organismo empiece a funcionar mal. Ahí, sin embargo, la información genética sí podría salvarte la vida. Veamos un ejemplo concreto de esto último, que no es tremendamente relevante, pero sí muy ilustrativo: en enero de 2010 científicos de los Institutos Nacionales de la Salud descubrieron que uno de los cánceres cerebrales más comunes, el glioblastoma, podía estar causado por cuatro mutaciones genéticas diferentes. Hasta el momento, como los tumores del glioblastoma siempre tenían la misma apariencia clínica, los médicos lo habían considerado un único tipo de cáncer. Pero ahora veían que a nivel molecular, había cuatro subtipos. Y lo más importante, cada subtipo reaccionaba de manera diferente a la quimioterapia y otros tratamientos. Es ahí donde aparece la revolución. Las terapias específicas no son nuevas en absoluto, pero la dimensión que está adquiriendo conocer a fondo el perfil genético de ciertas enfermedades, especialmente el cáncer, hace que por fin podamos asegurar que la expansión de la tan ansiada medicina personalizada está a la vuelta de la esquina. O «ya estamos inmersos en ella», como asegura Francis Collins al recordarnos que la implantación no llegará de un día para otro, sino que será un progresivo goteo de conocimientos y aplicaciones concretas que cambiarán poco a poco la manera de afrontar enfermedades.
«Tómese este fármaco específico y en esta cantidad ajustada a su perfil genético», te dirá el médico dentro de muy poco tiempo. O «Este producto para la calvicie es el que mejor funciona para una mutación como la tuya», te aconsejará el esteticista genético.
Insisto en lo de muy poco tiempo. Tener tu genoma secuenciado será rutinario en menos de una década. No puede ser de otra manera. El precio de hacerlo se está reduciendo a un ritmo impensable hace unos pocos años, inversamente proporcional a la cantidad de valiosísima información que de él podemos obtener. Los progresos en investigación básica están siendo incluso más rápidos de lo que imaginaban los científicos. Ahora falta el dificilísimo reto de trasladarlo a la práctica médica, pero el punto de inflexión ha llegado: ya hay suficiente masa crítica de conocimiento en genética humana para plantearse aplicarlo a gran escala, e integrarlo definitivamente al cuidado cotidiano de nuestra salud.
Una medicina preventiva específica y adaptar fármacos a nuestros genes estropeados será el primer paso. No está tan cerca, pero cada vez menos lejos, el momento en que podamos llegar a repararlos y evitar transmitirlos a nuestros hijos.
§2. Seleccionar genes: Gattaca y la nueva eugenesia
Sitúate ahora en un futuro no tan lejano: tienes secuenciado tu genoma, y sabes que una mutación concreta te da altas posibilidades de sufrir un tipo de cáncer determinado. Consciente de ello, haces controles regulares y sigues unas normas específicas de prevención. Si algún día descubres que tus células empiezan a dividirse y crecer incontroladas, el médico sabrá qué tratamiento se adecua mejor a tu perfil genético y te ofrece mayores opciones de curación Todo «correcto». Pero entonces llega el momento en que deseas tener un hijo; ¿qué haces?, ¿te la juegas y dejas su destino al azar, o coges un puñado de espermatozoides de tu pareja, fecundas con ellos unos cuantos de tus óvulos, esperas a que empiecen a multiplicarse hasta formar una pelotita de células, sacas una de estas células, miras su ADN, e implantas en tu útero un par de los embriones que no tengan la mutación genética que predispone al cáncer? De hecho, en enfermedades que dependen de un único gen defectuoso y la enfermedad está un ciento por ciento garantizada, como la de Huntington, este diagnóstico preimplantacional lleva realizándose desde hace más de una década. Y tiene todo el sentido del mundo; si todos los portadores de Huntington optaran por la fecundación in vitro acompañada del diagnóstico preimplantacional, y no se produjeran embarazos no deseados, con el tiempo esta enfermedad podría desaparecer de los hospitales. Quedaría erradicada. Siempre habrá embarazos no previstos de personas con la enfermedad de Huntington, cuyos efectos no se manifiestan hasta bien entrada la vida adulta y permiten dejar antes descendencia sin problema, pero sin duda la prevalencia en la población de esta patología irá decreciendo con el tiempo.
Pero regresemos a tu caso futurista, donde tu mutación no garantiza que vayas a sufrir un cáncer, sólo aumenta la posibilidad. ¿También aquí es ética la selección de embriones? No hace falta que lo pienses mucho; no es una situación futurista en absoluto. En 2009 se aprobó en España la ley que permite hacerlo en portadores del gen BRCA 1 y 2, fuertemente asociados al cáncer de mama y al de ovarios. Deja de lado los porcentajes. Ya da igual si el riesgo de cáncer de pecho que evitas es un 80 por ciento, o un 60 por ciento; el camino queda libre para que el diagnóstico preimplantacional se extienda hasta límites que, sin llegar a ellos, te recordarán a la película Gattaca. Por mucho estupor que pueda generar, cuando sepas las carencias de tu genoma, no querrás transmitirlas a tus hijos. ¿Hay algún inconveniente en ello? Eso es lo que abordaron en Harvard el científico Douglas Melton y el filósofo Michael Sandel en una sesión de bioética repleta de jóvenes estudiantes.
Lo primero que se hizo fue pasar la famosa escena de Gattaca donde un médico muestra a una pareja imágenes de sus embriones, les dice que ya ha eliminado varias enfermedades, la miopía y la calvicie, y les pregunta qué sexo, color de ojos, o tono de piel prefieren. Ante las muestras de perplejidad de los padres, insiste: «No lo olviden, este hijo es como ustedes; simplemente lleva lo mejor de ustedes». Lo segundo fue la pregunta directísima que Sandel le hizo a Melton: « ¿Cuán cerca estamos de esta situación?». La respuesta tampoco se anduvo con rodeos: «En el color de ojos, por ejemplo, hay como mínimo siete genes implicados. Esto lo hace complicado. Además, no despierta ningún interés, por lo que no lo veo cercano ni necesario. En el caso de las enfermedades es diferente. Sí que tiene sentido evitar genes que predispongan a ciertas patologías. Y no será complicado hacerlo».
Sandel continuó: « ¿Qué opinión te merece un escenario como el de la película? ¿Te sientes receloso, estimulado, cauto?». Douglas volvió a ser contundente: «Si nos centramos sólo en las enfermedades, me parece algo tremendamente excitante. Debemos trabajar en esa dirección».
Este último punto condujo a un apasionante debate, que tarde o temprano mantendrás con familiares o amigos. Las voces más favorables a la selección genética opinan que cuando sea posible corregir deficiencias en una etapa embrionaria, no sólo será permisible hacerlo, sino que los padres estarán obligados moralmente a proveer a sus futuros hijos con la mejor salud posible. Argumentan que no hay una diferencia sustancial entre las medidas que ahora tomamos para mejorar la salud y la educación de los hijos después de haber nacido, y las que genéticamente podremos tomar en el futuro antes de su nacimiento. Para los que están en contra, estas tecnologías representan una amenaza a la igualdad, a la posible falta de libertad, a actitudes de dominio por parte de los padres, y enseguida se menciona una de las palabras más odiadas: eugenesia. La eugenesia, entendida como las medias encaminadas al perfeccionamiento de la especie humana, ha conllevado a lo largo de la historia normas estrictas de apareamiento, esterilizaciones e incluso exterminios. Esta eugenesia coactiva genera repudio. Pero aquí estamos frente a una eugenesia liberal de características totalmente diferentes; ¿hay motivos para oponerse a los esfuerzos voluntarios para mejorar la dotación genética de los futuros seres humanos?
Sí, los hay. Pero no te esfuerces; cuando sea posible, muchos padres que puedan pagarlo lo harán, por el simple motivo de querer ofrecer el mejor futuro posible a sus hijos.
Pero ¿superaremos la línea de la enfermedad hasta adentrarnos en una cosmética genética? Douglas Melton mostró la fotografía de un toro cuyo tejido muscular crecía de manera desmesurada debido a una mutación específica en la pareja de genes que regulan la miostatina (un factor de crecimiento). Luego una imagen con las piernas exageradamente desarrolladas de Mr. Universe Junior, un niño con esas mismas mutaciones y cuya madre es una esprínter profesional. Según Melton, algunos culturistas podrían poseer dichas mutaciones sin saberlo. Y si se quisiera, no sería imposible reproducirlas de manera «artificial». Es sólo un ejemplo, pero pone de manifiesto que a medida que avancemos en la interpretación del contenido de nuestro genoma, encontraremos formas de mejorarlo. Las líneas entre terapia y mejora, entre salud y cosmética, son a veces difusas. Los científicos están convencidos de que su obligación es investigar para poder aplicar la manipulación genética a la prevención de enfermedades. Pero otros sin duda aprovecharán este conocimiento para ir más lejos y llevarnos a una nueva eugenesia, que podría conducirnos a una sociedad injusta, llena de desigualdades, y con un mermado sentido de la responsabilidad y la humildad, o a un mundo en el que nuestros descendientes serán más sanos, inteligentes, bellos, éticos y felices. O ambas cosas a la vez El debate social será imprescindible.
§3. Corregir genes: el resurgimiento de la terapia génica
Tras publicar el artículo que a continuación os describiré, me sorprendió recibir comentarios recelosos con la trascendencia de la investigación original, insinuando que no había para tanto y que la terapia génica era casi una entelequia.
Es cierto que los científicos llevan más de cuarenta años pregonando las esperanzadoras posibilidades de la terapia génica sin haber ofrecido por el momento ni un único tratamiento a los hospitales. Pero ese estudio era diferente: indicaba que la posibilidad de reparar genes dañados en adultos estaba cada vez más cerca. ¿Por qué pensé que la investigación era tan especial? Para ello debemos entender qué hace relevante a un artículo científico, y para quién.
En septiembre de 2009 la revista Science publicó el trabajo de unos investigadores estadounidenses en el que se describía una zona invariable del VIH, y la existencia de dos anticuerpos que actuaban específicamente sobre ella. Este descubrimiento es de gran relevancia para los científicos, ya que les ofrece una nueva vía para abordar la posible vacuna contra el sida. Por eso es importantísimo que se publique en una revista científica como Science y sea comunicado a toda la comunidad de investigadores. Para la opinión pública, ya es otra historia. Bien podría ser —como ocurre en la inmensa mayoría de los casos— que esta línea de investigación nunca llegara a dar frutos. Se encuentra en una etapa demasiado inicial Experimentos de ciencia básica, o con cultivos celulares, pueden ser muy notorios para los científicos, pero quedan lejísimos de la información relevante para el lector no especializado.
Los estudios con ratas de laboratorio están un poco más cerca, pero tampoco tanto. Nunca olvidaré el día en que mi entonces pareja me mostró dos fotografías de sus experimentos en angiogénesis. Llegó a casa toda entusiasmada, abrió el ordenador, y me enseñó la imagen de una rata blanca de cuyo vientre sobresalía un tumor negruzco de un centímetro y medio aproximadamente. Luego me mostró otra fotografía en la que se observaba el vientre de una rata normal y me dijo: «Es la misma rata, después del tratamiento que impedía desarrollar vasos sanguíneos alrededor del tumor. ¡Al final el tumor se secó!». Yo aluciné, y al observar un resultado tan claro enseguida le pregunté si podía dar lugar a un fármaco contra el cáncer. Se encogió de hombros, y admitió que ésa era la intención final, pero que dicho objetivo estaba lejísimos. No sabían todavía si el tratamiento iba a ser efectivo siempre, sobre qué tipo de tumores, si podía tener efectos secundarios, si el cáncer reaparecería, si funcionaría en humanos… era un resultado tremendamente valioso que merecía ser publicado, pero como parte de un camino que podría quedar estancado en cualquier momento. De hecho, así fue.
Dicho camino continúa —tras numerosas pruebas previas— con los estudios clínicos en humanos. Y aquí es cuando ya nos acercamos sigilosamente a la consulta médica.
Por este motivo, sí resulta muy trascendente que tres jóvenes de veintidós, veinticuatro y veinticinco años aquejados de un tipo de ceguera congénita causada por la mutación del gen RPE65 recuperaran parcialmente la visión cuando en 2007 un grupo de científicos les inyectaron directamente en sus retinas la copia correcta de este gen responsable de codificar una proteína necesaria para el adecuado funcionamiento de las células fotorreceptoras. Y si, además, un año después de la intervención los responsables del ensayo clínico en humanos confirman
Suena a ciencia ficción, pero no lo es. La biología sintética está llamada a ser una tecnología con la que rediseñar el mundo vivo creando organismos que nunca hubieran existido sin la intervención humana. Por ejemplo, podremos construir microorganismos que resistan ciertas condiciones en un fermentador y que realicen los procesos metabólicos que nos convengan, o que sean diminutos como para poder penetrar en el interior de una célula y una vez allí sinteticen un fármaco específico. Las aplicaciones industriales, médicas, o medioambientales son tremendamente amplias. Todavía no es el momento de pensar en aplicaciones, pero nadie duda de que llegarán, ni del potencial revolucionario de este campo que ahora es ciencia y pronto será tecnología.
A mitad de nuestra conversación Drew Endy sacó cuatro frascos de un cajón y me preguntó: « ¿Sabes qué es esto?». Leí las etiquetas «Guanina, citosina, timina y adenina», y respondí: «Las bases del ADN». Drew continuó: «Son materiales extraídos de la caña de azúcar. Cada frasco vale sólo 250 dólares, y con ellos hay cantidad suficiente para sintetizar treinta veces el material genético de todos los seres humanos de la Tierra. Las posibilidades que esto ofrece son amplísimas». Cierto que el precio del material bruto es lo de menos, pero el convencimiento absoluto de Endy me dejó perplejo: «No te puedo decir cuáles serán las primeras grandes aplicaciones ni cuándo llegarán, pero no tendremos que esperar cincuenta años, ni treinta, ni veinte. Estamos avanzando a un ritmo exponencial», aseguró, añadiendo el siguiente símil para reforzar el concepto revolucionario que envuelve a la biología sintética: «Hace miles de años nuestros antepasados empezaron a comprender las propiedades de las rocas, en qué se diferencian unas de otras, cómo reaccionan a diferentes condiciones, esto era ciencia y sería análogo a la biología. Luego utilizaron las rocas y los materiales que tenían en su entorno para construir edificios, esto es tecnología y equivaldría a la ingeniería genética actual. Y posteriormente empezaron a diseñar materiales sintéticos con propiedades mejores de las que podíamos encontrar en la naturaleza, esto es lo que hará la biología sintética construyendo desde cero de manera estandarizada».
¿Es lo que hará? No todos los expertos en biología sintética comparten la aproximación tan ambiciosa de Endy. La duda, en el fondo, es si los mecanismos intrínsecos de la vida son tan sencillos para que podamos comprenderlos y dominarlos a nuestro antojo, y si el concepto de ingeniería que funciona en la construcción de coches u ordenadores funcionará en la síntesis de organismos vivos.
Una investigación realizada en Barcelona sugirió que la vida es más complicada de lo que nos pensamos, y diseñarla cual ingenieros no va a ser tan fácil.
El Mycoplasma pneumoniae es una de las bacterias de vida libre más simples que existen: una pelotita de 2 micras rellena de una maraña de proteínas y escasos 689 genes flotando por su interior, envueltos por una membrana lipídica que no llega ni a pared celular, sin siquiera orgánulos celulares, y contando sólo con un citoesqueleto muy básico que da forma a una bola central donde se esparce el ADN. Lo único sofisticado que tiene es un apéndice con el que se desplaza por las células de tus pulmones, se engancha a ellas, y les roba aminoácidos, lípidos, y glucosa hasta matarlas. Total, tampoco es que aproveche muy bien dicha glucosa, pues por no tener no tiene ni un ciclo de Krebs completo; su metabolismo no pasa del ácido láctico y consigue entre unos míseros 2 y 4 ATP por molécula de azúcar. El M pneumoniae es un organismo tremendamente básico: unos pocos genes y complejos proteicos con lo mínimo para poder replicarse y dividirse. Pero es mejor no menospreciarlo, porque de simple no tiene un flagelo.
«Nosotros queríamos tener por primera vez un modelo matemático que permitiera explicar un ser vivo; tener la bacteria replicándose y dividiéndose en el ordenador. Ésa era la idea original, y seguimos con ella, pero pensábamos que iba a ser más fácil —explicaba el investigador Luis Serrano cuando le visité en su despacho del Parc de Recerca Biomedica de Barcelona (PRBB) —. Una bacteria normal tiene unas 400 proteínas que regulan la expresión de otras proteínas, y el micoplasma tiene como mucho 10. Otras bacterias tienen 50 sistemas que les permiten comunicarse con el mundo exterior mediante traducción de señales, mientras que el micoplasma sólo tiene una quinasa y una fosfatasa. Pero a pesar de que parece muy simple, tiene respuestas muy complejas a las perturbaciones exteriores», prosiguió Luis.
¿Y qué?, podéis pensar. Mucho. Los científicos eligen un organismo sencillísimo como el M pneumoniae para intentar comprender de manera global el funcionamiento más básico de una célula, y se dan cuenta de que la vida es todavía mucho más sofisticada de lo que pensaban En concreto, los investigadores detectaron un inesperadamente alto grado de complejidad a tres niveles: el transcriptoma son las señales completas que regulan la expresión de los genes en la bacteria; quién decide qué genes se activan y cuándo. Lo que el grupo de Luis Serrano descubrió es que cuando cambian las condiciones del medio, genes específicos del M Pneumoniae cambian su expresión de manera muy sofisticada para adaptarse a la nueva situación Y eso no lo pueden explicar con los poquísimos factores de transcripción conocidos con que cuenta la bacteria. El metaboloma son todas las reacciones químicas del interior celular destinadas a generar energía. De nuevo se observó una versatilidad inesperada, similar al metabolismo de los organismos más sofisticados. Y en el estudio del proteoma se encontraron interacciones entre proteínas que en principio no deberían tener nada que ver entre sí, sugiriendo que las comunicaciones internas dentro de la célula son mucho más elaboradas de lo previsto.
En definitiva: «Al haber utilizado en el pasado organismos más complejos para estudiar los mecanismos de regulación celular, quizá no nos dimos cuenta de que a un nivel inferior puede haber mecanismos mucho más básicos que todavía desconocemos», dijo Luis, sugiriendo que entender cómo funciona una célula en detalle iba a ser mucho más difícil de lo que se imaginaban.
Y esto, para una disciplina cuyo reto es diseñar organismos vivos en el laboratorio, sin duda tiene implicaciones. No es necesariamente una limitación, sino un cambio de estrategia en una disciplina que está empezando. La aproximación de Drew Endy liberándose del caos de los seres vivos, construyendo el equivalente molecular a herramientas como tuercas, tornillos o chips con los que sea fácil hacer ingeniería biológica porque los has analizado, comprendes perfectamente su funcionamiento, y sabes cómo se van a comportar cuando los pones juntos, puede no ser la más eficiente, al menos a corto plazo. Luis Serrano prefiere no menospreciar 4.000 millones de años de evolución y aprovechar la robustez que han acumulado ciertos organismos. Su enfoque para la biología sintética es más bien partir de una célula con las condiciones que nos puedan interesar, modificarla hasta conseguir ciertas características, e ir avanzando de momento a base de prueba y error como se ha hecho en los inicios de la mayoría de las tecnologías. Quizá algún día conozcamos tan bien el funcionamiento de una célula para diseñar sobre el papel su funcionamiento, y entonces tendrá más sentido una aproximación desde la ingeniería convencional como la de Endy, pero la complejidad manifiesta del Mycoplasma pneumoniae nos indica que esto no va a ser tan sencillo.
Pero ¿podrán algún día los ingenieros biológicos diseñar y construir un organismo vivo de manera parecida a como los ingenieros mecánicos diseñan y construyen un coche?
La pregunta es intelectualmente sobrecogedora. Aunque en realidad en el aspecto práctico no es tan relevante. De lo que no hay duda alguna es de que pronto seremos capaces de modificar seres vivos ya existentes a una escala muy superior a la ingeniería genética convencional. Diseñaremos nuevo ADN sintético, nuevas rutas metabólicas, nuevas estructuras, y funciones completamente insólitas en microorganismos inexistentes hasta el momento, creados para ser utilizados en la medicina, la energía, el medioambiente, el diseño, la industria, la alimentación o el bioterrorismo.
Un paso adelante que la comunidad científica acogió con recelo fue el anuncio en mayo de 2009 de Craig Venter asegurando que había creado una célula sintética: la primera forma de vida artificial El hito de Venter —porque sin duda lo es— fue secuenciar primero el genoma de una bacteria muy simple, sintetizar después en el laboratorio una copia haciendo pequeños cambios, introducir el ADN sintético en otra bacteria de características ligeramente diferentes, y lograr que el nuevo ADN se adueñara de su maquinaria celular y empezara a dividirse, convirtiéndose en el primer ser vivo cuyo material genético completo había sido creado de manera artificial.
Drew Endy, Luis Serrano, y la mayoría de los compañeros de Venter en el campo de la biología sintética discrepan en denominarlo vida artificial, pues no es suficiente con sintetizar un cromosoma entero e introducirlo en una célula que mantiene todo su engranaje. Será vida artificial cuando alguien consiga diseñar ex novo más elementos, y a poder ser cualitativamente diferentes de lo que ya existe en la naturaleza. De momento, la bacteria con ADN de Venter quedará registrada en los libros de historia como una muestra de poder tecnológico, y paso intermedio valiosísimo hacia la vida artificial que, sin duda, algún día llegará. Todo tipo de preguntas son válidas en estos momentos.
Capítulo VI
Ciencia, política y periodismo del cambio climático
§1. El difícil reto de entender y predecir científicamente el clima
§2. «Escépticos, depende; negacionistas, no»
§3. Ataque frustrado de los negacionistas a Obama
§4. El cambio climático no hay quien lo pare
§5. El Gran Hermano del cambio climático
§6. Acuerdo de Copenhague: ¿algo mejor que nada? ¡¡¡NO!!!
Poco me imaginaba un martes de noviembre de 2007, mientras me dirigía a la Kennedy School of Government de Harvard, que quien nos iba a impartir dos horas de seminario sobre ciencia, economía y política del cambio climático se convertiría poco más de un año después en el asesor científico directo de un inesperado presidente Barack Obama.
El encuentro con John Holdren fue extraordinario. Yo acudía a un Estados Unidos todavía comandado por George W. Bush esperando encontrar cierta resistencia a la necesidad de atajar políticamente un fenómeno tan complejo y polarizado como el cambio climático. Sin embargo, Holdren fue contundente al resumir la posición científica consensuada por la mayoría de los expertos en esta disciplina: «Tenemos incertidumbres, claro está. Pero de lo que no dudamos es de que el cambio climático es real, ya está causando daños significativos, se está acentuando, y su principal causa son los gases de efecto invernadero que nuestra manera de obtener energía emite a la atmósfera. Los países industrializados debemos empezar a reducir el uso de combustibles fósiles y las emisiones de dióxido de carbono. En las próximas décadas lidiaremos con tres opciones en la balanza de la lucha frente al cambio climático: mitigación (las medidas que adoptemos para frenar el calentamiento global), adaptación (prepararnos ante los efectos adversos del cambio climático), y sufrimiento (consecuencias negativas que no estaremos a tiempo de paliar). Sin duda, tendremos una combinación de estos tres factores. En nuestras manos está decidir cuál tendrá más peso. Cuanta más mitigación, menos adaptación necesitaremos para evitar el sufrimiento».
Tanta rotundidad me asustaba. Yo sabía que la verdad en ciencia no es democrática, y que ni el consenso ni la mayoría son quienes deciden dónde reside la razón. Si quería profundizar en el problema del cambio climático debía alejarme de certezas absolutas e ideas preconcebidas, y empezar a estudiar las diferentes fuentes con una mente bien abierta. Aunque mi intuición suscribía las palabras de Holdren, no era el momento todavía de hacérmelas mías sólo por un principio de autoridad.
Por eso atendí con exquisito detalle los argumentos científicos con que pretendió avalar sus convicciones, antes de analizar las diferentes fases por las que estaba transitando el movimiento escéptico. Hagamos lo propio, y empecemos revisando cuál es la base científica consensuada por la mayoría de los investigadores que intentan vislumbrar la evolución del clima en nuestro planeta.
§1. El difícil reto de entender y predecir científicamente el clima
La historia de la Tierra ha presenciado cambios climáticos mucho más extremos del que podamos estar sufriendo ahora. Hace 700 millones de años el planeta estaba cubierto de hielo y nieve casi por completo. Unos 50 millones de años atrás, sin embargo, un calentamiento extremo aumentó drásticamente la temperatura del mar, derritió los polos, y provocó la extinción de un elevadísimo número de especies animales. En los últimos 3 millones de años los cambios en el clima no han sido tan abruptos, pero hemos continuado alternando temperaturas suaves como la actual con períodos de rápido calentamiento y épocas glaciales durante las cuales los continentes del hemisferio norte estaban cubiertos de enormes capas de hielo. La explicación más aceptada a estas últimas glaciaciones son ligeras oscilaciones periódicas en la orientación del eje de la Tierra que afectan a la distribución de energía que nos llega del Sol: la tierra firme, el hielo de las regiones polares y el agua no absorben ni reflejan de la misma manera la radiación solar. Y como la distribución de estos tres elementos es considerablemente diferente en ambos hemisferios, la modificación del eje de rotación terrestre hace que cambie la cantidad de energía solar que se queda en la Tierra y se encadenen una serie de sucesos que desembocan en una época glacial. De hecho, si sólo tuviéramos en cuenta esta geología básica, deberíamos haber llegado a escenarios muchísimo más extremos. A medida que la nieve y el hielo se fueron acumulando reflejaban cada vez mayor cantidad de luz solar de vuelta al espacio en un proceso de retroalimentación positiva (una perturbación genera efectos que incrementan la perturbación en el mismo sentido), debiendo haber continuado enfriando poco a poco el planeta hasta convertirlo en una gran bola de nieve, cuyo estado templado sólo podría haberse recuperado por grandes explosiones volcánicas u otros incidentes externos. De la misma manera, en períodos en los que el cambio del eje de rotación favoreció el aumento rápido de temperaturas, los procesos de retroalimentación positiva provocaron la acumulación de vapor de agua —el gas de efecto invernadero más poderoso que existe—, generando una espiral de calentamiento que debería haber convertido el planeta en un lugar increíblemente cálido, evaporándose incluso gran parte de los océanos.
Si estas situaciones no se han producido en la historia de la Tierra es gracias a la existencia de vida. Como popularizó en la década de 1960 la hipótesis de Gaia de James Lovelock, la vida ha atenuado estos cambios por medio de unos sistemas de retroalimentación negativa que han mantenido el planeta en unas condiciones favorables para sus habitantes, y la atmósfera en un extrañísimo equilibrio de nitrógeno, oxígeno y trazas de otros gases, como vapor de agua, metano, o dióxido de carbono. Este dióxido de carbono es justamente uno de los sistemas de retroalimentación que moldea el clima terrestre y, gracias a una reconstrucción mucho más afinada de cómo ha ido cambiando el clima en tiempos recientes, los paleo climatólogos han podido constatar su estrecha relación con las temperaturas del planeta.
Para ello, se han servido de unas pistas preciosas: burbujas de aire que quedaron atrapadas en los hielos de Groenlandia y la Antártida a medida que éstos se iban formando. Mediante la perforación de esas densas capas de hielo, los paleo climatólogos están rescatando dichas burbujas prehistóricas y midiendo su composición química, detectando la presencia de metano, dióxido de carbono, y llegando incluso a poder evaluar la temperatura de la atmósfera gracias a la relación que ésta guarda con la proporción entre dos isótopos del oxígeno. Entre las conclusiones que han sacado, hay una fuera de cualquier duda: el vínculo entre CO2 y temperatura es estrechísimo. Cuando los científicos sobreponen gráficos de aumentos y descensos de la temperatura en los últimos 800.000 años con los de incremento y disminución de CO2, la relación es inequívoca. Ambos factores están íntimamente relacionados, detectándose subidas de temperatura cuando aumenta la concentración del gas, y viceversa. Otro dato les ha sorprendido y dejado preocupados: nunca en los últimos 800.000 años la concentración de CO2 en la atmósfera había superado las 300 ppm (partes por millón). Pero en las últimas cinco décadas, y a consecuencia de nuestra quema de combustibles fósiles, la cantidad de dióxido de carbono ha aumentado de manera vertiginosa hasta alcanzar las 380 ppm en 2008, y superar las 390 ppm en 2010. Nada indica que vaya a detenerse aquí, y si su relación con la temperatura global del planeta se mantiene intacta, nos puede llevar a un calentamiento global de una rapidez sin precedentes.
¿Cómo? Hablemos del efecto invernadero y del papel que el CO2 juega en el mismo. El Sol nos envía constantemente energía por medio de radiaciones electromagnéticas. La atmósfera intercepta y refleja de vuelta al espacio una pequeña parte de ellas (por ejemplo, gran parte de la radiación ultravioleta gracias al ozono de la estratosfera), pero es transparente a la mayoría de las longitudes de onda que le llegan Cuando la radiación solar incide sobre la superficie de la Tierra, es absorbida y la calienta. Ese calor es posteriormente re-irradiado desde la Tierra hacia el espacio, con longitudes de onda menos energéticas de las que llegaron El problema —o ventaja— es que la atmósfera ya no es transparente a estas ondas menos energéticas, y en lugar de escapar de la Tierra, son absorbidas por ciertos gases y reflejadas de nuevo hacia la superficie. De esta forma, el calor «no puede escapar», quedando atrapado entre la fina capa de gases que compone la atmósfera y la superficie terrestre, como si de un invernadero se tratara, aumentando por consiguiente la temperatura del planeta. El oxígeno y el nitrógeno no intervienen en absoluto en dicho proceso; los principales responsables de este efecto invernadero son el vapor de agua, el CO2 y el metano. El vapor de agua es el elemento más influyente en el calentamiento, pero por suerte su concentración se regula constantemente mediante lluvias y evaporación. Algo muy diferente ocurre con el metano y el CO2, cuya presencia en la atmósfera tarda muchísimo más tiempo en reciclarse (centenares de años en el caso del dióxido de carbono), y el aumento súbito de su concentración en la atmósfera —ya sea por fenómenos naturales como la actividad volcánica o por emisiones antropocéntricas— tiene efectos durante un largo período de tiempo.
Sin duda, no es un fenómeno tan simple como el que acabo de describir, pero la física básica detrás del efecto invernadero está sobradamente comprendida y modelizada. Si cambiáramos la concentración de un gas manteniendo el resto del sistema intacto, los climatólogos podrían predecir con bastante acierto cómo ello afectaría a la temperatura del planeta. La controversia llega porque, evidentemente, los cambios nunca llegan solos, y es harto complicado discernir cómo se relacionan todos los elementos que forman parte de un sistema tan complejo como el clima terrestre. A pesar de eso, y de que es imposible predecir el clima atmosférico a cortos períodos de tiempo debido al caos inherente en el sistema, los científicos sí pueden tener bajo control algunos parámetros básicos. Por ejemplo, es muy fácil aventurar que en Madrid pasarás más frío en invierno que en verano debido a la inclinación del eje terrestre. También han logrado conocer cómo los ciclos regulares de actividad solar afectan a la temperatura del planeta. Y hasta cierto punto saben cómo calcular el efecto de las grandes erupciones volcánicas u otros fenómenos de origen natural Los climatólogos llevan varias décadas recogiendo datos y monitoreando todos estos factores. Las mediciones detalladas de datos meteorológicos no empezaron hasta el siglo XIX, pero utilizando anillos de árboles, acumulaciones de polen, o restos en sedimentos oceánicos, han sido capaces de remontarse mucho más atrás en el tiempo y conocer de manera muy precisa las fluctuaciones de la temperatura. Y cuando plasman todos estos datos en gráficos vuelven a encontrar un hecho sorprendente: aunque nosotros lo percibamos como nimio, el aumento de la temperatura en las últimas décadas se está produciendo a un ritmo sin precedentes. Nunca antes la temperatura había aumentado de manera tan rápida sin una causa natural que lo explicara. ¿Sin una causa natural que lo explicara? Aquí es donde aparecen en escena los controvertidos modelos climáticos, monumentales expresiones matemáticas capaces de simular la evolución climática que, al contrario de lo que argumentan algunos de sus críticos, sí pueden ser testados con relativa facilidad. La clave está en utilizar esos registros tan detallados de los últimos 150 años para poner a prueba los modelos e ir ajustándolos hasta que sean capaces de describir la evolución climática de este último siglo y medio. Una vez conseguido esto, se convierten en valiosas herramientas capaces de predecir el clima en el futuro. Nadie les presupone una perfección absoluta, pero el grado de afinamiento que han conseguido los modelos informáticos es realmente alto. Incluyen flujos de la atmósfera y los océanos, condensación y precipitación de agua, ciclos solares, y un gran número de otros factores. Existen decenas de estos modelos y, aunque difieren ligeramente, sí son consistentes en algunas conclusiones. Una de ellas es fundamental: cuando intentan predecir cómo habría evolucionado la temperatura de la Tierra durante el siglo XX eliminando la actividad humana de la ecuación, logran reproducir muy bien los altibajos ocurridos durante las primeras décadas, pero a partir de la de 1950 no prevén ningún aumento constante de la temperatura media. Con subidas y bajadas, pero la tendencia sigue estable. Sin embargo, cuando introducen el aumento de CO2 atmosférico de los últimos sesenta años por la quema de combustibles fósiles, describen a la perfección el aumento de temperaturas que estamos viviendo. Es decir, los modelos ajustan todos los parámetros naturales, y sólo logran explicar el calentamiento reciente del planeta si incluyen el incremento antrópico reciente de CO2. Otro factor importante es que el CO2 producido por la quema de combustibles fósiles generados hace millones de años contiene una menor cantidad de isótopos 13C que el emitido por otras fuentes. Gracias a ello, los científicos han podido analizar la proporción de isótopos 13C/12C en el dióxido de carbono atmosférico y concluido con total seguridad que su aumento durante las últimas décadas es de origen antropocéntrico.
Sin duda se trata de un fenómeno complejo. Pero toda esta acumulación de datos —y muchos más— son los que dejan a la comunidad científica convencidísima de que el aumento de CO2 atmosférico que estamos provocando con nuestra quema de combustibles fósiles es el principal responsable del cambio climático que ya hemos empezado a sufrir.
¿Qué nos depara el futuro? Aquí la incertidumbre aumenta. Todos los modelos climáticos apuntan a un aumento de la temperatura media que conllevará graves disrupciones en el clima. Posiblemente, la realidad se encontrará entre las estimaciones más altas y las más bajas, pero todos los cálculos, sin excepción, apuntan al alza. Desertificación en ciertas zonas, inundaciones en otras, deshielo de los glaciares y los polos, acidificación de los océanos, pérdida de la biodiversidad y sobre todo huracanes más extremos y aumento del nivel del mar parecen consecuencias inevitables de tener un sistema tan sobrecargado energéticamente. La severidad de estos daños, y cómo minimizarlos, es lo que está en discusión dentro de la comunidad científica. Los más optimistas confían en la capacidad de autorregulación de la Tierra para atenuar esta tendencia. Pero otros temen que, como ha ocurrido en ocasiones anteriores, los efectos se retroalimenten hasta crear saltos repentinos de un punto de equilibrio a otro, con resultados catastróficos. Si bien el calentamiento global y su origen están aceptados por la mayoría de los investigadores, el debate sobre la gravedad de sus consecuencias ha llegado totalmente desvirtuado a la opinión pública.
Haciendo un poco de historia, en 1979 un trabajo de la Academia Nacional de Ciencias de Estados Unidos ya alertó de que doblar el CO2 atmosférico implicaría subidas de temperaturas globales muy peligrosas. Y en 1988 el climatólogo de la NASA James Hansen testificó ante el Congreso estadounidense, mostrando pruebas de que el cambio climático ya había empezado. Sus palabras fueron tomadas inicialmente con escepticismo incluso dentro de la comunidad científica. Pero a medida que las evidencias iban confirmando la realidad del cambio climático, empezó a gestarse un debate politizado y polarizado entre dos posiciones antagónicas: unas versiones catastrofistas que pronosticaban escenarios de futuro apocalípticos, y un movimiento escéptico transformado a negacionista que renegaba del cambio climático y buscaba constantemente flecos en una ciencia que no podía pretender ser exacta.
Las tres fases del escepticismo sobre el cambio climático
John Holdren fue tremendamente crítico con el movimiento escéptico, al que acusó de haber estado sembrando dudas y ralentizando enormemente la toma de decisiones políticas. Por eso quiso analizar las tres etapas por las que solían pasar las actitudes escépticas hacia la idea básica de que el cambio climático está causado por la actividad humana:
1ª etapa: «Los científicos pueden estar equivocados». Innegable. Pero este escepticismo sólo tenía sentido diez años atrás, cuando todavía no había pruebas tan concluyentes de que las emisiones antropocéntricas de CO2eran la causa principal del calentamiento del planeta. Con los datos acumulados en ese momento, la unanimidad científica era prácticamente absoluta.
2ª etapa: «Los científicos exageran». Este escepticismo era más actual. Asumía que los científicos tenían razón en cuanto al origen del problema, pero cuestionaba que los efectos del calentamiento global fueran tan graves como ellos pensaban. La controversia no estaba cerrada, desde luego, pero dicho escepticismo se basaba en apreciaciones individuales y estudios minoritarios. La gran mayoría de las investigaciones aseguraban de forma cada vez más contundente que la situación era realmente preocupante.
3ª etapa: «Ya es demasiado tarde para hacer algo al respecto». John Holdren se sentía preocupado porque esta postura —más bien pesimista que escéptica— estaba cogiendo fuerza incluso entre algunos expertos. Los que la mantienen reconocen que las predicciones científicas son acertadas, pero opinan que llevamos demasiado tiempo maltratando el planeta como para poder solucionarlo, y muestran cierto derrotismo tras constatar durante años la indiferencia política a sus mensajes.
A pesar de todo este escepticismo paralizador, el mensaje de Holdren era positivo. Desde una posición a la que pocos tenían acceso, decía percibir un cambio de actitud más que considerable en la clase política de su propio país, y aseguraba que los gobiernos por fin estaban analizando muy en serio el problema. Terminó la charla mostrándose muy expectante ante qué iba a suceder la semana siguiente durante la conferencia sobre cambio climático que las Naciones Unidas había organizado en Bali, en diciembre de 2007.
Nada ocurrió en Bali Estaba claro que el gobierno de Estados Unidos, a un año de finalizar el mandato de George W. Bush, no empezaría a adoptar compromisos para reducir las emisiones de CO2. Y ninguna otra región iba a enfrentarse en serio al asunto hasta que el país con mayor responsabilidad en la problemática del cambio climático diera un claro primer paso. Tocaba esperar unos meses a ver quién iba a ocupar la Casa Blanca. Mientras, yo seguiría mi andadura particular intentando comprender el fenómeno del cambio climático desde una perspectiva amplia, y manteniendo un espíritu abierto a resquicios en las explicaciones que tan claras parecía tener ese consenso científico.
Recuerdo las clases sobre física atmosférica del meteorólogo Kerry Emmanuel, o la asignatura global climate change: economics, science and policy del genial Henry Jacoby. También reuniones internas con periodistas especializados discutiendo sobre las consecuencias negativas de un catastrofismo desmesurado cuya intención era movilizar a una opinión pública apática, del problema de un periodismo que alimentaba un debate interminable donde en realidad no lo había, o de la costumbre de contraponer siempre los dos lados más radicales de la historia. Y todavía tengo grabado en la memoria el día en que, desde la confidencialidad que prometían nuestros seminarios, uno de los expertos más influyentes en materia de cambio climático nos confesó: «Yo soy de los que en su momento recomendó al presidente de Estados Unidos no respetar Kioto, porque los datos de que disponíamos entonces no eran concluyentes. Ahora son incontestables».
Yo escuchaba con una mente abierta y en absoluto crédula, pero reconozco que por muy mal que me sonara la palabra «consenso», mi escepticismo se iba diluyendo. Aun sabiendo que la verdad no era democrática, mantener dudas sobre la solidez científica del cambio climático lo hubiera transformado en negacionismo. Por eso, cuando alguien insinuó que debía ser más crítico con el consenso científico, sentí la necesidad de exponer en el blog cuál era mi posición intelectual al respecto.
§2. «Escépticos, depende; negacionistas, no»
«El escepticismo en la ciencia es bueno. Más que bueno; es necesario. Más que necesario; es un requerimiento, una obligación de cualquier persona que pretenda observar el mundo desde una perspectiva científica. Por eso, en el post donde criticaba a los que niegan la existencia de un cambio climático provocado por la actividad humana no cité a los escépticos (un término y una actitud intelectual que respeto), sino a los deniers (un término y una actitud intelectual que repruebo). El escéptico es una persona formada, crítica con la información que le llega, y que no duda en argumentar utilizando datos científicos objetivos. En ocasiones puede resultar un tozudo y mostrarse arrogante, pero en el fondo está abierto a cambiar su manera de pensar si las evidencias se lo indican. Los negacionistas, en cambio, son personas cuyo escepticismo se ha ensuciado de ideología, y mantienen una postura dogmática y activista en contra del cambio climático. Cada negacionista radical tiene sus razones no científicas para ello.
»Aquí no decimos que, sin lugar a dudas, el calentamiento global vaya a desembocar en una situación catastrófica. Ni negamos que haya incertidumbres por resolver todavía. Nadie dice que el dióxido de carbono sea el único responsable, ni que los modelos climáticos sean perfectos, ni que sepamos con certeza cómo reaccionará la naturaleza a un posible aumento de la temperatura. Pero sí creemos en el mensaje básico que la inmensa mayoría de los investigadores nos llevan diciendo desde hace años: la actividad humana es responsable de un cambio inusual en el clima, y en un mundo con cada vez más demanda energética, si no nos esforzamos en reducir la emisión de gases de efecto invernadero, las consecuencias a medio plazo pueden ser muy graves. Ir a contracorriente es tentador. Aquéllos que deseen mantener una posición escéptica y desconfiar del consenso científico siempre encontrarán algún fleco por donde alimentar su inconformismo provocador. De nuevo, tienen todo el derecho intelectual de hacerlo, pero también deben considerar las peligrosas consecuencias paralizantes que pueden conllevar sus acciones. Si las dudas en la opinión pública sirven como excusa a los gobiernos para retrasar las acciones destinadas a mitigar el cambio climático, y al final resulta que tenía razón la casi totalidad de los expertos que están advirtiendo de sus posibles consecuencias, quizá habremos reaccionado demasiado tarde. Las decisiones políticas no se toman bajo certezas incontestables. No podemos permitirnos la insensatez de esperar a ver qué ocurre. Las discusiones sobre el calentamiento global no pueden ser tratadas de la misma manera que el debate entre los genes y el entorno, la teoría de cuerdas, el futuro de la inteligencia artificial, la coexistencia de la ciencia y la religión, o las características de los homínidos que nos precedieron En ocasiones toca posicionarnos y actuar, estemos plenamente convencidos o no».
Escribir te clarifica las ideas. Sobre todo si lo haces con el cuidado de saber que mucha gente va a leerte. Mi posición se estaba consolidando: el negacionista que todavía rechazara la influencia humana en el cambio climático estaba profundamente desactualizado. El que pensara que la situación tampoco era tan grave podía tener razón si vivía en una zona acomodada no costera del primer mundo y no le importaban las sequías, las pandemias, la intensificación de huracanes, la desaparición de especies, o el menor rendimiento agrícola en los países pobres. Y quien creyera que era un problema de imposible solución, que se apartara y no interfiriera en los que sí pretendían intentarlo.
Continuaba creyendo que las dudas alrededor del cambio climático eran legítimas, pero demasiado débiles como para frenar por más tiempo la toma de decisiones. Sin embargo, dos sucesos me hicieron ver que muchas de esas dudas no eran ni siquiera legítimas. El primero fue una cena privada con una persona cuyo nombre sería injusto airear, muy influyente políticamente, respetado académicamente en el campo de la economía y el mundo en vías de desarrollo, y que se había manifestado repetidamente en público en contra del cambio climático. Acudía al encuentro intrigado por escuchar los argumentos escépticos que podía esgrimir alguien tan bien asesorado y con tanta responsabilidad social. Qué decepción. Quedé boquiabierto cuando a mi primera pregunta respondió con cierto desdén: «Eso es el Sol». « ¿Cómo? —repliqué—. Está demostradísimo que los ciclos solares no explican las subidas de las últimas décadas». Continuó: «Llevamos un par de años menos cálidos, y el invierno pasado fue muy frío», insistió ante mi asombro. No podía creer tanta simplicidad. Tras refutar un par de tópicos más, terminó con un tajante: «Mira, hay cosas más urgentes por las que preocuparse en el mundo». Innegable pero cortoplacista, e insuficiente para negar la existencia de un cambio climático como él había estado haciendo alegremente en sus artículos. Me sentí perplejo; ¿cómo podía una persona tan indudablemente capacitada y lúcida mostrarse convencida con argumentos tan débiles? Alan Leshner, editor de la revista Science y presidente de la Asociación Americana para el Avance de la Ciencia, me respondió a esa inquietud cuando la comentamos meses después durante una entrevista en su despacho de Washington D. C.: «Los únicos que se aferran a los datos experimentales son los científicos. En general, la gente antepone sus propias ideas a lo que diga la ciencia. La tendencia natural es posicionarte desde un principio a un lado de la discusión, por el motivo inicial que sea, y luego atender sólo a los argumentos que lo refuercen, y desoír los que te contradigan A ti y a mí nos puede parecer lógico cambiar de manera de pensar porque un científico nos lo diga, pero en la mayoría de las personas no funciona así».
Era una explicación, pero también una advertencia. ¿No estaría cayendo yo en el mismo error? Tuve la oportunidad de ponerlo a prueba gracias a un segundo suceso que iba a afianzar todavía más algunas de mis ideas…
§3. Ataque frustrado de los negacionistas a Obama
La última semana de abril de 2009 aparecía en varios de los periódicos con más tirada de Estados Unidos un anuncio a toda página encabezado por el siguiente fragmento de un discurso de Barack Obama pocos días después de haber sido elegido presidente de Estados Unidos: «Pocos retos afronta Estados Unidos y el mundo más urgentes que luchar contra el cambio climático. La ciencia está fuera de disputa, y los hechos son claros».
Bajo estas palabras se podía leer en letras bien grandes la frase: «Con todos los respetos, señor presidente, esto no es verdad».
Y continuaba un texto que decía: «Los científicos abajo firmantes mantenemos que la alarma por el cambio climático es exagerada. […] Los cambios de temperatura en este siglo han sido modestos […] en la última década no ha existido calentamiento.

¿Qué investigadores se distraen con eso? Biólogos del Whitehead Institute como Danielle Wenemoser, que durante una cena de amigos y tras mi típica pregunta «¿A qué te dedicas?» se le ocurrió decirme que investigaba regeneración celular con unos gusanos llamados planarias, y acababan de grabar uno con ocho cabezas, el caso visualmente más espectacular que se había conseguido hasta el momento. A los pocos días estaba en su laboratorio, pidiéndole a su jefe que nos cediera el vídeo y explicara qué sacaban en claro cortando cabecitas de gusanos milimétricos. Ahí va la explicación, pero no dejéis de ver el vídeo. No encontraréis nada mejor en YouTube.
¿Qué es una planaria?
Las planarias son gusanos con una capacidad de regeneración espectacular. Si le cortas una pata a una salamandra, le crecerá una nueva. Si te quitan la mitad del hígado, volverá a crecer. Algunos peces regeneran aletas e incluso parte de la espina dorsal. Pero esto no es nada comparado con lo que hacen las sorprendentes planarias, animales cuya capacidad regenerativa extrema lleva estudiándose más de cien años: si las partes por la mitad, en uno de los trozos crecerá una cabeza y en el otro una cola. Si cortas la cabeza entre los ojos, al poco tiempo tendrás un gusano con dos cabezas completas e independientes. Le quitas un fragmento 300 veces más pequeño que el total del cuerpo, y es capaz de regenerar un individuo entero. De verdad, es más espectacular de lo que parece, ese fragmento diminuto que acabas de extraer no tiene ni «boca-ano» (las planarias comen y excretan residuos por el mismo orificio situado en medio de su cuerpo), ni cerebro, ni casi nada. ¿Cómo crece entonces? ¿Cómo se alimenta mientras todavía no tiene boca, ni sistema digestivo? Resulta que no sólo aparecen nuevas células, sino que algunas de las preexistentes en ese trocito ínfimo que equivaldría a sacarte un pedazo de la pierna se transformarán en estructuras básicas del organismo. Además, es que no se trata de un simple crecimiento, sino de una verdadera regeneración en sentido inverso al desarrollo normal. No es que te corten un brazo y crezca uno nuevo, es que ¡a partir del brazo sale un individuo completo!
Pero ¿cómo lo consiguen? y ¿cómo sabe el trozo de gusano dónde tiene que crecer una cola o una cabeza? Eso es lo que está estudiando el laboratorio de Peter Reddien. Las planarias son un modelo animal ideal para estudiar las células madre; qué mecanismos hay involucrados en su diferenciación, qué señales están relacionadas en el desarrollo de nuevas estructuras, qué diferencia una célula de planaria y una humana, y cómo podríamos llegar a inducir cierta regeneración.
Peter Reddien es de los científicos honestos que no te vende aplicaciones espectaculares en un futuro cercano. Asegura que todavía estamos en la fase de investigación básica para comprender los factores genéticos y moleculares relacionados en estos procesos. Le pregunto si ve viable el siguiente escenario: «Imagínate que dentro de un tiempo entendáis perfectamente los mecanismos involucrados en la regeneración de la pata de una salamandra y, al compararlos con un ratón, comprobéis qué es lo que tiene inhibido. ¿Te imaginas poder activar genes, o inducir señales moleculares que despierten la capacidad de regeneración que un ratón tenía silenciada, y conseguir que le crezca de nuevo una pierna amputada?». Me mira con cara de «a tanto no llegaremos», pero admite que en el fondo ésa es la idea básica: «Entender qué ocurre a nivel molecular, compararlo con animales que no se regeneran, y ver si podemos inducir algún tipo de regeneración celular».
¿Cómo hacer un gusano con múltiples cabezas?
Peter Reddien es reconocido por aplicar las técnicas de RNAi (ARN de interferencia) al estudio de planarias. Lo que hacen es bloquear con fragmentos de ARN genes específicos de un animal, y ver qué ocurre. Si al animal sólo le aparece un ojo (me lo invento), es que el gen silenciado estaba relacionado con el desarrollo de los ojos. Con esta metodología han dado respuesta a una de las preguntas más antiguas de los investigadores en planarias: cuando cortas la cabeza y la cola de un gusano a la vez, el fragmento que queda, ¿cómo sabe que de un extremo tiene que salir una cabeza y del otro una cola? Un investigador de su laboratorio, Chris Petersen, demostró que el gen Smed-catenin-1 controlaba la polaridad en esta regeneración De hecho, cuando silenciaban este gen y cortaban la parte posterior de la planaria, le salía otra cabeza en lugar de una cola. Y cuando sobre expresaban ese mismo gen, generaban un gusano con dos colas y ninguna cabeza.
De esta misma manera consiguieron los ejemplares del vídeo: inhibieron el genSmed-catenin-1, realizaron varios cortes a los gusanos originales, y de las incisiones iban apareciendo cabezas. De nuevo, el objetivo final era encontrar diferencias entre una célula de planaria y una humana. Y no hay tantas. Se calcula que este «ridículo» gusano tiene 20.000 genes, y nosotros unos 25.000. A nivel celular, compartimos una larga historia biológica en común y no somos tan diferentes como nuestra apariencia externa puede sugerir.
2.5. Del amor al odio en un solo parásito
Paseando con actitud de explorador científico por la sesión de pósters de un congreso de neurociencia, se cerró un ciclo casi tan inverosímil como las vidas de las criaturas que inventaron el control mental: los fascinantes parásitos.
Hay un parásito que cuando invade el cerebro de unas hormigas las induce a subir a lo alto de la hierba para permitir que una vaca se las coma. Este parásito sólo puede madurar en el hígado del rumiante, luego viaja a su intestino para reproducirse, y allí libera huevos por las heces. Estos huevos generan larvas que de alguna manera deben regresar al hígado de la vaca. Lo consiguen infectando hormigas, manipulando su comportamiento, y utilizándolas como vector que les permite completar el ciclo.
Pobres hormigas; cuando otro hongo parásito determinado las infecta, también empiezan a trepar por las hojas de la hierba para que cuando el hongo emerja de su cabeza pueda explotar y expulsar las esporas desde más alto.
Más curioso todavía: cuando el parásito Sacculina granifera coloniza el cuerpo de un cangrejo macho, secreta unas hormonas feminizantes que le hacen comportarse como si fuera una hembra. El cangrejo se dirige hacia la arena, hace un agujero, y adopta la posición de expulsar larvas; pero salen las del parásito, claro.
También hay un crustáceo llamado Gammarus lacustris que se alimenta en las orillas de los ríos, y suele escapar rápidamente si aparece un pato. En cambio, cuando está infectado de una larva que sólo se reproduce en el cuerpo de las aves, hace todo lo contrario: sale del agua y se deja devorar por los patos. El parásito se ha adueñado de su mente y llega a dirigir su comportamiento.
Algo parecido ocurre con el parásito por el que se advierte a las embarazadas que no estén en contacto con los gatos: la mayoría de nosotros, y con total seguridad los que hayáis convivido con gatos, tenéis el Toxoplasma gondii enquistado en algunas de vuestras células. No os preocupéis, no es peligroso. Sólo causa problemas cuando el sistema inmunológico se deprime por enfermedades como el sida, o no está todavía desarrollado como en los fetos. Por ese motivo a las embarazadas les recomiendan alejarse de los gatos, porque son el único animal en cuyos intestinos se reproduce el Toxoplasma.
Eso lo saben los médicos, pero no los ratones. Cuando este parásito infecta a un ratón, viaja a su cerebro, de alguna manera afecta a su comportamiento, y hace que pierda el miedo a los gatos. Por increíble que parezca, esto se demostró con un experimento muy sencillo en la Universidad de Oxford: el científico Manuel Berdoy construyó una especie de gran jaula-jeroglífico con diferentes caminos y estancias, y puso orina de gato en un rincón. Cuando colocó ratones normales en la jaula, éstos evitaban a toda costa acercarse a ese lugar. En cambio, al poner roedores infectados pasaban por allí sin ningún inconveniente. Habían perdido el miedo a los gatos.
Este experimento, que leí en un artículo de Scientific American hace años, fue el que despertó mi profundo interés por los parásitos, e hizo que continuara rascando en esta evidencia de que la belleza está en los ojos del espectador. El artículo era obra del neurocientífico de Stanford Robert Sapolsky, quien explicaba que en 2002 estaba paseando por la sesión de pósters del congreso anual de la Sociedad de Neurociencia estadounidense, se topó con la investigación de Berdoy y le pareció lo más intrigante que había leído en mucho tiempo. Causalidades de la vida, en noviembre de 2008 yo estaba paseando por la sesión de pósters de ese mismo congreso, y me topé con un trabajo que hablaba del mecanismo fisiológico por el cual el Toxoplasma modificaba el comportamiento de los ratones. Miré quiénes eran los autores del póster, y leí: «Sapolsky, R.» ¡Uau! Abordé de inmediato al joven investigador que estaba plantado enfrente del póster, preguntándole si existía alguna relación con el artículo que yo había leído cinco años antes. Patrick House respondió sin vacilar: « ¡Claro! Robert llegó impactado. Él trabaja en neurofisiología del estrés, y nos dijo que debíamos entender a toda costa qué hacía el Toxoplasma en el cerebro de los ratones». Cinco años después, parece que se cerraba el ciclo. Patrick me explicó que el Toxoplasma afecta a la segregación de una hormona relacionada con el estrés llamada corticosterona. Cuando exponían ratones sanos a orín de gato, sus niveles de corticosterona aumentaban, generando una reacción de estrés y de miedo. Sin embargo, en los ratones parasitados no se apreciaba ningún cambio. Además, habían observado una mayor actividad cerebral en las áreas relacionadas con la atracción, una respuesta equivalente a cuando se les presentaba olor de ratón hembra. Según Patrick House, la atracción y el miedo podrían estar mucho más relacionados fisiológicamente de lo que podemos pensar. Cuando le pregunté si el Toxoplasma podía tener algún efecto en los humanos, me respondió que ciertos estudios relacionaban este parásito con la esquizofrenia, las conductas arriesgadas, el incremento de testosterona en los hombres, y la promiscuidad en las mujeres, pero matizó que se trataba de investigaciones con muestras muy pequeñas. Actualmente, su equipo está analizando el genoma del Toxoplasma, ya que posee genes que codifican moléculas análogas de neurotransmisores. Este hecho podría explicar su capacidad de manipular la mente de los ratones.
Alucinantes los maravillosos parásitos. En la antigua Grecia los Parasitos (para:- «al lado de»; sitos: «comida») eran las personas encargadas de custodiar las despensas de comida y servirla en los banquetes. Precisamente delgados no estaban y, con el tiempo, el término pasó a aplicarse a cualquier individuo que conseguía alimentarse a costa de otros. Fue bastantes siglos más tarde cuando la biología incorporó esta palabra a su terminología científica para definir a los seres que necesitan vivir dentro o sobre otros animales o plantas para aprovecharse directamente de ellos.
Los parásitos son las criaturas más fascinantes que existen. Hay un crustáceo parásito que cuando invade cierto tipo de peces, primero se come sus lenguas y después se engancha a sus agallas para ir creciendo hasta convertirse en una nueva y más dura lengua. El pez la utilizará igualmente para triturar su comida, pero parte de la presa se la quedará el crustáceo. El sapo Scaphiopus couchi pasa once meses al año durmiendo enterrado bajo las arenas del desierto de Arizona, acompañado de un pequeño gusano que le va chupando sangre desde su vejiga y poniendo huevos. Cuando llegan las noches lluviosas de julio y agosto, el sapo despierta para reproducirse y comer termitas, momento que aprovecha el parásito para expulsar las larvas en busca de nuevos hospedadores con los que repetir el ciclo. Si algún día te pica la famosa mosca tsé-tsé, quizá te transmita algún parásito africano del género Trypanosoma, que empezaría a robar oxígeno y glucosa de tus células, se multiplicaría, se las apañaría para hacer un quiebro a tu sistema inmunológico y llegaría a tu cerebro, donde descontrolaría tu reloj biológico transformando la noche en día y provocando la peligrosa enfermedad del sueño.
Hay más especies parasitarias que de vida libre, hay parásitos multicelulares que viven dentro de una única célula, hay parásitos que se reproducen solos y otros que viven en cópula permanentemente, e incluso hay parásitos que infectan a otros parásitos. La diversidad de formas y ciclos de vida de los parásitos es espectacular. De acuerdo, ojalá estuviera erradicado el dichoso protozoo microscópico Plasmodium, que causa un millón y medio de muertes al año por malaria. Tampoco hace ninguna gracia que la mayoría de los niños en el Tercer Mundo compartan su comida con gusanos instalados en sus intestinos como el Ascaris lumbricoides. Y a nadie le parecen atractivos los piojos o amebas que causan diarreas en viajeros. Pero si nos alienamos de los problemas sanitarios que provocan, los parásitos nos abrirán las puertas a un mundo mucho más aberrante, misterioso y fascinante de lo que podamos llegar a imaginar.
2.6. Origen de la pre-vida
Para encuentros fortuitos, el de los estudiantes que encontraron los viales de uno de los experimentos más famosos de la historia, que llevaban cincuenta años extraviados.
En 1953 el químico Stanley Müer diseñó un sistema de tubos y matraces de vidrio, en los que intentó recrear las condiciones de la Tierra hace 4.000 millones de años, para ver si aparecía «algo» cercano a la vida. Mezcló agua con metano, amoníaco e hidrógeno (los gases que supuestamente contenía la atmósfera primigenia), y aplicó descargas eléctricas para simular la gran cantidad de rayos que caían entonces sobre la superficie del planeta. A las pocas horas el matraz ya contenía diferentes tipos de aminoácidos, las moléculas que constituyen las proteínas. El hallazgo fue impactante, porque reflejaba la tremenda facilidad con que se podían formar moléculas orgánicas complejas a partir de otras mucho más sencillas, y daba una gran esperanza a la comprensión científica del origen de la vida en la Tierra. El experimento reforzaba la hipótesis de que todo empezó en una sopa prebiótica; una especie de balsas en las laderas de los volcanes donde poco a poco se iban formando moléculas, recombinándose, y aumentando el grado de complejidad hasta generar algo capaz de metabolizar energía del exterior, mantener una estructura estable y hacer copias de sí mismo.
En la actualidad, esa idea de caldo primigenio en pequeños lagos superficiales está siendo reemplazada por lugares como el interior de la Tierra o los fondos oceánicos, más propensos a mantener una actividad química que pudiera dar lugar a las primeras estructuras celulares. Además, los geólogos saben que la composición atmosférica en los albores de la Tierra era muy diferente a la que utilizó Miller en su experimento. El experimento de Miller continúa siendo un referente para todos los investigadores en el campo de la química prebiótica por su enorme valor conceptual, pero como pista válida para perseguir las primeras etapas del verdadero origen de la vida perdió toda su vigencia. De hecho, estaba olvidado, hasta que tras la muerte de Stanley Müer en mayo de 2007 uno de sus últimos colaboradores encontró una caja en su viejo laboratorio llena de botecitos etiquetados como «Experimentos de 1953-1954». Contrastando con las libretas originales de Miller, Jeffrey Bada comprobó que esos viales contenían muestras del famoso experimento, pero también de otras dos versiones desconocidas que Miller había realizado alterando ligeramente las condiciones iniciales. En una de esas versiones, Miller había inyectado vapor de agua directamente en el lugar donde mezclaba gases con descargas eléctricas. En la década de 1950 eso no tenía demasiada importancia, pero ahora recobraba interés porque sabemos que las erupciones volcánicas de la Tierra primigenia sí podían emitir gases como los que Miller había utilizado y formar nubes a su alrededor, cuya composición sí estaría acorde con las condiciones de su experimento. Miller había analizado dichas muestras, pero no con los espectrómetros tan sensibles que existen actualmente. El verano pasado Jeffrey Bada y otro científico llamado Adam Johnson volvieron a analizar las muestras y descubrieron hasta 22 aminoácidos en la versión ignorada por Miller, el doble de los que él había anunciado anteriormente. Además, 20 de los aminoácidos coincidían con los que constituyen las proteínas de los seres vivos. Es decir, el experimento publicado por Miller había perdido validez porque las condiciones que utilizó no eran fieles a la atmósfera primitiva, pero sin él saberlo había realizado otro que sí reproducía bien cómo podían ser las nubes cercanas a los volcanes, y además contenía muchos más aminoácidos de los que él había podido detectar.
Más allá de la anécdota, resulta curioso que estas investigaciones se enmarquen en el campo del origen de la vida, pues si algo ponen de manifiesto es lo tremendamente fácil que resulta la aparición de aminoácidos y otras moléculas orgánicas en casi cualquier condición. La Tierra debía de estar llena de ellas. El origen de la pre-vida no parece muy misterioso. El gran reto a solucionar en la comprensión científica del origen de la vida es saber cómo los primeros aminoácidos, lípidos o ácidos nucleicos llegaron a constituir proteínas que tuvieran capacidad catalítica, o material genético que codificara información, en qué orden, y cómo pudieron llegar a ensamblarse en algo tan complejo como es una célula. Aquí es donde se encuentran las investigaciones más apasionantes.
¿Qué fue antes?, ¿el gen o la proteína?, ¿o quizá lo más fundamental fue la aparición de una membrana lipídica que facilitara una estructura, un espacio cerrado donde se combinaban tales moléculas? ¿Es más importante el metabolismo (un ciclo químico que permita el intercambio de energía) o la información (genes)? Mucho antes de la llegada del ADN, ¿hubo un mundo previo de ARN, molécula que también puede codificar información y al mismo tiempo tiene capacidad catalítica? Éstas son las grandes preguntas que se han de resolver si queremos comprender el misterio del origen de la vida. El experimento que se llevaría el gran premio sería aquél que, en lugar de meter metano, hidrógeno y amoníaco en un matraz, y comprobar que se forman aminoácidos o nucleótidos, pusiera nucleótidos, lípidos, aminoácidos, y saliera una proteína catalizando reacciones orgánicas dentro de una protocélula. Eso sí que sería espectacular. ¡Pero no tan descabellado!, porque por sorprendente que parezca, la vida en la Tierra se originó muy pronto tras la formación del planeta. Incluso, según algunos científicos, la generación de vida no es un proceso tan complicado. Todavía recuerdo un seminario en nuestro Fellowship del MIT del biólogo evolutivo Charles Marshall, cuando nos dijo algo parecido a «la formación de las primeras bacterias no es el paso más insólito de la evolución. A los pocos millones de años ya había seres unicelulares sobre la Tierra, probablemente la vida apareció y desapareció varias veces hasta que cierto tipo prosperó. Y seguro que hay formas de vida simples en otros planetas. En cambio, costó 2.000 millones de años que esos microorganismos se agruparan formando seres pluricelulares. Ése es el paso verdaderamente más relevante, inesperado, y quizá único». Es decir, el origen de la primera célula viva continuará siendo un misterio, porque es algo tan relativamente fácil que nunca sabremos cuál de las múltiples opciones fue la real. Ampliemos nuestra curiosidad; hay saltos en la evolución mucho más peliagudos que el propio origen de la vida.
2.7. Los extremos de la vida en Yellowstone
Otra manera que tienen los científicos de investigar el origen y posibles características de las primeras células bacterianas es ir a los lugares de la Tierra cuyos ambientes extremos podrían coincidir con algunas etapas de la formación del planeta. Hay microbiólogos cazando organismos extremófilos (seres que viven en ambientes con condiciones físicas o geoquímicas verdaderamente extremas) por todo el mundo. En Huelva se estudian los adaptados a las aguas ácidas y cargadas de metales pesados del río Tinto, mientras que en otros rincones del planeta se investigan microorganismos que no crecen si no es a un pH tremendamente básico, o resistiendo radiaciones ionizantes que a nosotros nos destruirían, o a 80 °C bajo cero, o en fuentes hidrotermales superando los 110 °C. Si viajas con tiempo a Estados Unidos, no debes perderte los extremófilos del maravilloso parque de Yellowstone.
De verdad, si tienes la oportunidad de recorrer las montañas y lagos de Yellowstone, te quedarás prendado de su belleza paisajística, su diversidad orográfica, sus colores, y su vida salvaje. En un solo día afortunado puedes ver osos, zorros, coyotes, ciervos, castores, marmotas, alces, y quizá encontrarte de golpe una manada de bisontes paseando al lado de la carretera. Pero no te quedes sólo con esta belleza visual y macroscópica; la puedes multiplicar si le añades un mínimo interés científico por la microbiología y la geología.
Yellowstone es un volcán. Todo lo que verás en ese parque nacional fundado en 1872 (el primero de la historia) es fruto de la erupción de un volcán cuya caldera mide 65 kilómetros de diámetro. De hecho, se trata de un volcán atípico, pues no se encuentra entre placas tectónicas sino encima de una enorme bolsa de magma (hotspot) que todavía lo mantiene activo. Prueba de ello es que cuenta con la mayor concentración del mundo de géiseres, fuentes termales y unas calderas de barro burbujeante llamadas mudpots. Para los centenares de científicos que realizan estudios en el parque, éste es uno de los lugares geológicamente más dinámicos de la Tierra.
En medio de la entrevista, la vulcanóloga Cheryl Jaworowski cogió una roca y me pidió que saliéramos del edificio. Se situó en un punto determinado y me dijo: «Esta banda grisácea más intensa en la piedra son restos de la tercera gran erupción en Yellowstone. Ocurrió hace 640.000 años y fue la responsable de la forma actual del parque. La línea de rocas que ves en la cima del monte a mi espalda son restos de la erupción de hace 2,1 millones de años. Fue la primera en Yellowstone y una de las más grandes que nunca ha ocurrido en la Tierra. Si te giras 90 grados, puedes observar rocas de hace 100 millones de años, del Cretáceo. Las tenemos a la vista gracias a que la actividad volcánica las trajo a la superficie. Giras 90 grados más y ves el pico Bunsen. Esa montaña está formada con las entrañas de un volcán diferente, hace 50 millones de años. Enfrente del pico, esa colina se originó por el deshielo de un glaciar hace 40.000 años. Y si vuelves a girar 90 grados, ahí puedes distinguir las fuentes termales causadas por la actividad actual del volcán. Si quieres podemos discutir nuestras investigaciones y detalles más abstractos sobre la historia geológica de Yellowstone y las teorías acerca del hotspot. Pero, a veces, simplemente poder apreciar lo que tenemos a nuestro alrededor ya resulta fascinante». No podía estar más de acuerdo.
Subes una colina y descubres una descomunal balsa humeante de colores intensos que te deja boquiabierto. Es precioso, pero entender su formación y el origen de sus colores añade una nueva capa de esplendor al espectáculo visual: el agua del deshielo o la lluvia se filtra por el subsuelo del parque, si bien a cierta profundidad se encuentra con el magma subterráneo del volcán y empieza a calentarse. Entonces busca caminos por los que regresar a la superficie. Si encuentra una grieta relativamente despejada, forma unas fuentes termales llamadas hot-springs, por las que el agua cargada de minerales emana a temperaturas superiores a 70 °C. Esas condiciones resultan ideales para ciertos microorganismos termófilos encantados de vivir en un entorno tan extremo. Los tonos amarillos, anaranjados y marrones que rodean la fuente termal son colonias de bacterias de gran interés científico. Algunas como las cianobacterias son parecidas a los primeros organismos fotosintéticos que oxigenaron la Tierra hace más de 2.000 millones de años, y otras como el Termophilus aquaticus descubierto en Yellowstone revolucionó la biología molecular cuando se empezó a utilizar para amplificar fragmentos de ADN con una técnica llamada PCR.
Pero otro tipo de formación que te puedes encontrar son los mudpots, emanaciones formadas por un barro espeso tan ácido que derretiría tu carne si lo tocaras. Para los científicos fue una inverosímil sorpresa descubrir que un pH de 1,5 podía albergar alguna forma de vida. Pero, sobre todo, constatar que bacterias y arqueas (los organismos más extremófilos que existen) eran las responsables de dicha acidez: el volcán emite sulfuro de hidrógeno por los mudpots. Allí, ciertos microorganismos utilizan este gas como fuente de energía y lo transforman en ácido sulfúrico, que derrite la roca y crea ese aspecto fangoso. Lástima que ni por escrito ni por internet se pueda transmitir el intenso olor que se respiraba en la zona.
Sí que se podría haber grabado el rugido de los géiseres antes de explotar. En algunas ocasiones el agua caliente se acumula en balsas subterráneas. Si además la vía de escape es muy estrecha, cuando la presión pasa de cierto valor se libera de golpe, creando un géiser. Es espectacular. En Yellowstone está el géiser más alto del mundo, que explota cada hora y que puede alcanzar los 50 metros de altura. Pero si os soy sincero, me impresionó más las capas de microorganismos a su alrededor. Para algunos científicos son una ventana al pasado más remoto de la Tierra. Además, forman unas comunidades llamadas tapetes microbianos, que constituyen un verdadero micro ecosistema. Una capa de bacterias superficial utiliza la luz para hacer fotosíntesis, por debajo otra capa vive sin oxígeno y se alimenta de los subproductos que los primeros generan Y así a diferentes niveles de profundidad. Viajar y conocer mundo es fabuloso; si además vas equipado con las gafas de la curiosidad científica, la satisfacción resulta ya desbordante.
§3. Reflexiones inesperadas
3.1. ¿Tienes espíritu de perro o de lobo?
La política del Parque Nacional de Yellowstone respecto a los lobos a principios del siglo XX era clara: matarlos a todos. Eran un incordio para los ganaderos y una supuesta amenaza para la población. Fueron definitivamente exterminados a mediados de la década de 1930, tal cual. Más tarde, cuando el lobo fue catalogado como especie amenazada de extinción, surgió entre las autoridades estadounidenses la idea de repoblar Yellowstone. Bajo la supervisión de Douglas Smith, uno de los principales biólogos de lobos que existen, en 1995 se reintrodujeron en el parque 31 ejemplares originales de Canadá. Ahora constituyen una población estable y completamente recuperada de casi 200 individuos.
Douglas Smith ha estado siguiéndolos y estudiándolos durante todo este tiempo. «Lo mío no es un trabajo, sino un estilo de vida. Estudiar lobos es una fascinación científica y personal», me dijo durante nuestro encuentro en el parque. A pesar del aspecto feroz y encarnizado de los lobos, Dough aseguró que lo más sorprendente es cómo cuidan y educan a las crías. «Son los mejores padres que existen, mejores que yo mismo. Y tienen un sistema de enseñanza muy sofisticado». Cuando le pregunté por los motivos últimos tras la preservación de los lobos en Yellowstone habló de ética: «No tenemos ningún derecho a ser la especie dominante y eliminar lo que nos moleste», y de su valor en el ecosistema: «Yellowstone ahora tiene una fauna más equilibrada. Los alces eran la especie dominante con diferencia. Con la introducción de los lobos, su número se ha reducido, y esto ha permitido la proliferación de otros animales. Ahora el entorno es más rico y diverso».
Pasar la mañana con Douglas Smith hablando de lobos fue un rascar donde no pica interesantísimo, pero verlos por la tarde acompañando al ranger Rick McIntyre durante su exploración diaria, una experiencia memorable. Rick llevaba treinta y cinco años siguiendo lobos, primero en Alaska y luego en Yellowstone. Lo que más le impacta es también la combinación entre extrema amistad dentro del grupo, y la ferocidad con los invasores. «Son como un equipo de fútbol —dice—. Forman grupos muy bien cohesionados. Se cuidan muchísimo entre ellos, cooperan con fines comunes… y defienden su territorio con una agresividad brutal contra otros grupos. Su mayor causa de mortalidad es por ataques propios». Rick todavía se siente perplejo con la conducta social tan elaborada que tienen «Esta misma mañana una manada aceptó a un individuo que venía de un clan diferente. Pero ese mismo grupo había matado a un intruso dos meses antes. Queremos entender por qué aceptan a algunos foráneos y matan a otros». Rick observa muchas similitudes entre el comportamiento de los lobos y los humanos. Pero, sobre todo, cuenta historias.
Historia N° 1: La ternura de Wolf-21
«El lobo más famoso que tuvimos en Yellowstone se llamaba Wolf-21. Era un macho alfa enorme, el lobo más fuerte del parque. Era un cazador excelente, y podía luchar contra varios lobos a la vez. Un día, él solo derrotó a cinco lobos que intentaban invadir su territorio. Pero cuando estaba con su familia y luchaba con sus hijos u otros machos del grupo, fingía que lo derrotaban. Se dejaba ganar como forma de aprendizaje y cohesión social. Era tan poderoso que no necesitaba imponer su respeto».
Historia N° 2: Rebelión en la granja
«Por otra parte, varios años atrás teníamos a una hembra alfa muy agresiva con el resto de las hembras del grupo. Era extremada e innecesariamente agresiva, incluso con su madre y sus hermanas. Pensamos que era porque llegó a ser una hembra alfa muy joven, y sentía cierta inseguridad en su posición, pero quién sabe. El hecho es que al ser una hembra alfa las otras se mantenían sumisas y no se rebelaban contra sus injustificados ataques. Hasta un día en que su hermana se atrevió a enfrentarse a ella. Entonces sucedió algo inusitado. De repente, todas las otras hembras, que nunca habían mostrado ningún rechazo, se unieron al ataque y la mataron. Fue una reacción contra el poder injusto, una verdadera revolución».
Historia N° 3: ¿Eres perro o lobo?
Un lobo estaba pasando por malos momentos. Era invierno y hacía frío, humedad, y no había comido en bastante tiempo. Un día especialmente duro se cruzó con un perro gordito, satisfecho, y la mar de feliz, y empezaron a hablar. El lobo le preguntó cómo era que le iba tan bien, y el perro le explicó que su amo le alimentaba cada día, le llevaba al veterinario, le daba cobijo… era una vida muy confortable, «¡Deberías encontrar un amo que te cuide!», recomendó el perro al lobo. «Oye, pues sí parece buena idea. Lo voy a hacer», contestó el deteriorado lobo. Pero entonces vio algo alrededor del cuello del perro y le preguntó: « ¿Qué es eso?». «Es mi collar, donde mi amo engancha la cadena y me dirige por donde quiere. Forma parte del trato». El lobo no dudó ni un instante: «Quédate con tu amo. ¡Mi espíritu es libre! No quiero saber nada más». Y se marchó.
¿Os sentís más perros o lobos? Un apunte antes de contestar: Dough Smith explicaba orgulloso que la esperanza de vida de un lobo en Yellowstone es considerablemente alta: cuatro años. Uno de cada cinco lobos no supera el durísimo invierno en Montana, o las encarnizadas luchas entre grupos. Pero sí son libres.
3.2. No hay momento malo para hacer algo bueno
La historia que a continuación os cuento concluye con una de las reflexiones que más me ha impactado en los últimos años, y que revivo cada vez que oigo la palabra crisis, contención de gastos, y estancamiento de proyectos «no prioritarios».
El radiólogo argelino Elias Zerhouni llegó a Estados Unidos a los veinticuatro años para incorporarse a la Facultad de Medicina de la Universidad Johns Hopkins. Su carrera ascendente le llevó a ser vicerrector de dicha universidad y miembro de diversos comités científicos estadounidenses, hasta que en 2002 George W. Bush le nombró director de los Institutos Nacionales de la Salud (NIH), la institución del gobierno de Estados Unidos encargada de gestionar los más de 30.000 millones de dólares que se dedican a la investigación científica en biomedicina.
Uno de los primeros proyectos que planteó Elias Zerhouni al poco tiempo de llegar a los NIH fue el Roadmap, una ambiciosa e innovadora iniciativa que pretendía crear herramientas para modernizar el sistema de investigación básica, acelerar su transición hacia terapias para pacientes, financiar proyectos pioneros, y estimular la creación de nuevos modelos de grupos de trabajo y formas de investigación. En definitiva, se trataba de rediseñar ciertos aspectos de la investigación clínica y adaptarlos a los recientes cambios de la biomedicina Parecía un gran plan, pero encontró cierta resistencia.
Los temores llegaban por el desequilibrio que podían provocar los altibajos presupuestarios de los NIH: durante la época de Bill Clinton se aprobó un plan para doblar el presupuesto de los NIH entre 1997 y 2003. Este empuje económico hizo que se crearan nuevos grupos de investigación, se contratara más personal, se empezaran a financiar nuevos proyectos, una estructura que con la llegada del presidente Bush, la guerra de Irak y los recortes presupuestarios, iba a ser difícil de mantener. En esos momentos todo indicaba (y así ocurrió) que a partir de 2003 el presupuesto de los NIH iba a ser plano: tras haberse duplicado durante un período de seis años, no se esperaba crecimiento en los siguientes. Por eso cuando Elias Zerhouni planteó su ambicioso Roadmap, a pesar de que todo el mundo lo consideró una excelente iniciativa, algunos le dijeron que no era el momento adecuado. No hizo caso y se salió con la suya, convirtiendo la implantación del Roadmap en el mayor logro conseguido durante su mandato.
En septiembre de 2008 el doctor Zerhouni anunció que iba a dejar la dirección de los NIH, en la típica renuncia previa a las elecciones de los cargos nombrados directamente por el presidente. Como trabajador de los NIH que era en esos momentos, tuve la oportunidad de asistir a la fiesta de despedida en su honor que se celebró el 30 de octubre de ese año. En ella, un conferenciante rememoró el planteamiento simple pero incontestable con el que Elias Zerhouni había convencido a todos los que albergaban dudas sobre el Roadmap. Se ve que en medio de una de las reuniones más importantes espetó la frase: «There is no wrong time to do the right thing» («No hay momento malo para hacer algo bueno»).
«No hay momento malo para hacer algo bueno». «No hay momento malo para hacer algo bueno», una máxima solemne y aplicable en un sentido tan amplio, incluso en el ámbito personal, que merece la pena transmitirla intacta para la libre reflexión.
3.3. ¿Cómo vamos a parar? ¡Es excitante!
Estábamos David y yo un domingo de enero de 2009 en la terraza del bar Marvin’s, intercambiamos miradas con un grupo de tres chicas, y decidimos no tardar en acercarnos más de esos dos minutos superados los cuales ya has perdido el efecto sorpresa y no tienes nada que hacer. En Estados Unidos, tras los saludos de rigor, y como si esto fuera lo que te define como persona, la segunda pregunta después de cuál es tu nombre siempre suele ser a qué te dedicas. Y yo, convencido de la capacidad de la ciencia para despertar todo tipo de interés, respondí que me dedicaba a escribir historias con trasfondo científico. Entonces una de las tres chicas dijo: «Pues deberías conocer a mi abuelo». « ¿Quién es tu abuelo?». «Dicen que es la persona que más merece el Nobel de los que no lo tienen». La frase sonaba prometedora, pero la que me hizo olvidar de repente la motivación inicial del encuentro fue: «Tiene noventa y seis años, y todavía acude a diario a su laboratorio de Harvard. La investigación y la biología son la pasión de su vida». Lo primero es lo primero. Luego haría caso a su amiga Erin, que me miraba de reojo, pero libretita y boli en mano empecé a preguntar y tomar datos sobre qué hacía y cómo contactar con ese personaje que, en palabras de su nieta, había descubierto «algo» muy importante sobre el ADN.

Aprovechando un viaje a Boston, a las dos semanas estaba sentado frente a Paul Zamecnik en su despacho del Massachusetts General Hospital, y ya había averiguado que era uno de los biólogos moleculares más reconocidos del siglo XX por haber sido el codescubridor del ARN de transferencia a finales de la década de 1950 y haber propuesto en la de 1970 algo llamado terapia anti sentido: si sabes que hay un gen defectuoso, puedes inactivarlo diseñando una molécula de ARN que se enganche específicamente al ARN mensajero producido por dicho gen, y bloquearlo. Inicialmente su idea fue acogida con escepticismo, pero en la actualidad ya hay varios fármacos inspirados en este concepto.
Pero al tener frente a mí a un investigador que ya había cumplido los cuarenta cuando Watson y Crick descubrieron la estructura del ADN, mi interés inicial se dirigía a preguntarle cómo vivió él esa revolución Entonces se levantó, cogió el clásico libro The Eighth Doy of Creation sobre la historia de la biología molecular en las trepidantes décadas de 1960 y 1970, y me hizo leer un párrafo en el que él mismo relataba su encuentro con James Watson en verano de 1954: «Miré la joven cara del doctor Watson por encima de su jersey blanco irlandés, después a su modelo de ADN de doble cadena, y le pregunté cómo las instrucciones del ADN se transformaban en una secuencia de proteínas. ¿Se copiaban directamente como si fuera una plantilla?, ¿o servía para generar un ARN? Lo segundo parecía probable, pero no teníamos ninguna respuesta. ¿Cómo se desenrollaba esta complicada doble hélice? Watson sonrió mostrando inseguridad. Existía un abismo entre el ADN y la síntesis de proteínas».
Recalcó que justo ése era el gran misterio de la época, y fue su propia obsesión científica, que pocos años después contribuiría a cerrar con el descubrimiento de una molécula llamada ARN de transferencia (ARNt), cuya misión es transportar los aminoácidos a los ribosomas, los orgánulos celulares donde se fabrican las proteínas.
Estábamos hablando de ello cuando alguien llamó a la puerta y entregó a Zamecnik una caja de unos 20 x 30 centímetros. Paul Zamecnik leyó la etiqueta, y de repente exclamó: « ¡Ya han llegado!». Se giró hacia mí sonriente e ilusionado y me dijo: «Estas células son muy especiales, son células humanas de un paciente con fibrosis quística y cáncer de páncreas. ¿Sabes? De los 3.000 millones de pares de bases que tiene el genoma humano, a estas células les falta un fragmento de TTT en un gen específico. Esa mutación es la que causa el 75 por ciento de los casos de fibrosis quística. Estamos viendo si podemos repararla utilizando un ARN mensajero que inserte UUU en la cadena complementaria, y luego las sustituya por CCC con unas enzimas especiales. ¡Es un trabajo precioso!».
Me dejó impresionado. Con el tono más respetuoso que pude expresar, le pregunté qué le motivaba a seguir investigando con tal pasión a su avanzada edad. Me miró como si hubiera preguntado algo muy extraño, como si la respuesta fuera del todo obvia, y contestó entrecortado: «Bueno, es muy estimulante. Nosotros creemos que puede haber una relación entre la fibrosis quística y el cáncer de páncreas, y que quizá haya un virus implicado, nadie más está haciendo esto. Es como un misterio, y solucionarlo podría ayudar a mucha gente. Además, este campo de la biología molecular avanza a un ritmo tan frenético que siempre te mantiene expectante. Todavía recuerdo, hace ya muchos años, cuando conseguimos insertar un pedacito de gen humano en una bacteria, y más tarde en el núcleo de una célula animal. En esos momentos se acercaba la fecha de mi teórica jubilación, pero ¿¿cómo vas a parar entonces?? ¡Las posibilidades que se abrían eran excitantes!».
Qué tremendo mensaje. Paul Zamecnik falleció ocho meses después a causa de un cáncer que no logró apartarle del laboratorio hasta pocos días antes de su muerte. Escuché de nuevo la grabación de nuestra entrevista, y recogí el espíritu de sus palabras como despedida del texto que le dediqué en el blog: «Pocas cosas avanzan tan rápido a lo largo de una vida como el conocimiento científico, ¿cómo vamos a parar? ¡Es excitante!».
3.4. Algo falla…
Me entusiasman los experimentos que te hacen pensar, aquéllos que en el momento más inesperado se apoderan de tu mente y te dejan inquieto, dándole vueltas y vueltas al significado profundo de la resolución que estás tratando de asimilar. Me ocurrió en pleno segundo capítulo del libro Caos, cuando James Gleick utiliza un estudio sencillísimo realizado en la década de 1940 para ilustrar la tendencia que tenemos a mantener una visión «coherente» del mundo, y lo difícil que es advertir las excepciones que deberían forzar a replanteárnosla. Para mí fue revelador.
Unos psicólogos seleccionaron un grupo de voluntarios poco familiarizados con el juego del póquer y les encomendaron una tarea nada complicada: se les irían mostrando las cartas una a una, y ellos tendrían que nombrarlas en voz alta. Parecía simple, pero había un pequeño truco: algunas habían sido retocadas. Por ejemplo, la jota de diamantes era negra en lugar de roja, y un cuatro de picas tenía las picas rojas en lugar de negras. ¿Se darían cuenta los voluntarios de los errores, de que algo fallaba? Los investigadores observaron que cuando las cartas se pasaban muy rápido, la inmensa mayoría de los participantes no apreciaban el cambio de color: ¡As de corazones! ¡Siete de tréboles! ¡Cuatro de picas! ¡Ocho de diamantes!, todo parecía normal; una tarea bastante sencilla. Si las cartas se pasaban un poco más lento, algunos voluntarios decían percibir algo extraño, pero no tenían tiempo suficiente para reflexionar e identificar dónde estaba el «error». Simplemente se quedaban un poco mosqueados. Pero cuando las cartas se mostraban muy despacio, casi todos reconocían perfectamente lo que estaba ocurriendo, y decían: « ¡Oye!, este cuatro de picas debería ser negro». Se ve que alguno perdía la orientación y confesaba no estar ya seguro de si las picas eran rojas, negras o se trataba de diamantes, pero con tiempo suficiente para reflexionar, la mayoría distinguían la trampa que nadie había visto cuando las cartas se mostraban a toda velocidad.
Tras leer este experimento, pensé en lo rápido que en ocasiones pasan las cartas en nuestra vida, y me pregunté qué estaba chirriando sin que yo le prestara suficiente atención. Qué cuatro de picas rojas me estaban colando entre tanta sociedad ajetreada.
Enseguida relacioné esta reflexión con el ensayo Desobediencia civil del filósofo Henry David Thoreau, cuyo pueblo natal en Nueva Inglaterra había visitado pocas semanas antes. Thoreau escribió Desobediencia civil tras pasar una noche en la cárcel por negarse a pagar los impuestos. No lo hizo por mezquindad, sino como un acto de rebeldía frente a la guerra de Estados Unidos contra México, y plenamente convencido de que su libertad individual de no participar de ninguna manera en ella debía estar por encima de cualquier imposición del gobierno. El texto de Thoreau es un alegato al inconformismo social, a la desobediencia, a la crítica, a la reivindicación de unos principios propios y, en definitiva, a manifestarse activamente contra aquello que no encaja al observar con detenimiento el paso de las cartas en nuestra vida.
Cualquiera que tenga una mentalidad verdaderamente científica, debe sentirse inspirado por esta actitud irreverente y beligerante de Thoreau, ya que el cuestionamiento constante del conocimiento establecido es lo que ha propiciado las grandes revoluciones intelectuales de la historia.
El gran filósofo de la ciencia Thomas Kuhn utilizó el ejemplo de las cartas para analizar cómo reaccionan los científicos al encontrar excepciones e incongruencias en sus experimentos. Kuhn escribió: «En condiciones normales el investigador no es un innovador, sino una persona que soluciona puzzles, y los puzzles en los que se concentra son sólo aquéllos que puede plantear y resolver dentro de la tradición científica existente». Kuhn se refiere a que el científico suele hacer experimentos para intentar demostrar una hipótesis que ya tiene en mente, y si cierto resultado no termina de cuadrar, resulta más habitual presumir un pequeño error metodológico en lugar de cuestionar todo el consenso que lo envuelve. Un cuatro de picas rojo puede pasar inadvertido, o ser visto como un error desconocido irrelevante; pero también como la valiente prueba de que algo falla y que quizá la asunción universal «las picas son negras» es completamente errónea. De esta rebelión ante el paradigma establecido es de donde emanan las verdaderas revoluciones científicas. Sin ella, Einstein nunca hubiera demostrado que el tiempo no siempre pasaba igual de rápido.
Desde finales del siglo XIX algunos aspectos de la física de Newton no encajaban con la electrodinámica de Maxwell. Algo fallaba, pero, sin embargo, ambas se asumían como correctas; terminarlas de encajar era sólo cuestión de tiempo y mejores experimentos. El problema se prolongó hasta que alguien tomó la descarada actitud de pensar que si no concordaban, una de las dos debía estar por fuerza equivocada. «Newton, perdóname», dijo Einstein cuando demostró que el hasta entonces mejor físico de toda la historia estaba equivocado. Einstein transformó nuestra visión del mundo con su teoría de la relatividad gracias a no desmerecer los cuatro de picas rojos.
Como en el primer caso del experimento de las picas rojas, hay situaciones en las que las cartas de la vida nos pasan volando y ni siquiera percibimos que algo en ellas no termina de encajar. Otras veces nos ocurre como en la segunda prueba, cuando las cartas pasan ligeramente menos rápido: vamos siguiendo la inercia y comportándonos como se supone que debemos hacerlo, sin tiempo de meditar, pero alguna vocecita interior nos advierte de que algo chirría; ya sea en nuestra propia vida, en nuestros conocidos, en la sociedad, en las costumbres arraigadas, o en la concepción que tenemos del mundo. En esos momentos puede ser un sano ejercicio intentar ralentizar las cartas de la vida y darnos cuenta de qué nos desorienta cuando contamos con tiempo suficiente de reflexionar. Pero en ocasiones lo más costoso no es descubrir el cuatro de picas rojos, sino esforzarnos en corregir todo lo que chirría aunque nos toque ir a contracorriente y ser civilmente desobedientes. La ciencia de verdad, la revolucionaria, la valiente, no pretende confirmar experimentalmente lo que ya suponemos, sino mostrar en qué andamos equivocados. Larga vida a Thoreau, Walden, la teoría del caos y la rebeldía frente a los cuatro de picas rojos.
3.5. Enamorado por el efecto mariposa
Reconozco mi promiscuidad con los libros de ciencia. Soy muy enamoradizo, pero tras el delirio inicial raramente consigo establecer una relación estable y serena con ellos. No los leo como si fueran una novela. Me salto páginas, a veces capítulos enteros, los maltrato con lápiz e incluso bolígrafo, y tengo varios empezados al mismo tiempo. Releo la introducción y el índice varias veces para intentar asimilar la idea básica que el autor quiere transmitir; pero luego, si los capítulos se van haciendo cada vez más repetitivos y no logran mantener un alto grado de placer, los abandono sin escrúpulos.
Una vez me enamoré locamente de uno que conocí en un encuentro fortuito. Estaba ojeando la sección «libros que cualquier periodista científico debería leer» en la mini biblioteca que teníamos en la oficina del Knight Fellowship, cuando mi ex compañero Ivan Semeniuk se acercó y dijo: « ¡Caos! Qué gran libro… ¿no lo has leído? Deberías hacerlo. Es una obra de referencia». ¿Un libro sobre física del caos escrito hace más de veinte años? Lo empecé a leer con cierta reticencia, pero inmediatamente quedé prendado por el excelente contexto histórico y filosófico que le dio al renombrado efecto mariposa, y el nacimiento abrupto de toda una nueva ciencia destinada a romper de manera definitiva con las barreras entre disciplinas, la ilusión determinista de Laplace, y el reduccionismo como forma de comprender la naturaleza.
«El aleteo de una mariposa en Pekín puede generar un tornado en Nueva York».
Cuando en los años cincuenta el matemático John von Neumann diseñó los primeros ordenadores, el grupo de científicos más entusiasmado en empezar a utilizarlos fueron los meteorólogos. Estaban convencidos de que, con las leyes de la física en la mano, lo único que les faltaba para predecir con exactitud el movimiento de las nubes y saber si a la semana siguiente haría sol o estaría lluvioso era muchísimo más poder de cálculo. Este optimismo surgía de dos asunciones básicas. Una era la visión determinista de los fenómenos físicos: conociendo al detalle las posiciones y los movimientos de todos los elementos que forman parte de un sistema, y las leyes que los afectan, podemos predecir con exactitud su evolución futura. Todos los físicos sabían que en un sistema tan abierto como el clima esto era materialmente imposible. Pero tenían una segunda asunción: los detalles minúsculos tienen relevancia minúscula; un error pequeño en el cálculo inicial sólo implicaba un error pequeño en el resultado final. Al fin y al cabo, eran capaces de predecir con gran precisión el regreso del cometa Halley sin necesidad de afinar a la décima de milímetro su posición actual Dicho de otra manera, si un día invitas a tomar un café a un amigo tu economía global futura no se verá muy afectada; simplemente a final de mes tendrás un euro menos. Se sentían eufóricos; utilizando lápiz y papel, los astrónomos habían estado previendo la aparición de eclipses o tránsitos de Venus con meses de antelación, y ahora ellos, gracias a los ordenadores, iban a hacer lo mismo con las nubes. Su frustración al descubrir que esa tarea iba a convertirse en imposible dio origen a una nueva ciencia llamada teoría del caos.
Edward Lorenz fue uno de los científicos que a principios de la década de 1960 empezó a utilizar ordenadores para intentar desentrañar los misterios de la meteorología. En su despacho del MIT construía modelos matemáticos con ecuaciones en las que relacionaba temperatura, presión, velocidad del viento, humedad, y luego los probaba para ver su precisión e ir ajustando las ecuaciones. Pero un día ocurrió algo totalmente inesperado. Decidió repetir una misma predicción, y por descuido introdujo en un parámetro el valor 0,506 en lugar del 0,506127 que había escrito la primera vez Parecía un detalle insignificante, pero cuando Lorenz regresó de tomar un café y contrastó ambos gráficos que mostraban la evolución del sistema, quedó desconcertado. Las predicciones meteorológicas empezaban idénticas, pero poco a poco se iban diferenciando más y más, hasta ser completamente distintas a las pocas semanas. La alteración de unos insignificantes decimales en los valores iniciales de un sistema atmosférico alteraba de manera drástica las predicciones futuras. Edward Lorenz acababa de destrozar el sueño de sus colegas meteorólogos, al demostrar que el ligerísimo cambio provocado por el aleteo de una mariposa en Pekín podía desembocar en un evento radicalmente imprevisible como un tornado en Nueva York.
Significó un duro golpe inicial a la visión más determinista de la física. Pero la gran contribución de Lorenz no fue establecer que la naturaleza estaba rodeada de caos y desorden, sino continuar investigando hasta descubrir algo muchísimo más sorprendente: en lo más profundo de los sistemas caóticos en realidad se ocultaba cierto tipo de organización De lo más profundo del caos emergía un misterioso orden Éste fue el gran hallazgo, y el verdadero inicio de la teoría del caos, una nueva ciencia dispuesta a descubrir las leyes internas de los sistemas complejos. Lorenz y muchos otros científicos construyeron ecuaciones y herramientas matemáticas inexistentes hasta el momento, con las que se empezaron a encontrar patrones que se repetían en sistemas tan diferentes como la meteorología, la población de las especies, el funcionamiento de las células cardíacas, los mercados bursátiles, todos ellos eran sistemas en apariencia gobernados por el caos y el descontrol, pero al analizarlos detenidamente se podía comprobar que poseían cierta lógica interna y que de ellos emergían una serie de propiedades comunes. Pero emergiendo, ¿de dónde? La aparición espontánea de patrones fue otra de las grandes revoluciones conceptuales del siglo XX. Ponía de manifiesto que la interacción entre todos los constituyentes de un sistema complejo era capaz de generar novedades inexistentes de manera aislada. El todo era mucho más que la suma de las partes, y resurgió el holismo como forma de intentar comprender la naturaleza.
En la actualidad, la apasionante física de la complejidad busca el orden oculto en el caos de sistemas como internet, las interacciones entre genes, el crecimiento de las ciudades, la gestión del tráfico, el desarrollo del lenguaje, la aparición de novedades en el proceso evolutivo, el funcionamiento del cerebro, todo gracias a una ciencia que rompió las barreras entre disciplinas, la fantasía determinista de tantos físicos clásicos, y la visión reduccionista de que un sistema se puede comprender sólo analizando las partes que lo constituyen.
Todavía amo Caos, y recurro a él cuando busco revivir encuentros transgresores.
3.6. Sinfonía de la ciencia: intuiciónversusracionalización
Es un domingo a media tarde cualquiera, recibes el típico mail de un amigo enviándote un link, lo abres sin grandes expectativas gracias a que tu sabio amigo no te ha explicado su contenido, y descubres un vídeo colgado en YouTube que te deja maravillado: un montaje musical titulado «Sinfonía de la ciencia», que enlaza preciosas frases de grandes divulgadores como Sagan, Dawkins, Feynman, Greene, Hawking. A los nerds eso nos encanta; reconozco que casi me emocioné al escuchar algunas expresiones.
Reacción inmediata: compartirlo enseguida en el blog. Pero entonces pensé: «Ya ves, quizá no hay para tanto. Seguro que muchos ya lo habrán visto, éste no es el estilo del blog, no tengo ningún mensaje propio que añadir, rompe un poco la línea de las últimas semanas, siempre que se me va un poco la pinza alguien protesta, tenía pensado otros temas. Casi mejor lo twitteo, lo cuelgo en Facebook, y suficiente».
Eso hice. Pero camino del cine no dejaba de darle vueltas. Era un ejemplo clarísimo de dilema frente a la toma de decisiones; ¿debería haber hecho caso de mi primera intuición, o del posterior análisis más «racional»?
Dos autores y posiciones diferentes se cruzaban en mis pensamientos. Primero recordé a Malcolm Gladwell y su libro Inteligencia intuitiva: por qué sabemos la verdad en dos segundos. Gladwell es quien mejor ha popularizado el concepto de que debemos atender mucho más a las instrucciones dictadas automáticamente por nuestro cerebro. El subconsciente no emite juicios rápidos al tuntún, sino basados en todas las experiencias y conocimientos que ha ido acumulando durante su aprendizaje, y percepciones subliminales que a tu consciente le pueden pasar por alto. No dejes que razonamientos posteriores te líen y bloqueen. Son menos importantes. Si tienes una intuición clara sobre un campo que dominas, ¡síguela!
Pero luego recordé los estudios en economía conductual del psicólogo Dan Ariely, autor de Las trampas del deseo. En él explica los engaños sistemáticos que sufre nuestro cerebro a la hora de tomar decisiones. La tesis principal es que somos seres irracionales con tendencia a repetir una serie de errores cuando actuamos «sin pensar», guiados por engaños de nuestra percepción. Si somos capaces de reconocer esas artimañas de un cerebro no diseñado para pensar en el futuro y corregirlas, nos equivocaremos menos veces.
Ariely explica muchos efectos perniciosos, pero justo uno de esos efectos es la valoración desmesurada de algo que te ha gustado. En un estudio realizado con gente que iba en busca de pareja a un encuentro de citas rápidas, cuando luego pasaban un test para valorar las personas que les acababan de presentar, solían predecir muy positivamente los aspectos desconocidos de los candidatos que les habían gustado. Aparte de reforzar la idea de que no deberías casarte enamorado/a, quizá este mismo efecto estaba detrás de mi enamoramiento del vídeo.
De alguna forma, ambas posiciones parecían contradecirse. ¿Debería haber seguido el consejo de Gladwell y hacer caso de toda la sabiduría acumulada en mi inconsciente y que se manifestaba en forma de intuiciones?, ¿o confiar en Ariely y contemplar que mi percepción podría estar engañándome?
Hay un término medio, y menos discordancia de la imaginada. La clave es tener en cuenta si eres un experto o no en el campo de la decisión que vas a tomar. Si pudiéramos extraer una regla sería: «Si tienes mucha experiencia, sigue tu instinto. Si no, dale algunas vueltas antes de precipitarte».
Conclusión: llegué a casa por la noche —tras darle la paliza a mi acompañante, que espero no se asustara— decidido a poner a prueba si yo tenía mucho o poco conocimiento sobre mi propio blog.
Sigo sin tener respuesta a ninguna de mis inquietudes. Quizá por lo que dice Richard Feynman en la canción: que resulta más interesante tener interrogantes abiertos. Pero sobre todo porque Dan Ariely también habla de errores de precipitación en expertos con acceso a excelente información, que se dejan llevar por el pánico en los mercados bursátiles, rumores, todo ello estudiado en detalle desde la perspectiva de las finanzas conductuales.
Diría que en el caso concreto del vídeo debería haber seguido a Gladwell y colgarlo sin tanta divagación. Pero como norma general, salvo en situaciones de supervivencia y reproducción, casi me inclino más a dejar reposar los juicios rápidos. Será que, por suerte, todavía falta mucho que aprender de —como expresaba Richard Dawkins— la poesía de la realidad.
3.7. El cromosoma y de Jesucristo
Estaba buscando una forma original de felicitar la Navidad de 2009 y recordé una historia rocambolesca que había leído en el libro The Physics of Christianity de Frank Tipler, autor también del punto omega y un físico con gran prestigio académico.
Dejando de lado a los creacionistas que leen la Biblia de manera textual, la mayoría de los creyentes moderados interpretan algunos «milagros» como algo metafórico, una «manera de hablar». La separación de las aguas del Jordán pudo resultar de algún evento geológico, y la multiplicación de los panes y los peces, por ejemplo, no hace falta tomársela al pie de la letra; posiblemente no sucedió nada sobrenatural. Lo importante de verdad son las enseñanzas que contienen.
Pero algo delicado ocurre cuando pones en cuestión la virginidad de María. Ahí muchos creyentes —incluso los moderados— se resisten a admitir que se trata de una metáfora y que en realidad María no fue virgen. El gran problema desde el punto de vista científico es que no cuentan con una teoría alternativa que pudiera explicar este hecho de manera natural. Si Jesucristo hubiera sido mujer, podrías pensar que se produjo una partenogénesis (un óvulo de María duplicó su material genético y luego empezó a dividirse como si hubiera estado fecundado). Esto no es tan extraño. Ocurre en muchas especies de invertebrados, incluso en algunas lagartijas, se puede inducir en el laboratorio con óvulos de primates, y bueno, quién sabe, quizá podría haber ocurrido sin enterarnos en algún humano de manera natural, pero, en todo caso, las hijas siempre serían hembras con dos cromosomas X No hay manera alguna de que ahí aparezca un cromosoma Y que induzca la masculinidad del feto. ¿No? ¿Seguro? Frank Tipler cree que sí.
Reproduzco un fragmento que en su momento copié de su libro: «Yo propongo que Jesús era un tipo especial de macho XX. Es muy extraño en humanos, pero ha sido ampliamente estudiado. Aproximadamente, uno de cada 20.000 hombres tiene cromosomas XX. Un macho XX resulta cuando un gen clave del cromosoma Y (el SRY, que marca la masculinidad) se inserta en un cromosoma X.
»Una posibilidad es que todos los genes importantes del cromosoma Y se hubieran insertado en uno de los cromosomas X de María, pero estuvieran silenciados (existe un proceso por el cual el ARN puede silenciar un cromosoma X entero, y el otro seguir funcionando)».
Ésta es la explicación de cómo María sería mujer, pero llevaría en su carga genética los genes clave —silenciados— del cromosoma Y. Ahora llega la partenogénesis. «Jesús se engendraría cuando un óvulo de María empezara a multiplicarse antes de convertirse en haploide (dividir su material genético), y contuviera esos genes Y activados».
Increíble, ¿no? Suponiendo que la posibilidad de que un gen Y pase al X sea una de cada 20.000 ocasiones, la posibilidad de que pasen todos los importantes de golpe es ínfima. Y que encima estén silenciados y se produzca una partenogénesis que nunca ha sido observada en humanos, efectivamente se acerca más al milagro que cualquier otra cosa. Pero, según Tipler, no es imposible, y permitiría el nacimiento de un hijo varón de una mujer virgen sin recurrir a ningún proceso sobrenatural.
No me estaba mofando de un físico de prestigio como Tipler, qué va, ni insinuando que situaba su ideología por delante de su ciencia, que nadie se lo tome como una ofensa; simplemente era una propuesta inocente para ser debatida en ciertas mesas durante Nochebuena.
3.8. En el museo del creacionismo de Kentucky
Lo que ya no me hizo tanta gracia fue la visita al Museo del Creacionismo en el estado de Kentucky, muy cerca de la frontera con Indiana.
Este centro educativo visitado cada año por miles de estadounidenses te recibe con el lema «Prepárate para creer». Sabes que es lo opuesto al «Prepárate para dudar» que funciona como motor del progreso científico e ideológico, pero de todas maneras te sumerges en ese referente neurálgico de la crítica a la teoría de la evolución, abierto a —como mínimo— escuchar sin menosprecio anticipado sus argumentos.
Entras en el vestíbulo principal y lo primero que encuentras es una instalación que muestra la coexistencia de humanos con dinosaurios. Te sorprende, pero la explicación de tal aparente paradoja llega enseguida en la primera sala de exposiciones, donde al lado de un gran fósil de dinosaurio un vídeo te explica dos puntos de vista igualmente válidos:
El primero es el de un paleontólogo convencional narrándote cómo —según su interpretación— quedó enterrado este fósil hace millones de años. A continuación otro científico ofrece su irrevocable versión: «Donde Km ve millones de años, yo veo evidencias de una historia diferente. Yo también creo que este animal murió durante una inundación. Pero no fue una inundación local, sino una masiva que cubrió toda la Tierra: el Diluvio de Noé cuando Dios juzgó al mundo. Su cadáver fue sepultado de golpe, antes de poder ser descompuesto o devorado, en una capa de sedimentos que se extiende por todo el continente. Como según la Biblia dicho diluvio ocurrió hace 4.300 años, por lo tanto creo que ésta es la edad de ese fósil. Llegamos a diferentes conclusiones debido a nuestros diferentes puntos de partida. Yo empiezo con la Biblia, mi colega no. Todos tenemos los mismos hechos, simplemente los interpretamos de manera diferente».
Terminas de grabar el vídeo con tu iPhone, y un señor con cara amable te sonríe y pregunta: «Interesante, ¿no?». No intentes convencerle de que los dinosaurios se extinguieron hace 65 millones de años.
«Eso es imposible porque contradice el Génesis; algún error contendrán los datos científicos», te responde con tono muy calmado. «Claro, claro.», añade alguna de las miradas que te contemplan como si fueras un bicho raro.
Aturdido, avanzas hacia la siguiente sala, cuyo panel de entrada da en el clavo de por qué andas equivocado: «La “razón humana” pretende que nuestra mente pueda alcanzar la verdad de manera autónoma e independiente de la verdad revelada de Dios. Las filosofías y las religiones que utilizan las suposiciones humanas en lugar de la palabra de Dios como punto de partida son propensas a malinterpretar los hechos que les rodean, porque parten de arbitrariedades».
Después de tal lección de humildad, empieza el ataque contra la «razón humana» (no a la ciencia): «Según la razón humana, hay un único árbol evolutivo cuya primera forma de vida apareció hace 4.000 millones de años. Sin embargo, la palabra de Dios plantea un campo de la creación con diferentes árboles cuyo inicio fue aproximadamente 6.000 años atrás. Según la razón, los humanos y los primates tenemos un antepasado común, pero la palabra de Dios deja claro que su origen fue separado».
Y lo mismo con el universo: olvídate de sus 13.700 millones de años de historia. Sólo tiene escasos miles. Y que Descartes no te confunda con su peligroso «Pienso, luego existo». Tú eres lo que eres. Porque, además, la palabra de Dios es verdad: la arqueología ha confirmado repetidamente que los detalles históricos de la Biblia son ciertos, y cientos de profecías se han cumplido, mientras que ni una sola ha fallado.
Te quedas estupefacto. Pero consciente de que los creacionistas argumentan que la suya es una teoría con base científica, y como tal piden que sea enseñada junto a la evolución en las clases de biología de los institutos estadounidenses, continué la visita esperando encontrar argumentos científicos que avalaran sus afirmaciones.
No hubo éxito. Las salas posteriores se dedicaban a explicar el Génesis y cómo era el mundo en el que vivieron los primeros hombres. A título de ejemplo, todos los animales eran herbívoros antes del pecado original de Adán (la muerte no existía; podían comer plantas porque no son seres vivos según la Biblia). Curioso fue también ver cómo subían dinosaurios al arca de Noé, o a geólogos explicando la formación del cañón del Colorado hace 4.000 años tras el Diluvio Universal. Toda una explicación del funcionamiento del mundo que contrasta con la ciencia que se explica en las escuelas. Por eso, en la tienda del museo puedes encontrar materiales didácticos para educar tú mismo a tus hijos desde tu propia casa, y que sus mentes no sean corrompidas por la razón humana.
No sé qué imaginaba encontrarme en el Museo del Creacionismo. Supongo que argumentos más articulados criticando la evolución, alguna teoría alternativa que no partiera de la Biblia, y una buena exposición de los datos científicos que los creacionistas siempre aseguran que respaldan sus ideas.
A punto de desistir en dicha búsqueda y ya de regreso al vestíbulo principal, distinguí un pequeño pasillo justo al lado de la cafetería que conducía a un salón de actos. Me acerqué. Estaba cerrado, pero pude leer los carteles que colgaban en las paredes del pasillo. En uno de ellos había un listado de personas en posesión de títulos científicos que acreditaban todas las visiones expuestas en el museo. El mensaje era claro: no se trata sólo de fe, hay ciencia y científicos que avalan esa información.
Otro cartel era del Institute for Creation Research, cuya misión es utilizar la investigación científica para demostrar las evidencias de la veracidad y la precisión de los relatos bíblicos sobre la Creación y el Diluvio Universal, así como preparar programas educativos para transmitirlos en diferentes centros y medios de comunicación.
Luego había varios carteles en los que se describían algunas de esas investigaciones que supuestamente contradicen los datos de la ciencia convencional. Por ejemplo (traduzco textualmente): «En el granito puedes encontrar cristales de zirconio radiactivo que producen helio. Ese helio debería haber escapado de los cristales rápidamente, pero todavía está allí. Eso sólo se explica si la edad de los cristales y el granito es inferior a 6.000 años de antigüedad. Es cierto que esas mismas rocas muestran signos de tener 1.500 millones de años, medidos con los actuales índices de decaimiento radiactivo, pero si esos índices hubieran sido más altos en el pasado, explicaría por qué estas rocas son jóvenes».
Otro: «El carbono-14 es una forma de carbono inestable que decae rápidamente, y debería ser inexistente en rocas anteriores a 60.000 años. Sin embargo, encontramos C-14 en carbón y restos fósiles. Por lo tanto, concluimos que todo el registro fósil es joven (miles de años en lugar de millones), y todos los fósiles son de la misma edad (hecho que sería explicado por el Diluvio Universal).»
El último me pareció incluso gracioso: «Diferentes métodos de datación radiactiva difieren cuando se aplican sobre la misma roca. Por ejemplo, rocas del Gran Cañón del Colorado datadas con potasio-argón muestran una edad de 841,5 millones de años, mientras que con rubidio-estroncio, 1.060 millones. Con plomo-plomo, 1.250 millones, y según el samario-neodimio tienen 1.379 millones de años de antigüedad». El cartel no dice nada más. No hace falta; es obvio que tal incertidumbre demuestra que el método es erróneo, y el cañón del Colorado tiene una edad de unos escasos 4.350 años, como sin incertidumbres afirma la Biblia.
La trampa es de escándalo. Una persona con pocos conocimientos científicos es incapaz de juzgar si esas dudas tienen sentido o no. No lo tienen en absoluto; son una verdadera calamidad. Pero la sensación de incertidumbre ya ha cuajado.
Eso es lo que vi en el Museo del Creacionismo de Kentucky junto a centenares de otros visitantes. Muchísimo más extremo de lo que me había imaginado. Y, sin duda, algo que se escapa por completo a la razón humana.
3.9. Aquiles, la tortuga, elC. Elegansy las neuronas de colores
Ideas. Provocaciones. Conceptos que te hacen reflexionar, dudar, replantearte asunciones. Pensar. Estímulos. Éste es uno de los regalos que te ofrece la ciencia. Haces un viaje relámpago a Boston por temas laborales, visitas las oficinas del programa de periodismo científico del MIT que te acogió durante diez meses, y te comentan que por la tarde pasarán dos horas en el laboratorio del neurocientífico Jeff Lichtman Imposible rechazar tal invitación. Aprietas todavía más tu agenda, y acudes escopetado. Tu mente no está todo lo centrada que desearías, pero se despierta de golpe cuando al final de su exposición, un neurocientífico de la talla de Lichtman espeta: «No estoy tan seguro de que el cerebro del gusano C. elegans sea más simple que el nuestro». Suspense.
Jeff Lichtman es el padre de la novedosa metodología brainbow, que en noviembre de 2007 invadió todas las portadas de las revistas científicas por la nueva forma que ofrecía de observar el cerebro. Creando ratones transgénicos cuyas neuronas expresaban de manera estocástica diferentes combinaciones de la proteína fluorescente verde, la roja y la azul, consiguieron imágenes microscópicas de cerebros con neuronas individuales coloreadas al azar en una gama de 90 tonalidades diferentes. Las imágenes obtenidas con el método brainbow no sólo eran preciosas; olían a revolución. Santiago Ramón y Cajal transformó la neurobiología gracias a su intuición y obcecación, pero posibilitado sobre todo por la tinción de Golgi, que le permitió ver neuronas individuales en un grado de detalle que nunca antes nadie había observado. La técnica desarrollada por el equipo de Lichtman podría suponer algo parecido en el estudio anatómico del cerebro. Permite diferenciar neuronas vecinas con gran precisión y, además, perseguirlas de manera individual por todo el entramado cerebral distinguiendo cómo se conectan unas con otras. Uno de los campos más activos en la neurociencia actual es esta «conectómica», el estudio de cómo se forman los circuitos neuronales, cómo fluye la información a través de ellos, cómo enlazan diferentes áreas del cerebro, y cómo se ven alteradas en caso de enfermedad. El brainbow es una herramienta que promete mapear el cerebro y desentrañar el cableado que forman todas sus conexiones sinápticas.
Es poderosísima, sin duda, pero también tiene sus críticos. Los neurocientíficos más rigurosos apuntan que esta metodología no permite hacer experimentos, sólo «observa» cómo se conectan fragmentos de cerebro y saca conclusiones que no pueden ser probadas experimentalmente. Cuando uno de los asistentes al seminario se lo recordó, Lichtman contestó con cierta sorna: «Quizá tampoco el Hubble o la arqueología son de gran utilidad, porque sólo observan e interpretan sin hacer hipótesis testables». Otro compañero insistió: «Mi cerebro debe de estar conectado de manera diferente al suyo. ¿No es esto una gran limitación?». «Puede ser, pero no lo sabemos todavía. Lo que aquí tenemos es una nueva manera de ver el cerebro. Quién sabe qué nos mostrará».
Luego llegó la pregunta «¿Por qué utilizáis un cerebro tan complejo como el del ratón y no empezáis por uno simple como el del gusano C. elegans?.» Lichtman explicó que el mapa neuronal del C. elegans ya está realizado, y que a él le interesa estudiar cerebros parecidos al humano. Pero enseguida frunció el ceño y añadió con tono reflexivo: «Además, sin duda es más pequeño, pero no estoy tan seguro de que el cerebro de este nematodo sea más simple». Caras de escepticismo generalizadas entre la decena de asistentes. Las ideas que mayor rechazo inicial generan suelen ser las malas, y las muy buenas.
El argumento que dejó entrever Lichtman para justificar su frase fue de lo más llamativo: las 302 neuronas del C. elegans llevan millones de años haciendo su función; por lo tanto, este sistema podría ser más robusto y esconder un mayor grado de especialización y solidez evolutiva. Sólo 302 neuronas conectadas entre sí son capaces de gestionar toda la gama de complejísimos procesos que permiten sobrevivir a este organismo. Esto no es algo simple, para nada. Quizá podríamos considerarlo más eficiente que nuestro enorme pero tan desbaratado cerebro.
Aquiles y la tortuga
También pensé, como me imagino que muchos de vosotros, «demasiado rebuscado». Resulta obvio que el cerebro humano es más complejo que el de un gusano, ¿a qué viene ahora esa disquisición que no aporta ningún progreso tangible? ¡Qué tontería!, ¿no? Puede. Pero te deja pensativo, y eso es maravilloso, un regalo intelectual.
Dos días antes había ido al cine a ver la última película de Takeshi Kitano Aquilesy la tortuga. ¿Habéis oído hablar de la paradoja de Aquiles y la tortuga? El filósofo griego Zenón imaginó una hipotética carrera entre un veloz Aquiles y una lenta tortuga. Consciente de su superioridad, Aquiles ofrecía una distancia de ventaja a la tortuga. Al darse la salida salía raudo hacia ella, pero cuando llegaba al punto donde estaba la tortuga, ésta ya se había desplazado cierta distancia. Aquiles continuaba persiguiéndola, pero siempre que llegaba donde estaba la tortuga, ésta ya había avanzado un poco más. Al final, Aquiles no era capaz de alcanzar a la tortuga. Lo sé, no tiene ningún sentido. Es evidente que este planteamiento es engañoso y en una situación real Aquiles alcanza sin ningún esfuerzo a la tortuga. No intento despistaros. Efectivamente, la historia elucubrada por Zenón no es ninguna paradoja, y cualquiera que corra más rápido tras un objeto más lento terminará alcanzándolo. Sin embargo, esta «absurda» paradoja y otras formulaciones más modernas en las que Aquiles siempre recorre la mitad de la distancia que le separa de la tortuga y, aunque se acerca, nunca consigue atraparla porque siempre le falta la diminuta mitad, ha inspirado a matemáticos y físicos para desarrollar teorías de series infinitas, sumatorios de fracciones, y otras herramientas matemáticas, que además de demostrar que las paradojas de Zenón son falsas, estimulan su imaginación para plantear nuevas reflexiones y preguntas que abordar científicamente. Como la especulación sobre la simplicidad o no del cerebro del C. elegans.
Pero ¿y si, como hace la película Aquiles y la tortuga de Kitano, dejamos la realidad a un lado y permitimos que estas cavilaciones nos estimulen otras maneras de pensar? Me imaginé a la tortuga como si fuera uno de esos sueños que persigues, y cuando crees que los has alcanzado, ves que se han desplazado ligeramente. Vuelves a correr hacia él, a perseguir la meta que cumplirá tus expectativas, pero cuando llegas a tu objetivo, el sueño se ha vuelto a alejar. Quizá es en esa búsqueda inquieta y constante donde radica el sueño en sí, y permite que no se desvanezca inmediatamente tras conseguirlo. Ideas sueltas. Asociaciones libres. Al final bien podría ser que las 302 neuronas del C. elegans formaran una red más robusta que las nuestras, o que la realidad sí contuviera algún subterfugio en el que ubicar la paradoja de Aquiles y la tortuga. Como me había dicho la dulce F. P. días antes conversando sobre las triquiñuelas de nuestra existencia: «La vida es una película».
3.10. Piensa como un científico, no como un abogado
M L. es una abogada española especializada en derecho corporativo que ejerce en un bufete de Washington D. C. No le gusta su trabajo, pero a sus veintisiete años y recién salida del máster gana el doble que un investigador posdoctoral con cinco años más de experiencia. ¿Por qué cobra M. L. tanto dinero? Porque hace ahorrar todavía más a los clientes que la contratan. ¿Quiénes son sus clientes? «Empresas que han sido demandadas», me cuenta en la terraza del restaurante Jack’s de la calle Diecisiete con la calle P. ¿Un ejemplo? «Ahora estoy trabajando en un caso para Microsoft».
Entonces se me ocurre una pregunta absurda, insustancial, y totalmente fuera de lugar: «Pero ¿lleva razón la empresa?, es decir, ¿merece ser defendida?». «¡Hombre! todo el mundo tiene derecho a una defensa. Pero en la mayoría de las ocasiones razón no tienen, claro. Por eso vienen a nosotros; para que logremos que terminen pagando lo menos posible». Y de este ahorro sale el copioso salario de mi amiga. Lógico, ¿no? Sí, pero perverso a la vez.
El trasfondo de esa respuesta me dejó pensativo durante días. No exagero. Había algo que chirriaba en un planteamiento tan común y asimilado como el de M. L. Dicho en palabras mordaces, su trabajo como abogada era buscar la manera más eficaz de presentar la realidad decantada lo máximo posible a los intereses de su cliente; encontrar como fuera argumentos favorables y desatender o revocar los contrarios, independientemente de cuáles se acercaran más a una «verdad» que siempre era relativa. Para alguien con alma científica, esto era una aberración. Lejos de insinuar una pureza inexistente en el mundo de la ciencia, entre muchos investigadores sí se manifiesta un deseo de descubrir y comunicar «la realidad» de la manera más objetiva posible. Y para ello, una parte del método seguido era completamente antagónico al que había entrevisto en la profesión de mi amiga. Como abogada, ella partía de una posición predeterminada, la que más beneficiaba a su cliente, buscaba sólo pruebas que lo defendieran, y si averiguaba algo que le perjudicaba no dudaba en ocultarlo. «Lo que no está en los autos, no está en el mundo», aprendían en la Facultad de Derecho. Porque claro, «hay dos verdades, la real y la del caso», decía otra de sus frases míticas. En su profesión la objetividad no es una de sus obligaciones, todo lo contrario; su misión es ser parcial y defender a su cliente.
No quiero pecar de simplista. La frase «Lo que no está en el artículo científico, no está en el mundo» podría aplicarse asimismo ante muchos investigadores defendiendo a capa y espada sus resultados, pero sí es cierto que la metodología científica deja menos margen a la interpretación subjetiva. El investigador también empieza con una hipótesis en la que confía e intentará defender, pero luego hace experimentos para comprobar si es acertada o no. Y, en teoría, si encuentra pruebas que la contradicen, la descarta muy a su pesar. Evidentemente, le cuesta aceptarlo, y es capaz de repetir experimentos hasta la desesperación para ver si encuentra algún resquicio o condiciones específicas en que se cumpla. Pero si nada funciona, deja de defenderla. Los científicos pueden ser muy tozudos, pero sus conversaciones suelen ser cortas si existen datos de por medio.
Estoy caricaturizando las categorías de «científico» y «abogado» como si fueran estancas. Por supuesto que no lo son y, más allá de las respectivas profesiones, las utilizo como un ejercicio mental para ilustrar dos esferas de razonamiento diferentes en nuestra vida cotidiana.
Todos tenemos parte de científicos y de abogados, pero si argumento que a alguien con mayor mentalidad científica le cuesta menos escuchar, cambiar de opinión, llegar a acuerdos, o emitir juicios más objetivos que a otro con mentalidad de abogado. Estarás pensando: «No se puede generalizar». Bueno, generalizar sí se puede, es lo que hace la epidemiología para encontrar relaciones entre factores ambientales y enfermedades. Lo que no se puede es particularizar a partir de la norma. Pero si lo piensas bien, la carrera libremente elegida, los años de estudio, el rodearte de cierto tipo de personas, y las tareas a que decides dedicar toda tu vida profesional, terminan definiendo más tu personalidad y la manera de relacionarte con la sociedad que haber nacido en un pueblo o una ciudad, o con padres más adinerados o menos. Y lo reconozco; a sabiendas de que las manías son algo acientífico, tras vivir una temporada en Washington D. C. rodeado de lobbies y grandes bufetes he generado cierta manía a ese pequeño subgrupo de abogados ricos que gana cantidades desorbitadas defendiendo al mejor postor. Hay algo que chirría, y mucho.
Recuerdo haber conocido en una cena a un tipo que trabajaba para el lobby farmacéutico y preguntarle en qué consistía su día a día. Respondió sin rodeos: «Mi trabajo es ir a comer o acompañar a congresistas y gente lo más influyente posible para convencerles de que tomen decisiones que nos favorezcan». Mi interpelación «Pero ¿tú en realidad qué piensas?, ¿estás siempre de acuerdo en lo que defiendes?» se saldó con un simple: «Mi trabajo y mi opinión personal son diferentes». Lo que más asusta es que percibimos dicha respuesta como algo de lo más normal.
En otra ocasión un lobbista defendía hasta tal punto las bondades de la energía nuclear que terminé diciéndole: «Oye, es imposible que todo sea positivo y no exista un único resquicio problemático». Y él —físico de alma impura— insistía e insistía con datos y más datos. Terminamos intimando, y al final le pregunté: «En caso de que el que te pagara fuera el lobby antinuclear, ¿argumentarías lo contrario?». Podéis imaginar la respuesta: «Muy a mi pesar, pero claro que sí».
Y no olvido la llamada telefónica recibida de una de las pocas personas que sabía que durante casi dos años oscuros de mi vida trabajé como técnico superior de prevención de riesgos laborales: «Pere, ¿conoces algún estudio que aporte pruebas contra el reciclaje industrial de aceites?». Recuerdo que algo me sonó muy extraño en la construcción de esa pregunta. Mi amiga economista estaba evaluando un proyecto para valorar si su institución lo financiaba o no. En su mente ya había decidido que no convenía apoyar el proyecto, porque afectaba negativamente a la salud de los trabajadores. Y buscaba evidencias para reforzarlo. Eso era lo que desconcertaba a mis neuronas: antes llegaba la conclusión, y luego la búsqueda de pruebas «a favor» o «en contra». Todo lo contrario de un razonamiento científico, en el que primero están las evidencias objetivas, y con ellas se llega posteriormente a la conclusión. Qué pocas veces actuamos así.
De nuevo, no nos parece una actitud extraña. En nuestro día a día somos mucho más abogados que científicos. La mentalidad de abogado que parte de una posición inamovible y luego busca datos para defenderla de manera intransigente es la que más se encuentra extendida entre la sociedad. Cómo vamos a intentar convencer a nuestra abuela de que su nieto no es el más bondadoso del mundo, o esperar que ante un pequeño accidente de tráfico los implicados sopesen de igual manera su percepción individual y la del otro. El pretender tener siempre la razón es algo instintivo. Al cerebro le cuesta cambiar de manera de pensar, y escuchar las razones del adversario es un signo de debilidad. Hacer de la duda una aliada no favorece el éxito inmediato.
Quizá podamos excusarnos en la selección natural y nuestro pasado evolutivo como primates sociales, pero hay un sector social al que sí podríamos exigir una incorporación progresiva de cierta mentalidad cada vez más científica: la clase política. Podría significar una revolución sin precedentes. Cuando vemos esos debates interminables de políticos entrenados para mantenerse firmes en sus ideas y desatender sistemáticamente los argumentos de su adversario, nos damos cuenta de que algo no encaja. El cerebro de los políticos abogados no está entrenado para ello, pero si se desprendieran de cierta carga ideológica y se aproximaran a la resolución de problemas desde una perspectiva más científica, argumentaran con detalles técnicos, tuvieran mayor respeto por la verdad, y en busca del bien común intentaran ponerse de acuerdo aunque tocara dar la razón a su oponente, quizá muchos conflictos se solucionarían más rápido y de manera más justa.
Pero para hacerlo posible, antes debemos empezar por nosotros mismos impregnándonos de ciertos valores y metodología científica en nuestra manera de razonar. Y por mucho que siempre haya sido así, dejar de asumir como tan normal que primero lleguen las conclusiones y luego las pruebas, en lugar de a la inversa.
§4. Nunca lo hubiera dicho…
4.1. Voluntarios por Obama: el dinero reduce la satisfacción
Sin duda, una de las noches más especiales que he vivido en Estados Unidos fue la del 4 de noviembre de 2008, celebrando la victoria de Barack Obama frente a McCain en un lugar tan representativo históricamente como el cruce de la calle U y la Catorce en Washington D. C., el epicentro de los violentos disturbios tras el asesinato de Martin Luther King en 1968. Además, tuve la enorme suerte de poder seguir esa emocionante experiencia acompañado de un grupo de voluntarios de DC for Obama, muchos de los cuales habían invertido gran cantidad de tiempo y esfuerzo sin ningún tipo de recompensa económica a cambio.
La pregunta provocadora que planteo es: si la tarea de esos voluntarios hubiera sido remunerada, ¿su dedicación habría sido más intensa o se habría alistado un número mayor de personas?
Si reflexionamos utilizando parámetros exclusivamente «racionales», la respuesta debería ser sí todo aquel convencidísimo de querer luchar de manera activa por Obama lo hará igualmente, tanto si cobra como si no. Pero, además, quizá añadiendo un pequeño incentivo económico se les sumarán algunos indecisos. En cualquier caso, cobrar podría ser también una justificación añadida para trabajar con más dedicación.
Éste sería el razonamiento utilizado si los responsables de decidir pagar o no a los voluntarios hubieran sido economistas de la corriente más neoclásica, la que asume que los humanos somos Homo economicus que calculamos «racionalmente» y de manera egoísta los beneficios y costes que derivan de nuestras decisiones. Probablemente porque ellos sí utilizarían un planteamiento analítico a la hora de valorar «objetivamente» cuántos voluntarios necesitarían, cuál sería el gasto de pagarles a todos, si valdría la pena o no.
En cambio, si le preguntamos a un psicólogo experto en el campo de la behavioral economics, «economía conductual», nos advertirá que a veces las emociones juegan un papel mucho más importante que la razón en la toma de decisiones, y que la idea del Homo economicus construida por los economistas neoclásicos es una falacia. No somos maximizadores racionales de beneficios. Introducir un premio económico puede reducir la satisfacción que sientes por tu entrega, ya que «inconscientemente» compite con los motivos intrínsecos por los que participas como voluntario. De hecho, durante un estudio realizado en Suiza observaron que los voluntarios que colaboraban sin cobrar en un proyecto determinado dedicaron más horas por semana que aquéllos a los que se les daba una pequeña cantidad de dinero.
El efecto contrario también existe: en una guardería de Israel estaban preocupados porque varios padres solían llegar tarde a recoger a sus hijos, y decidieron poner pequeñas multas simbólicas pensando que eso disminuiría los retrasos. Sorprendentemente, no sólo más padres empezaron a llegar tarde, sino que además se demoraban más tiempo. El dinero compensaba su sentimiento de culpa por tener a sus hijos esperándolos.
Porque, señores, volviendo al asunto del voluntariado, aunque algunos modelos económicos anticuados no lo predigan, la satisfacción por el altruismo sincero existe de verdad. Y si alguno todavía no se lo cree, que piense en la siguiente situación: llamas a un buen amigo para invitarle a él y a su pareja a cenar en vuestra casa, simplemente porque hace tiempo que no les ves y te apetece charlar con ellos. Acepta encantado, pero dice que te pagará 15 euros por la comida. ¿Los cogerías? ¡Claro que no!, a pesar de que «racionalmente» sí tenga sentido. Y en caso de que insistiera hasta el extremo de no poder rechazarlo porque «él se sentiría mejor así.», ¿pondrías más esmero en la elaboración de la cena? No, incluso quizá aumentaría la desidia. Podéis pensar que no es lo mismo, pero os aseguro que para los voluntarios por Obama con los que compartí la victoria demócrata no era tan diferente.
4.2. Vacunas contra la adicción
Eso sí que nunca me lo hubiera imaginado. ¿Una vacuna para la adicción al tabaco o la cocaína? ¿Cómo se entiende eso? Las vacunas actúan contra agentes infecciosos, ¿no? Como el virus del sarampión o la gripe, las bacterias que provocan la meningitis. La verdad es que cuando oí a Nora Volkow, directora del Instituto Nacional de Drogas de Estados Unidos, hablar de sus investigaciones encaminadas a conseguir vacunas contra la adicción, no me encajaba de ninguna manera. No lograba imaginarme, ni de cerca, un posible mecanismo que explicara el funcionamiento de una vacuna contra el tabaco. El primer escollo que tuve que superar para comprenderlo fue asumir que el tipo de vacunas contra agentes infecciosos que yo tenía en mente eran las convencionales, las que pones unos virus inactivos de gripe para que estimulen tu sistema inmunológico y cuando lleguen virus activos ya tengas anticuerpos específicos contra ellos esperándoles. Estas vacunas son las profilácticas, las que actúan antes de tener la enfermedad. Pero hace tiempo que se está investigando en un nuevo tipo de vacunas terapéuticas que se administrarían durante la enfermedad. La idea básica es reforzar el sistema inmunológico, estimularlo para que actúe de manera más eficiente y dirigida contra algo que en principio no actuaría. Se habla de vacunas terapéuticas para el cáncer, frente a la diabetes, o incluso contra drogas como la cocaína.
En el fondo, el concepto es sencillo: inyectas en el torrente sanguíneo moléculas de cocaína unidas a proteínas bacterianas. Esto provocará una respuesta inmune en tu cuerpo, que generará anticuerpos específicos contra ese nuevo invasor. Tú habrás diseñado el complejo de manera que las proteínas bacterianas sean el compuesto antigénico que estimule la respuesta inmune, pero los anticuerpos que se formen reconozcan a la molécula de cocaína como el lugar donde engancharse.
Entonces, si algún día consumes cocaína, los anticuerpos se acoplarán a ella impidiendo que supere la barrera hematoencefálica y llegue al cerebro. Consecuencia: no notarás los efectos de la cocaína y perderá su poder adictivo.
Maticemos: de ninguna manera se trata de vacunar a todo el mundo, sino sólo a adictos que estén en fase de rehabilitación y convencidos de intentar dejarlo. Uno de los grandes problemas durante la recuperación de los drogodependientes es que tarde o temprano llega ese día fatídico, ese momento de debilidad, o persona que les tienta, y recaen. Pero ¿qué ocurriría si en ese momento transitorio de debilidad no notaran los efectos de la droga? Pues que en principio no volverían a engancharse y podrían continuar con su terapia psicológica. Eso es lo que persigue la vacunación contra la cocaína: inmunizar contra la droga a adictos, de manera que no recaigan debido a un consumo accidental ante unas circunstancias desafortunadas.
La vacuna no quita las ganas de consumir drogas en un primer momento; eso se trata con otras terapias conductuales o farmacológicas. Lo que hace es simplemente reducir los efectos placenteros de su consumo, para quitar la motivación física de volver a tomarla.
Debo reconocer que en el fondo, cuando oí a Nora Volkow hablar de estas investigaciones, más allá del valor futuro que podían tener las vacunas contra la adicción, lo que me dejó impactado fue el propio concepto. No ocurre cada día que algo inquiete tu mente y, cuando esto pasa, quieres profundizar un poco más. Por eso, trabajando en los Institutos Nacionales de la Salud (NIH), visité a uno de los expertos en este campo: Frank Vocci.
Segunda sorpresa: cuando tras pedirle que me explicara bien los mecanismos le pregunté si estaban haciendo estudios con ratitas, me respondió: «No, no, el tema está muy avanzado. Ya estamos haciendo pruebas con humanos. La primera vacuna contra la adicción al tabaco estará disponible en un plazo de tres o cuatro años. Y para la cocaína, quizá incluso antes». No terminé de creérmelo, pero sí vi que no era una vaga idea en fase de exploración. Ya llevaban años haciendo experimentos de laboratorio con ratas y monos, en los que la vacuna reducía significativamente su dependencia a las drogas. Pero en esos momentos los ensayos clínicos con humanos ya habían empezado. Un estudio del investigador Thomas Kosten con 114 adictos a la cocaína demostró que quienes recibían la vacuna en lugar del placebo tenían el doble de posibilidades de desengancharse, y al cabo de unos meses iba a comenzar otro ensayo clínico con más de 300 adictos. «Si los resultados son positivos, puede significar la aprobación de la vacuna por la Administración de Alimentos y Fármacos», me dijo Frank Vocci.
Esto era frente a la cocaína, pero había otras en desarrollo contra la nicotina, como la llamada NicVax, que estaba preparando una empresa en colaboración con los NIH. Frank Vocci aseguró que ya estaba demostrado que era segura y funcionaba. El reto científico era mejorarla, conseguir que la vacuna generara el mayor número de anticuerpos posible. Estaban calibrando el calendario de dosis, las cantidades, las características moleculares de las proteínas utilizadas, para estimular una mayor respuesta inmune y reducir al máximo la cantidad de nicotina que llegue al cerebro. La cosa iba en serio, y más cuando a finales de 2009 tuve de nuevo la oportunidad de hablar con Nora Volkow en los NIH y preguntarle cómo avanzaba este tema. «Acabamos de publicar los resultados de un nuevo ensayo clínico, y de los pacientes que producían anticuerpos al nivel necesario para tener una respuesta terapéutica, el 30 por ciento dejaban de tomar cocaína, a diferencia del 10 por ciento de aquéllos que no fueron vacunados», contestó. Quién lo iba a decir, vacunas como un tratamiento complementario contra la adicción Aunque suscitan todo tipo de claroscuros, quizá algún día serán una herramienta inesperada para prevenir recaídas de ex adictos, ayudar a dejar las drogas, o incluso suministrarlas a poblaciones de riesgo antes de un posible consumo inicial. Posiblemente sea sólo cuestión de tiempo.
4.3. Beneficios de las pruebas de armamento nuclear
Las centenares de bombas atómicas que explotaron durante las pruebas de armamento nuclear en la década de 1950 dejaron «algo» en la atmósfera que los científicos están aprovechando para identificar cadáveres, estudiar la regeneración celular, detectar falsificaciones, o solucionar crímenes al más puro estilo CSI.
¿Os suena la técnica del carbono-14 utilizada para la datación de restos fósiles? El principio básico es el siguiente: la interacción de los rayos cósmicos con la atmósfera genera isótopos de carbono14 (átomos de C con dos neutrones de más en el núcleo). Éstos se combinan con el oxígeno para formar CO2, que se incorpora a las plantas mediante la fotosíntesis y a los animales cuando se las comen. Al final, la proporción de isótopos de C-14 respecto al carbono «normal» (C-12) en animales y plantas es la misma que existe en la atmósfera, una cantidad que se ha mantenido relativamente constante en los últimos miles de años. Pero al morir, el tejido orgánico deja de incorporar nuevos átomos de C-14. De hecho, empieza a perderlos porque el C-14 es un isótopo inestable y se va desintegrando poco a poco, a un ritmo que los científicos conocen perfectamente. Por lo tanto, si analizas la cantidad de C-14 restante en un determinado fósil, serás capaz de averiguar su edad aproximada. La sensibilidad de esta técnica sólo permite analizar muestras con una antigüedad máxima de 60.000 años, y que tengan como mínimo varios miles de años. Pero, como consecuencia de las más de 500 bombas atómicas que Estados Unidos y la Unión Soviética hicieron explotar en tierra firme durante sus pruebas nucleares en la década de 1950, los niveles de C-14 en la atmósfera se multiplicaron notablemente. Cuando en 1963 se prohibieron las pruebas nucleares en la atmósfera (continuaron haciéndose bajo tierra), los índices de C-14 empezaron a bajar de manera progresiva, encontrándose todavía ahora más altos de lo que estaban antes de las explosiones.
Hace un tiempo, unos científicos ingeniosos pensaron: si los animales y las plantas han incorporado diferentes cantidades de C-14 atmosférico durante los últimos sesenta años… ¿podríamos aprovechar esta variabilidad para algo? Vaya si lo están aprovechando.
¿Quién murió antes?
En 1992 la policía austríaca descubrió los cadáveres de dos hermanas que llevaban años fallecidas en su casa sin que nadie se hubiera enterado. Por motivos económicos y cuantiosos seguros de vida, había mucho interés en saber quién de ellas había muerto antes. Los investigadores Walter Kutschera y Eva Maria Wild tuvieron una idea: si pudieran medir la cantidad de C-14 presente en algún material orgánico de los que se renuevan constantemente y compararlo con los niveles históricos de C-14 en la atmósfera, quizá podrían averiguar el momento de su defunción. Funcionó. Kutschera y Wild concluyeron que una hermana había fallecido en 1988, y la otra en 1989.
¿Se renuevan las neuronas?
En 2001 la joven neurocientífica australiana Kirsty Spalding viajó a Suecia para investigar acerca de la formación de nuevas neuronas. Al poco tiempo su jefe se enteró del caso de las hermana austríacas y le propuso la siguiente línea de investigación: para saber si en una determinada zona del cerebro nacen nuevas neuronas o no, podemos medir la cantidad de C-14 que tienen. Si no se regeneran, habrá la misma proporción que en el momento del nacimiento, y si se forman nuevas neuronas deberíamos encontrar niveles fuertes. Kirsty pasó una temporada visitando mataderos hasta poner a punto la técnica con cerebros de caballo (necesitaba animales que vivieran bastante tiempo y tuvieran cerebros grandes). Cuando tuvo el procedimiento controlado, lo aplicó en humanos y demostró que en determinas zonas del neocórtex y del área visual no nacían nuevas neuronas en edad adulta, algo que resultaba muy difícil de averiguar con otras metodologías. Actualmente, Kirsty Spalding es una de las principales expertas en esta metodología que se sirve del C-14 originado durante las explosiones atómicas.
Identificación tras la tragedia del tsunami
El devastador tsunami de 2004 en el océano Índico mató a más de 200.000 personas, entre ellas unos 500 turistas suecos. Según el médico forense Henrik Druid, algunos de los cadáveres estaban en tal estado que no podía distinguirse siquiera si se trataba de un adolescente o de una persona mayor. La edad es un dato importantísimo en la identificación de los cuerpos, y para intentar averiguarla Henrik Druid recurrió a las técnicas de C-14 que Spalding había desarrollado en el Instituto Karolinska de Estocolmo. La tarea parecía sencilla: el esmalte de los dientes es permanente, por lo tanto averiguando la cantidad de C-14 que contenían y comparándola con los datos históricos de C-14 en la atmósfera se podía averiguar el momento en que había salido cada pieza. Se aplicó la técnica a los cuerpos todavía no identificados de seis víctimas del tsunami y se predijo su edad con un margen de error de un año. Las policías sueca y canadiense están interesadas en esta técnica como herramienta de investigación criminal Henrik Druid asegura que muy pronto oiremos hablar de casos resueltos con esta metodología. Pero el rango de aplicaciones va mucho más lejos. Un grupo australiano realizó un estudio en el que logró identificar la añada de unos vinos muy preciados embotellados entre 1958 y 1997, y científicos de los NIH la utilizan para estudiar la regeneración de las células beta pancreáticas. En California hay un grupo de investigadores que pueden saber si el marfil confiscado por la policía a vendedores ilegales provine de elefantes cazados antes o después de la prohibición de su caza, y si un cuadro supuestamente anterior a 1940 se trata en realidad de una falsificación moderna. Si el lienzo tiene niveles elevados de C-14, algo falla.
En la vertiente más científica, Spalding y su jefe Jonas Frin han desarrollado un ambicioso programa para investigar a fondo la regeneración celular en frentes tejidos humanos. Pero en ciertos experimentos les tocará apresurarse un poco. Se calcula que en 2020 los niveles atmosféricos de C-14 volverán a ser los mismos que había antes de las pruebas con armamento nuclear.
4.4 Electricidad sin cables
El investigador del MIT Marin Sojacic cuenta que una noche, cuando por enésima vez le despertó el pitido del móvil anunciando «batería baja», pensó: «¿No podría encontrar algún principio físico para lograr que el móvil se cargara solo en cuanto llegue a casa, sin necesidad de estar pendiente de enchufarlo?». Así empezó su cruzada particular hacia la electricidad sin cables.
Wireless electricity
¿Os imagináis que vuestro portátil funcionara ininterrumpidamente a través de una red eléctrica wireless? ¿O que algún mecanismo transmitiera electricidad a distancia a tu televisor, y lo pudieras poner donde quisieras sin necesidad de estar físicamente conectado a la corriente? Sí, sí que os lo imagináis. No es una idea tan extraña. De hecho, cuesta pensar que ningún ingeniero haya conseguido todavía algo que sería tan práctico. Las bases teóricas de cómo conseguirlo se conocen desde hace muchísimo tiempo, y el inventor Nikola Tesla ya lo intentó a finales del siglo XIX. Pero superada la primera década del siglo XXI, continuamos dependiendo de los cables para transmitir electricidad. Por el momento.
Algunas empresas ya han construido pequeños aparatos que utilizan ondas de radio o láser para transmitir electricidad a muy corta distancia, pero el grupo de Sojacic ha utilizado un nuevo método para conseguir algo más espectacular: encender una bombilla de 60 vatios con un dispositivo situado a dos metros de distancia. Un logro muy considerable que ya ha generado algunas patentes y llamado la atención de varias compañías. El aparato que me mostró André Kurs —el autor del trabajo publicado en Science junto con Sojacic— parecía francamente rudimentario: dos espirales de medio metro transmitiéndose campos magnéticos entre ellas.
Pero, al observar cómo terminaba encendiéndose una bombilla, me dio la sensación de estar percibiendo los estadios preliminares de una nueva tecnología que sin duda será cotidiana en el futuro. Muchas veces, cuando los científicos te presentan sus investigaciones aparece en tu mente un «quién sabe.». Pero este caso me incita a creer que dentro de unos años tendremos a nuestro alcance dispositivos que transmitan electricidad por el aire en industrias, espacios públicos, o incluso hogares.
El mecanismo: resonancia magnética
La clave del trabajo de André Kurs y Marin Sojacic es combinar el hecho de que los campos magnéticos inducen electricidad con un fenómeno físico llamado resonancia: todos los objetos tienen una frecuencia de resonancia determinada y, si consigues hacerlos vibrar a esa frecuencia específica, la energía de la vibración se amplifica considerablemente. Es lo que ocurre cuando un grito muy agudo consigue romper una copa, o en las famosas imágenes de puentes oscilando de manera inverosímil Éstos eran dos ejemplos de resonancia mecánica, pero los mismos principios se pueden aplicar al magnetismo. Se trata de construir un dispositivo que genere un campo magnético, enviarlo por el aire, y hacer que sólo resuene en el aparato receptor.
Un esquema: a un enchufe convencional le conectas un circuito (A), que transforma la corriente estándar de 60 hertzios a 10 megahertzios. Entonces la transmite a una bobina (B) que emite un campo magnético de esta misma frecuencia. A dos metros, otra bobina (C) de exactamente las mismas dimensiones recibe el campo magnético, resuena a la misma frecuencia, y por un proceso llamado inducción magnética atrapa la energía del campo e induce una corriente eléctrica que hace iluminar la bombilla (D).
André Kurs me dijo que todavía falta recorrer mucha investigación básica hasta que tenga sentido implantar esto en casas y espacios públicos, pero se mostraba absolutamente convencido de su viabilidad futura. Las primeras aplicaciones serán industriales, médicas, en sitios o circunstancias en las que resultaría muy beneficioso prescindir de cables, o incluso de baterías. Aspectos a mejorar son la distancia de alcance y la eficiencia. Es un logro que este mecanismo sólo pierda el 50 por ciento de la energía que invierte, pero con la situación energética actual únicamente puede ser coherente implantarlo a gran escala si resulta muchísimo más eficiente. Algunas voces también han mostrado cierta preocupación acerca de posibles efectos sobre la salud, y la sensación de estar dentro de un microondas. Aunque a priori no hay motivos para preocuparse, sin duda deben ser investigados.
Nos sorprendimos hace algunos años con la llegada masiva de unos teléfonos que no requerían cables. Y hace menos, cuando incluso la información por internet viajaba de manera inalámbrica. Quién sabe si algún día la electricidad emulará al mundo wireless, y dejaremos de tener esos líos de cables por debajo de los escritorios, no buscaremos desesperadamente enchufes en conferencias o lugares públicos para conectar el portátil, en nuestra casa pondremos lámparas y aparatos eléctricos donde queramos, nos olvidaremos definitivamente de los dichosos alargadores, o nunca se terminará la batería del móvil.
4.5. Encender y apagar neuronas con la luz
Es muy arriesgado preguntarle a un científico que asiste a un congreso de neurociencia: « ¿Qué es lo último?», porque te puede responder: « ¡Los canales de rodopsina! Pueden significar una revolución en el estudio de la neurociencia. ¡Debes hablar de ellos en el blog!». ¡Uff! Con qué narices me atrevo yo a pedir a los lectores que presten atención a algo llamado canales de rodopsina, sobre todo cuando me confesaron que Vicky decía que era muy nuevo y sería noticia en el futuro.
Pero bueno, decidí investigar, y enseguida encontré la excusa ideal para presentarlos en sociedad sin reparo alguno: un vídeo espectacular que colgué en YouTube con el nombre «Mouse chr2». Si entráis en la página, veréis desde arriba un ratón oscuro tranquilito dentro de una caja blanca. Su única peculiaridad es que tiene un agujero en el cráneo y de él sobresale una bombillita. No parece molestarle, pero a los pocos segundos la bombilla se enciende con un tono azul y el ratón empieza a correr en círculos como un loco. Luego la bombilla se apaga, y él vuelve a quedarse quieto. Si miras otro vídeo llamado «Mouse chr2 control», observarás un nuevo ratón con la misma bombilla insertada en su cabeza, pero que no reacciona cuando ésta ilumina su corteza cerebral.
La diferencia entre ambos es que a la primera, además de la bombilla, los científicos han insertado algo más en las neuronas del córtex motor derecho del ratón
Permitidme que explique la historia desde el principio, porque es acoj… sorprendente:

En los años ochenta unos investigadores descubrieron que en la membrana celular de ciertas algas verdes había unos canales iónicos que, cuando recibían luz azul, se activaban y permitían la entrada de iones cargados positivamente a la célula. Bueno, pues muy bien Qué alegría, ¿no?
Pues resulta que hace muy poco otros científicos pensaron que si las neuronas tuvieran estos canales ChR2 de las algas verdes, como las señales eléctricas que recorren las neuronas se forman precisamente por la entrada y salida de iones positivos, quizá podrían activar células neuronales a voluntad utilizando sólo luz azul. Dicho y hecho. En 2005 Ed Boyden logró trasplantar el canal ChR2 a cultivos celulares de neuronas, y estimularlas a distancia con luz a la frecuencia específica del color azul. Dos años después, Kart Deisseroth, de la Universidad de Stanford, creó el ratón transgénico del vídeo que os describía. Deisseroth le introdujo el gen que codificaba la proteína ChR2, y ahora es el único mamífero que tiene canales de rodopsina en las membranas de sus neuronas motoras. Cuando estas neuronas del córtex derecho reciben luz azul, los canales se abren, dejan entrar iones positivos, se activan de repente y el ratón empieza a girar atolondrado hacia la izquierda. Si se apaga la luz, sus neuronas vuelven al reposo y el animal se detiene.
Esperad, que todavía hay más. Y merece la pena, os lo aseguro. A principios de la década de 1990 otros científicos habían descubierto un microorganismo (la arquea Natronomonas pharaonis) con un canal iónico que hacía justo lo contrario: al recibir luz amarilla, permitía la entrada de iones negativos de cloro y detenía el potencial eléctrico de la membrana. Ed Boyden pensó de vuelta que este canal NpHR podía ser utilizado para desactivar neuronas y, a principios de 2007, en su laboratorio del MIT, esta vez creó unas neuronas que silenciaban cuando recibían luz amarilla. Poco después Kart Deisseroth y Feng Zhang anunciaron que habían inyectado genes en el cerebro de un gusano C. elegans para que expresara el canal NpHR en sus neuronas motoras. Resultado: cuando iluminaban al gusano con luz amarilla, los canales dejaban entrar iones negativos en las neuronas, disminuía el voltaje, las neuronas se desactivaban y el gusano detenía su movimiento. En el vídeo «C. elegans NpHR yellow light» podréis ver un gusano alternando movimientos intensos con paradas bruscas al aparecer una luz amarilla. Nuevo éxito y anuncio de revolución en la neurociencia. ¿Por qué? Por las radicales posibilidades que esto implica.
Si os estáis preguntando para qué sirven estos canales de rodopsina y NpHR, hay dos respuestas. Una es para investigar. La posibilidad de activar y desactivar grupos específicos de neuronas a voluntad es una nueva y poderosísima herramienta para entender el funcionamiento de los circuitos cerebrales implicados en una tarea, y cómo su actividad se relaciona con conductas o capacidades determinadas. Es decir, puedes activar o desactivar un conjunto de neuronas específicas, y ver qué ocurre. En un artículo de Nature estos avances se definieron como «lo mejor que le ha pasado a la neurociencia en mucho tiempo». La segunda respuesta, y es en lo que el grupo de neuroingeniería de Ed Boyden está trabajando, recae en las aplicaciones clínicas de esta metodología: silenciar neuronas que están hiperactivadas como ocurre en el Parkinson y la epilepsia. Actualmente, para tratar estas enfermedades se utilizan electrodos cuya acción es poco específica. Sería ideal sustituirlos por implantes ópticos que hicieran lo mismo con luz amarilla de manera más localizada.
Debo confesar que en el congreso de neurociencia me explicaron que la verdadera exaltación colectiva se había producido el año anterior, ya que los resultados más espectaculares se realizaron durante 2007. Pero, con la perspectiva que ofrece el paso del tiempo, también me dijeron que las expectativas no habían disminuido, sino todo lo contrario. De repente, muchísimos grupos se han puesto a trabajar con esta novedosa tecnología. Sin duda, la posibilidad de activar y desactivar células nerviosas concretas permitirá grandes avances más allá incluso de la neurociencia, y todo apunta a que algún Nobel recaerá en el futuro en las personas que han abierto este campo de investigación.
El embarazoso « ¿Y esto para qué sirve?»
El « ¿para qué?» es una pregunta que suele incomodar a los científicos que hacen investigación básica. Unas veces porque su trabajo es tan complejo que se sienten incapaces de explicarlo, otras porque saben que sólo un pequeño porcentaje de las hipótesis que barajan fructificarán y no quieren lanzar falsas expectativas, y hay ocasiones en que ni ellos mismos saben qué aplicaciones prácticas pueden dar de sí sus experimentos. Investigan para conocer y comprender; ése es el primer paso, y ya les parece suficiente. Que a ti también te lo parezca. A partir de ahora, cuando alguien me diga que está investigando sobre los canales iónicos de un microorganismo de nombre irrepetible, o estudiando cómo reaccionan ciertas algas verdes a la luz azul, nunca más me atreveré a poner en duda para qué sirve la ciencia básica.
§5. El mono que llevamos dentro
5.1. El bueno de Ardi y mi encuentro con la paleontología
«Si consultas a alguien por la calle cuál es el homínido más antiguo te dirá que Lucy, y si le preguntas qué había antes contestará que algo parecido a los chimpancés. El descubrimiento de Ardi contradice ambas respuestas», dijo Tim White durante la rueda de prensa a la que asistí en la sede de la Asociación Americana para el Avance de la Ciencia (AAAS) en Washington D. C.
Me había llegado la invitación un par de días antes, y reconozco que mi primera reacción fue de indiferencia. No me apasiona el estudio de los fósiles, siempre he pensado que los hallazgos y las conclusiones suelen exagerarse y, en comparación con otras disciplinas, ya tiene más que suficiente presencia en los medios. Además, pocas semanas antes se había producido el caso de Ida, anunciado por todo lo alto con una gran campaña de publicidad incluida, y que luego resultó no ser tan relevante como se prometía. Por cierto, no acuséis por enésima vez a los periodistas, pues como en muchas otras ocasiones, en el caso de Ida fueron los científicos quienes incitaron a tal exageración. En cambio, la información que iban a presentar en la AAAS sobre el Ardipithecus parecía ser mucho más trascendente. Ardi sí podía sobrevivir más allá de un par de semanas en los periódicos y ser uno de los pocos fósiles que terminan cambiando los libros de texto. Decidí ir, y valió la pena. A las dos asunciones populares rotas por Tim White con su frase, se le sumó otra cuando una periodista le preguntó sobre la capacidad de caminar erguido de Ardi a pesar de no vivir en la sabana. White contestó: «La ciencia avanza formulando hipótesis y buscando evidencias que la refuten o confirmen. Ardi también demuestra que la teoría según la cual el bipedismo se originó como adaptación a las caminatas por la sabana es falsa».
Ardi es un millón de años anterior a Lucy, empezó a caminar a dos patas a pesar de vivir en un entorno arborícola, y siendo tan diferente a los monos actuales demuestra que, al contrario de lo que se pensaba, nuestro ancestro común no se parecía en absoluto a los chimpancés o los gorilas. Éstos son los tres hallazgos principales del fósil descubierto hace quince años, y de la avalancha de datos acumulados por los investigadores que fueron publicados esa semana en un especial de la revista Science, con once artículos científicos sobre Ardi. Uno de los más interesantes habla de los dientes de Ardi, y las pistas que nos dan sobre su conducta social
Todos los machos de primates menos nosotros tienen caninos grandes y afilados. Los utilizan para pelearse y solucionar conflictos, especialmente a la hora de competir por el apareamiento. Nosotros hacemos lo mismo, pero de manera muy diferente. ¿Desde cuándo? Durante mucho tiempo se pensó que el desarrollo de herramientas y armas hacía innecesarios los caninos, pero cuando se vio que Australopitecus como Lucy ya tenían caninos pequeños se empezaron a explorar otras explicaciones.
Ardi y el resto de los fósiles encontrados de Ardipithecus, tanto machos como hembras, también tenían los caninos pequeños y no afilados. La explicación de Owen Lovejoy es que los primeros homínidos enseguida empezaron a formar grupos sociales más pacíficos, con relaciones monógamas para favorecer el cuidado de las crías, y los caninos poderosos dejaron de ser necesarios para competir por el apareamiento. Es más, las hembras empezaron a seleccionar machos menos agresivos y promiscuos para asegurarse un cuidado parental, con lo que el rasgo «dientes masculinos pequeños» quedó favorecido por la selección sexual. Lovejoy enlaza esta hipótesis con el bipedismo, y dice que dicho cuidado paterno podía implicar ir a recoger comida en el bosque y llevarla en sus brazos a la familia. Ésta es la interpretación de Lovejoy al inesperado descubrimiento de que un homínido tan antiguo ya tuviera caninos diferentes a todo el resto de los primates.
Cuando terminó la rueda de prensa, me acerqué a Lovejoy para preguntarle si estaba muy convencido de ello, y si creía que —como era tan habitual en el especulativo mundo de la paleontología— sus colegas estarían de acuerdo con él o defenderían la teoría que sustentase el fósil encontrado por ellos. Lovejoy contestó: «Oooh… en antropología siempre hay controversia. Pero hemos acumulado muchos datos y de manera tremendamente meticulosa. Intentamos ponerlo difícil a los que quieran contradecirnos. Respecto a los caninos, lo que su ausencia nos muestra claramente es que esos homínidos no luchaban tanto entre ellos, y por consiguiente su organización social debía de basarse en la cooperación. Esto podría haber sentado la base evolutiva del crecimiento del cerebro. Los machos invertían menos energías combatiendo y más cuidando a las crías». Vaya con los caninos del bueno de Ardi.
Lovejoy: Por cierto, tu acento… ¿de dónde eres?
Pere: Spain.
L: ¡¡¡España!!! ¡Me encanta España! Y en Sabadell tenéis unos yacimientos importantísimos, que han dado dos esqueletos fósiles vitales para entender la evolución humana.
P: Y también Atapuerca.
L: ¡Ah, sí! Claro… Un período de tiempo diferente… pero sí, fabuloso también.
5.2. El valor biológico de la justicia y el origen evolutivo de la paciencia
El experimento empieza con dos monos en sendas jaulas contiguas. Uno de ellos tiene acceso a una palanca con la que acerca a la vez una galleta para él y otra para su compañero. Hasta aquí todo normal; siempre que el investigador coloca en el dispositivo una galleta para cada mono, el que tiene la palanca la utiliza y ambos consiguen el mismo premio.

(Ya sé, veis plátanos en la foto porque el dibujante Mikel Urmeneta hizo caso de su buen juicio estético para evitar dibujar algo tan aséptico como una galleta, pero el redactor del texto quiso mantener su rigor científico y no modificar la metodología del experimento. ¡Viva el entendimiento ciencia-arte!).

A lo que íbamos, y atentos, que ahora llega lo más curioso: si el investigador pone una galleta frente al mono con la palanca, pero tres frente al individuo pasivo, el que tiene el control se enfada y no realiza ninguna acción. Sacrifica su galleta. La situación le parece tan sumamente injusta que prefiere no obtener su premio si eso implica que gracias a su trabajo un aprovechado se quede con el triple sin hacer ningún esfuerzo a cambio.
Es uno de mis experimentos favoritos, y cada vez que lo cuento en una cena o reunión de amigos se inician suculentas conversaciones. En una de ellas me preguntaron: « ¿Por qué no lo publicas en el blog?». Expliqué que lo había oído durante una charla de Marc Hauser en Harvard, pero todavía no estaba publicado en una revista que le otorgara la supuesta «veracidad científica». Los comensales me convencieron para publicarlo al día siguiente con un simple « ¿Y qué?».
Y es que tenían toda la razón del mundo. El estudio se las trae. Recuerdo haber leído acerca de chimpancés enfureciéndose si por una misma acción a un compañero le daban un premio superior al suyo, pero llegar a sacrificar de tal manera su propio beneficio es algo relativamente inesperado. Sobre todo porque esto en principio no debería estar favorecido por la selección natural.
El altruismo y el rencor son aspectos peliagudos en el estudio de la naturaleza humana. En la década de 1960 Robert Trivers estableció que el altruismo podría haber evolucionado para favorecer la reciprocidad dentro de los grupos de primates sociales, pero algunos interpretan esta colaboración como un egoísmo encubierto en el que la ayuda está condicionada a un beneficio futuro. Sea como sea, sí tiene sentido evolutivo.
Sin embargo, realizar una acción que suponga un coste para nosotros sin que eso implique ninguna recompensa es algo que no encaja en los esquemas de la selección natural Entre dos monos, uno rencoroso que no come la galleta y otro más cándido que sí se la come sin importarle que un desconocido obtenga tres a cambio, el que tiene más posibilidades de sobrevivir en la selva es el que vaya mejor alimentado.

Una explicación a este aparentemente ilógico comportamiento sería que para el buen funcionamiento del grupo es muy importante penalizar las injusticias y asegurarse de que nadie se beneficia en exceso del trabajo de los demás, pero tal «razonamiento» parecía demasiado sofisticado para los primates.
El estudio de las galletas induce a pensar que la mala sangre que sentimos cuando alguien sale beneficiado en demasía de una situación que consideramos injusta, aunque no nos afecte directamente, puede estar bien arraigada en nuestra herencia evolutiva.
Evidentemente, da para mucho más. Menos mal que tras darle vueltas y vueltas a las implicaciones de este experimento, Mikel insistió en que el no saber si eran macacos, chimpancés, tamarinos o bonobos, ni el porcentaje exacto de monos que no accionaban la palanca, ni tener una triste fotografía para ilustrarlo, era una excusa para no publicarlo. « ¡Nada de eso debería ser un inconveniente!», replicó sabiamente Mikel mientras cogía papel, rotuladores, y compartía su arte con la ciencia.
Origen evolutivo de la paciencia
Al final sí busqué la referencia al artículo de Marc Hauser sobre los macacos resentidos

La pregunta « ¿Hay algo fundamental que diferencia a los humanos del resto de los animales?» siempre me ha recordado a « ¿Qué diferencia a un sevillano de un andaluz?»; pero es cierto que reflexionar sobre ella suele suscitar interesantes intercambios de ideas. En apariencia, nuestro cerebro se ha desarrollado hasta tal punto que permite capacidades únicas, pero si te empeñas en defender que todo es cuestión de grado, resulta realmente difícil encontrar alguna habilidad que nos distinga de manera esencial. Los clásicos usos de herramientas y lenguaje ya hace tiempo que quedaron desterrados, al constatar que gran número de animales poseían sistemas de comunicación verbal y utilizaban palos o rocas para realizar trabajos. Es obvio que nosotros le añadimos varios niveles de complejidad, debido a la capacidad de abstracción y planificación a largo plazo de nuestra tan desarrollada corteza prefrontal. Alrededor de esta capacidad de abstracción es por donde anda la respuesta a qué nos diferencia del resto de los animales. Pero, al mismo tiempo, es difícil negar que un chimpancé metiendo un palo en un hormiguero no posea un mínimo de abstracción para prever que las hormigas subirán por él y podrá comérselas. Siempre que encontramos alguna característica que parece hacernos especiales, alguien aparece con un matiz que nos fuerza a reconocer que no somos tan exclusivos.
Tras mucho tiempo divagando sobre el mono que todos llevamos dentro, yo tenía una respuesta que me parecía original: «¡¡La paciencia!! Los homínidos somos los únicos seres que no sucumbimos a la recompensa inmediata si intuimos que la espera o el sacrificio nos reportará un beneficio mayor en el futuro. El resto de los impulsivos animales no tienen esta capacidad de extrapolación y autocontrol; sin embargo, nosotros mantenemos esta actitud hasta el sinsentido».
De hecho, esta hipótesis ya venía avalada por varios experimentos. En el artículo «La ecología y la evolución de la paciencia en dos especies de monos modernos», publicado en 2004 por Marc Hauser, se explicaba cómo cuando a monos tamarinos y marmosetes les daban a escoger entre un poco de comida inmediata o una cantidad mayor en el futuro, casi siempre se quedaban con la opción rápida. En cambio, si a los miembros de esa especie que se autositúa en la cima de la evolución les ofreces una cantidad económica ahora, o el doble dentro de un tiempo, la mayoría piensan y deciden esperar. Conclusión: la paciencia es una propiedad básicamente humana.
¿Seguro? Al grupo de Hauser no le encajaban un par de aspectos: 1) ¿qué ocurriría si en lugar de tamarindos y marmosetes los experimentos se hicieran con primates más cercanos evolutivamente a nuestra especie?, 2) ¿y si a esos sofisticados humanos les dieran a escoger comida en lugar del moderno dinero? Podéis imaginar la respuesta: continuamos siendo muy monos.
En un primer estudio diseñaron un sistema que permitía a bonobos y chimpancés entender que podían escoger entre dos uvas de inmediato o seis con un retraso de un par de minutos. Era la misma metodología que se había utilizado con los tamarindos, pero los resultados fueron muy diferentes. Bonobos y chimpancés exhibían un grado de paciencia nunca vista hasta el momento en el reino animal.
Luego realizaron un segundo estudio en el que comparaban la disposición de chimpancés y humanos a esperar por una cantidad de comida mayor. Sorprendentemente, los estudiantes universitarios que participaron en la investigación eran más impacientes que los chimpancés, y soportaban peor la tentación de comer lo antes posible.
En un tercer experimento quisieron comprobar si los humanos respondíamos de manera muy diferente ante los premios basados en comida o en dinero. Y, como cabía esperar, los resultados indicaron que estamos dispuestos a contenernos mucho más ante recompensas monetarias futuras: somos muy humanos para el dinero, pero muy monos para la comida.
Está claro que el dinero es intercambiable por otros productos, no ofrece la misma satisfacción inmediata, y se puede guardar más tiempo que los alimentos. Quizá eso es lo que condiciona la diferencia de actitud. De hecho, también se observó un efecto curioso en marmosetes y tamarinos: dentro de lo poco que ambos esperaban, los marmosetes —que se alimentan de vegetales— tenían más paciencia que los tamarinos, cuya dieta incluye insectos que requieren cazarse con acciones rápidas. Seguro que podemos encontrar diversas interpretaciones. La objetividad en los estudios de conducta humana también es cuestión de grado. Pero los resultados sí inducen a concluir que la capacidad de tomar decisiones pensando en el futuro es un rasgo evolutivo que apareció antes de la llegada de los homínidos, y que en ciertos contextos nuestros parientes más cercanos son incluso más pacientes que nosotros y reciben mayor recompensa. Somos muy racionales con algo como el dinero, que nuestra mente más primitiva no entiende, pero cuando nos ponen delante unos estímulos más primarios, parece que no hayamos evolucionado tanto como creíamos.
5.3. El gen altruista: la evolución nos hizo bondadosos
Recuerdo estar tomando una copa en el bar The Miracle of Science en Boston, acercarse una ex amiga y decirme algo parecido a «Te vi la semana pasada en ese evento del museo del MIT sobre ciencia para el Tercer Mundo». « ¡Ah, sí! —respondí—. Estuvo bien, ¿verdad?». Ella contestó algo parecido a: «Fue interesante, pero a mí no me gustó, porque no creo que estemos obligados a ayudar a los países pobres. Cada uno que se cuide de los suyos».
No estoy exagerando, más bien todo lo contrario. De hecho, evito por decoro las justificaciones posteriores al racismo, xenofobia y sexismo espetadas por esa loca ante mi incrédula mirada justo antes de decir: «Yo creo en el darwinismo social. La naturaleza nos ha hecho seres competitivos, que nos preocupamos por nuestro propio interés y el de la comunidad directa que nos acoge. En el fondo, todos tenemos instinto egoísta. Defender lo contrario es una hipocresía. Mis nietos van a competir con los nietos de los países africanos». Cuando oí «darwinismo social» me sulfuré. Dejé que terminara su frase, la miré directamente a los ojos, y le dije: «No quiero hablar contigo nunca más». Lo cumplí.
El darwinismo social es una teoría pseudocientífica que pretende aplicar la lógica de la selección natural al funcionamiento de la sociedad. Asume que la «supervivencia del más apto» es algo positivo y que hay que fomentar. El bien colectivo es una noción romántica; la evolución nos ha programado como seres competitivos preocupados por maximizar el beneficio propio, y todas las acciones altruistas que podamos observar dentro de una comunidad animal son en realidad un egoísmo encubierto, una estrategia para cohesionar el grupo cuando de esa manera resulte más exitoso sobrevivir. Ya sé, algo de sentido parece tener…
Mi indignación con esa persona no era por pensar que no nacíamos con cierta programación genética maquiavélica, sino por utilizar el darwinismo social para justificar ciertas lacras sociales, en lugar de fomentar que el progreso cultural corrija la codicia innata que pueda arrastrar nuestra especie. Pero reconozco que, de alguna manera, yo también asumía que nacíamos «malos»; que el altruismo verdadero era un bien adquirido, no genético.
Sin embargo, cambié de parecer gracias a que a los periodistas radiofónicos no les interesa la ciencia. Me explicaré más tarde. El hecho es que un día cayó en mis manos el libro The Age of Empathy del primatólogo Frans de Waal cuya tesis es: «Basta ya de creer que somos egoístas por naturaleza. ¡No lo somos! Las investigaciones en conducta animal llevan años sugiriendo que debemos cambiar este paradigma, y asumir que la evolución ha insertado la empatía y la solidaridad en nuestro comportamiento básico».
Empatía es la palabra clave. Frans de Waal reconoce que la empatía surgió para que las madres cuidaran de sus hijos, y posteriormente se extendió a la cohesión de grupos sociales. Pero una vez instaurada en nuestros cerebros, pasó a ser un instinto que se manifiesta más allá del grado de parentesco. No vamos por ahí haciendo cálculos matemáticos de cercanía genética para saber con quién debemos aplicarla. Simplemente, durante nuestro pasado evolutivo nos transformamos en seres bondadosos.
Resulta obvio que tenemos un lado competitivo y otro social. De Waal explica que sus chimpancés se preocupan primero por el beneficio propio, luego por el de sus parientes, y finalmente por los componentes del grupo que le rodean Pero esto no termina ahí de ninguna manera. En sus experimentos ha demostrado que la cooperación, el sentido de la justicia, la aflicción, la empatía, se extienden mucho más lejos de la lógica egoísta-competitiva, y se pueden observar incluso entre especies diferentes.
No es un razonamiento nuevo. Lynn Margulis lleva tiempo defendiendo la cooperación como un mecanismo más poderoso que la competencia incluso a escalas bacterianas, y libros como La mente moral de Marc Hauser sugieren que los valores morales forman parte intrínseca de nuestra naturaleza. Pero el cambio cultural es lento, y venimos de un siglo donde la cultura occidental ha estado promoviendo sistemas basados en la competencia. La asunción neo darwinista de que la selección natural nos hizo unos egoístas encubiertos está fuertemente instaurada, en parte gracias a obras muy influyentes como El gen egoísta, de Richard Dawkins. Frans de Waal argumenta que no es así en absoluto, y debemos empezar a cambiar de paradigma.
Conscientes de que en el debate sobre la naturaleza humana hay más interpretación que pruebas irrefutables, la posición de De Waal parece acarrear una reflexión importante: no nacemos con un instinto codicioso y cruel que la sociedad deba corregir, sino con una profunda predisposición a la empatía y la solidaridad desinteresada que nuestras estructuras sociales no deben corromper.
Sobre el desatino de la radio: una amiga locutora me ofreció un tour por los estudios centrales de la NPR (la emisora pública de Estados Unidos). Allí, en las diferentes redacciones había estanterías de libros descartados que les llegaban para preparar entrevistas, pero luego nadie quería llevárselos a casa. Encontré un montón de libros buenísimos de ciencia. Entre ellos, el de Frans de Waal. Tenía ya seis en mi mochila y no cabía ninguno más, pero entonces encontré otro fantástico: The World in Six songs, de Daniel Levitin, sobre neurociencia y música. Lo tenía en mis manos pensando qué libro iba a descartar de mi repleta mochila para alojar el de Levitin, cuando apareció otra acompañante de las visitas y dijo « ¡Uau! Leí el otro día una reseña de este libro. Me encantaría leerlo, ¿te lo vas a quedar?». Me salió un instintivo: «No, no.», « ¿Seguro?». «Sí, sí, seguro. Mira, tengo ya la mochila llena». No sé de dónde apareció ese acto «altruista». Realmente, no tenía ningún sentido. No iba a ver de nuevo a esa chica, ni tenía ningún interés en ello. Me sentí un poco tontín, pero no arrepentido de perder el libro. Creo que instintivamente empaticé con su felicidad momentánea. No sé si es genético o cultural, ni si volvería a repetirlo, ni si hubiera hecho lo mismo estando hambriento ante un trozo de carne; pero recordé ese suceso días después leyendo el libro de De Waal, y creo que —sin pretender dármelas de nada— esa reacción inmediata se podría clasificar de bondad instintiva.
5.4. Estresados por demasiado/poco inteligentes: tu jefe es un babuino
Un comentario habitual entre los turistas que visitan Nueva York por pocos días es: «Me encanta, es muy estimulante, pero no podría vivir aquí, ¡me estresaría!». Tú les cuentas que la ciudad cambia de cara cuando la disfrutas con tiempo, pero sabes que no hay nada que hacer. Están experimentando algo parecido a subir una montaña rusa: tres minutos es excitante, te vigoriza, disfrutas, te sienta bien, pero nadie soportaría tres horas seguidas de subidas y bajadas atolondradas. Como dice el gran Robert Sapolsky, un poco de estrés es bueno, nos pone alerta y nos permite salir airosos de situaciones conflictivas. Pero el estrés continuado es devastador. Y no se refiere sólo a ir corriendo a todos sitios, sino también a la capacidad que nos brinda nuestro evolucionado cerebro de estar preocupados constantemente.
Un cuerpo desequilibrado
Vivir sin nada de estrés es utópico. Todos los animales necesitamos que en algún momento nuestro cuerpo segregue de golpe adrenalina y glucocorticoides para acelerar el ritmo cardíaco, dirigir energía hacia los músculos, incrementar nuestra atención y rapidez mental, e inhibir las funciones metabólicas que en momentos de riesgo no son imprescindibles, como la digestión, el crecimiento o la reproducción. El mecanismo por el que actúa el estrés es uno de los vestigios evolutivos más ancestrales que compartimos con el resto de los animales. La diferencia es que mientras un león y una cebra sólo se estresan unos minutos al día mientras uno persigue al otro, nuestra especie es la única que puede generar la misma reacción fisiológica y extenderla indefinidamente con sólo pensar en la hipoteca, la presión laboral, proyectar preocupaciones futuras, sueños frustrados, y muchísimos otros factores psicosociales. Sapolsky y otros científicos han demostrado que los episodios de estrés prolongado afectan a tu memoria porque destruye neuronas de tu hipocampo, deprime el sistema inmunológico, aumenta la presión arterial, cambia la distribución de grasas en tu cuerpo, afecta a los telómeros de tu ADN causando envejecimiento prematuro, altera tu ciclo menstrual, causa disfunción eréctil, e incrementa el riesgo de enfermedad cardíaca. No sólo en los humanos, sino también en otros primates sociales como los babuinos.
Babuinos perversos como modelo para estudiar humanos
Robert Sapolsky es uno de los mejores comunicadores científicos que conozco. Lo descubrí gracias a la videoconferencia que hicimos en Redes desde su laboratorio de Stanford. La claridad de su mensaje, pero también su desparpajo casi irreverente, nos entusiasmó tanto que programamos una nueva entrevista en persona pocos meses después. Fue maravillosa de nuevo. Desde entonces le sigo la pista. Sus libros y artículos son un referente en comunicación científica, un ejemplo de que los científicos pueden utilizar un lenguaje natural y desenfadado para comunicar sus resultados al gran público. Por eso, cuando supe que visitaba Washington D. C. para dar una charla en el National Geographic como presentación del documental inspirado en su trabajo «Estrés asesino», no dejé pasar la oportunidad de conocerlo persona.
Robert Sapolsky lleva treinta años combinando sus investigaciones neurocientíficas en Stanford con el estudio de babuinos en Kenia. Para él, estos primates se han convertido en un excelente modelo para investigar los efectos del estrés social y prolongado. Sus babuinos no tienen depredadores naturales. Sólo invierten tres horas al día buscando comida, y el resto del tiempo se dedican a fastidiarse entre ellos. Como en algunos trabajos. Sus grupos sociales son muy jerarquizados, con al menos cinco rangos diferentes, y siguen pautas de comportamiento parecidas a las de los humanos
Cuando un macho increpa a otro de una categoría inferior, éste se enfada, y ¿cuál es su reacción? Ir a descargarse con otro babuino que esté por debajo de su rango. Como tantos mediocres cargos intermedios en empresas. En el documental Sapolsky dice: «Llevo treinta años estudiándolos, pero confieso que no me caen bien. Son extremadamente crueles entre ellos, y se infligen una cantidad de estrés psicológico enorme». Sapolsky ha estado tomando muestras de sangre de los babuinos para analizar su estado de salud y las hormonas relacionadas con el estrés en función de la jerarquía social que ocupan. Las conclusiones que publicó en Science son claras: cuanto más bajo estás en el rango, más estresado te encuentras y peor es tu salud[43]. Estos resultados son consistentes con un estudio parecido que Michael Marmot realizó con funcionarios británicos. Contrariamente a lo que se suele pensar, el más estresado no es el jefe, sino los cargos inferiores. La falta de control es un factor directamente relacionado con el aumento de estrés. La peor situación que puedes vivir en tu empresa es tener mucha responsabilidad y poca autonomía. Es decir, si algo falla sabes que la culpa será tuya a pesar de que tus superiores no te otorgan libertad alguna para tomar decisiones. ¿Os suena?
Atajar el estrés de raíz
Sapolsky apunta asimismo que esta mente tan desarrollada que permite estresarnos por motivos psicológicos también puede ser utilizada a nuestro favor. Podemos reflexionar: «A ver, este trabajo infravalorado no es lo más trascendente, lo que realmente me importa es ser el capitán de mi equipo de béisbol, o formar parte de un grupo en mi parroquia». Nuestra capacidad de abstracción mental puede conducirnos a más estrés, pero también jugar a nuestro favor si sabemos utilizarla correctamente. Sapolsky es muy crítico con las «presiones absurdas» que genera el estilo de vida estadounidense. Y cuando le cuestionan diciendo que esas presiones son necesarias para ir avanzando contesta: «No compensa». Las maneras de reducir tal presión psicológica ya las sabemos: ni dejes que te estresen, ni estreses tú a nadie. Mantén unas relaciones sociales satisfactorias, y cambia de perspectiva y prioridades. Al final de la charla alguien le preguntó por la meditación. Contestó con cierta ironía que no lo había investigado porque los babuinos son malos meditadores, pero que no tiene sentido almorzar a toda prisa para poder ir veinte minutos a meditar, y luego regresar cinco horas a tu trabajo angustioso.
Me hizo pensar. Parece que el desarrollo del cerebro esté aún a medio camino. Nuestra especie es tan inteligente que puede estresarse por causas psicosociales, pero todavía no es lo suficientemente lista como para saber cómo evitarlo.
5.5. Matrimonio con robots: botones darwinianos y tecno entusiasmo desmesurado
En el libro Amor y sexo con robots, David Levy afirma que en 2050 empezaremos a casarnos legalmente con robots. Habrán avanzado tanto que nos resultarán romántica y sexualmente atractivos, e incluso tendrán la capacidad de enamorarse de humanos. Para Levy, el amor y el sexo con robots es inevitable. En un artículo de Scientific American se puede leer la siguiente cita suya: «Si la alternativa es sentirte solo, triste y miserable, ¿no es mejor estar con un robot que actúa como si te quisiera?, ¿realmente importa, si en el fondo te hace ser más feliz?». En la entrevista que acompaña al artículo, asegura que las generaciones nacidas en un mundo ciberelectrónico no verán anormal considerar a androides como amigos, compañeros, o amantes. Además, hay muchas personas con un vacío emocional y afectivo enorme que podrían beneficiarse de las relaciones con robots. Para él sólo hay un pequeño paso entre enamorarse en internet de un «desconocido» o de un robot. Recuerda a una especie de test de Turing, en el que haces preguntas «a ciegas» a una persona y una máquina, y por sus respuestas no puedes deducir quién es quién. Claro que podríamos encontrar cierto sentido en los planteamientos de Levy, pero no voy a darle más coba. Sus especulaciones propagandistas no me interesan en absoluto. En cambio, sí es tremendamente relevante el análisis serio y meticuloso que algunos científicos y sociólogos están haciendo sobre la relación que tendremos con los nuevos robots sociales, cuando éstos logren escapar de los laboratorios.
Robots de compañía: ¿mejores que una mascota?
Estando en el MIT asistí a una interesantísima discusión con Cynthia Breazeal, directora del grupo de robots personales en el Media Lab y creadora del famoso robot Kismet capaz de expresar emociones, y Sherry Turkle, socióloga directora del MIT Initiative on Technology and Self y autora de libros como The Second Self y La vida en la pantalla, donde analiza nuestra interacción con la tecnología desde el punto de vista psicológico y social. Es un sacrilegio, pero por principios de economía lingüística resumo las explicaciones de Breazeal y me centro en el análisis crítico de Turkle, cuyas reflexiones me parecen imprescindibles.
El objetivo del grupo de Cynthia Breazeal es construir robots que manifiesten conductas sociales, expresen emociones, muestren empatía, y se relacionen con nosotros en términos más humanos. Más allá de ser tratados como juguetes, en un futuro muy cercano los robots personales podrían ser utilizados con fines educativos en niños, como compañía de personas mayores, o en hospitales donde no se pueden tener mascotas. Kismet fue el primer robot emocional que se construyó, Leonardo es el más logrado en cuanto a expresividad, y su última perla, el MDS, era uno de los robots sociales humanoides más avanzados que existían.
Suficiente publicidad gratuita por hoy. Vayamos a la parte seria del asunto: Sherry Turkle ha realizado estudios en los que reparte robots personales entre niños y personas mayores. El objetivo es investigar la naturaleza de la relación que se establece con ellos, analizar los sentimientos que evocan estos «artefactos relacionales», y ver qué nos pueden mostrar sobre nosotros mismos.
¡Turkle explica que estas máquinas programadas para mostrar sensibilidad consiguen presionar los «botones darwinianos» que la evolución ha cableado en nuestro cerebro: sus grandes ojos se fijan en tu mirada, persiguen tus movimientos, reaccionan ante el tono de voz, cambian las expresiones faciales cuando se les acaricia! Estamos programados para reaccionar emocionalmente ante algo que interactúe con nosotros. Cuando la gente pasa tiempo con estos robots, llega un momento en que realmente los considera criaturas con intenciones, emociones y autonomía. Entonces empiezan a tratarlos como si estuvieran vivos, se proyectan sentimientos, aparece la sensación de reciprocidad (cuidarse mutuamente), e incluso el vínculo emocional Algunos no quieren desprenderse de ellos. El siguiente comentario extraído de una participante en sus estudios refleja una reacción bastante corriente: «Es mejor que un gato, no hará nada peligroso, ni exigirá tantos cuidados, ni te traicionará, y no se morirá de golpe haciendo que te sientas triste».
La tecnología no es sólo una herramienta
Sherry Turkle se define como una crítica cultural. No toméis este término como la definición de una persona rebuscada que sistemáticamente busca el aspecto negativo de cualquier avance tecnológico. Todo lo contrario. Su perspectiva desde la disciplina académica de ciencia, tecnología y sociedad (STS) es objetiva; simplemente, plantea unas preguntas sobre el mundo de la ciencia que no suelen realizarse los investigadores.
De hecho, en sus obras siempre se ha mostrado muy positiva acerca de nuestra relación con la tecnología, pero reconoce que desde hace un par de años ha detectado cierto tecno entusiasmo pragmático que le preocupa. Y cita como ejemplo extremo el libro de Levy y la posibilidad de ser amigos o amantes de un robot. Lo que más le conmociona no son las elucubraciones futuristas, sino la velocidad a la que tales ideas se están aceptando como una opción viable contra la soledad. Turkle asegura que hace años la gente negaba tajantemente que el sentimiento «simulado» de un robot pudiera tener un efecto equivalente a un sentimiento «real». Pero cada vez encuentra más reacciones del tipo «los humanos también fingimos y nos creemos sentimientos falsos entre nosotros». Entre sus encuestas ha encontrado casos de personas con varios fracasos amorosos y un profundo temor a la soledad, que se mostrarían abiertas a forzar la ilusión de un robot como alguien vivo que les ofrece compañía. O niños que en una exposición se mostraban decepcionados con la inactividad de las tortugas reales, y aseguraban que ellos las sustituirían por animales artificiales. Lo que importaba era el comportamiento, no si un objeto está vivo o no. Según Sherry Turkle, el concepto de «realidad» está cambiando muy rápido entre las nuevas generaciones. Se está gestando una crisis de la autenticidad en la que se difuminará la diferencia entre un gato y un robot. La combinación entre aislamiento físico e intimidad cibernética nos podría conducir a unos niveles de superficialidad y promiscuidad tecnológica impensables hace unos pocos años. A mí los robots sociales del Media Lab no me merecen admiración ninguna y más bien los veo como un capricho del enfermo mundo desarrollado, pero ¿beneficiarán a las personas mayores? Seguro que sí. ¿Harán sentirse mejor a los individuos con déficit de afecto? ¿Serán útiles en la educación de los niños? Muy probablemente. ¿Perjudicarán nuestra integridad moral? La respuesta no depende de lo que las máquinas sean capaces de hacer hoy en día, o en el futuro, sino en qué nos convirtamos nosotros.
§6. Ciencia contra la pobreza
6.1. El laboratorio más rudimentario del MIT
Hay un punto concreto de la calle Ames en el campus del MIT que defino como «el rincón más interesante del mundo». A tu derecha tienes el Media Lab donde se diseñan los proyectos tecnológicos más futuristas del MIT. Frente a ti el Departamento de Biología Sintética, y escasos 100 metros más adelante el Broad Institute, posiblemente el centro más avanzado en genética del mundo. Si giras a la izquierda, verás el Stata Center con sus reconocidísimos centros de robótica e inteligencia artificial, un edificio con laboratorios químicos, nanotecnológicos y de ingeniería espacial, la torre con algunos de los climatólogos más prestigiosos de Estados Unidos, y la construcción del Koch Institute, que con un presupuesto millonario aplicará principios de ingeniería a la investigación en cáncer. Y si alzas la mirada, podrás distinguir una parte de los Institutos Picower y McGovern dedicados exclusivamente a la neurociencia. Detrás de ti encontrarás la reconocida Sloan School of Management, a su lado la Facultad de Economía del MIT que ha generado tantos premios Nobel, y las aulas del Departamento de Ciencia, Tecnología y Sociedad a cuyos seminarios yo acudía cada lunes por la tarde.
Paseando por el MIT respiras futuro, y no te queda ninguna duda de que en lugares como éste es donde se inventa parte del mundo en el que viviremos. Puedes cruzarte con el robocar y darte cuenta de que es un todoterreno autónomo que se desplaza sin conductor ni control remoto; sólo con sensores y un sistema de posicionamiento que le permite dirigirse a sí mismo. O que Rodney Brooks te presente a su robot con sensores táctiles deformables llamado Obrero, y el Departamento de Ingeniería Mecánica al robosnail, que imita a un caracol y sube por las paredes llegando a cualquier rincón que se proponga. Dava Newman tiene colgado en su pared el traje espacial que puede sustituir a los engorrosos que actualmente llevan los astronautas. En el Institute for Soldier Nanotechnologies descubres la abrumadora cantidad de dinero que el ejército de Estados Unidos está invirtiendo en sensores, implantes biónicos y protectores a base de nanotubos con el objetivo de proteger mejor a sus soldados. Puedes ver una bombilla encendiéndose sin ningún cable que le transmita electricidad, un catalizador químico que descompone agua en oxígeno e hidrógeno con prometedora eficiencia, o presenciar las espectaculares explosiones en el interior del impactante reactor Alcator C-Mod del centro para el estudio de la fusión nuclear. Tobillos electrónicos, robots expresando emociones, todo tipo de interfaces con el ordenador, nanopartículas que viajarán por tu torrente sanguíneo, bacterias programadas genéticamente, o un ingeniero investigando cómo puede dirigir un sonido para ser oído sólo en un lugar concreto. He estado físicamente en todos estos laboratorios y muchos más. Pero si tuviera que escoger uno como mi preferido, quizá me quedaría con el más rudimentario de todos: el D-Lab dirigido por la carismática Amy Smith.
El objetivo del D-Lab (laboratorio del desarrollo) es al tiempo menos y más pretencioso que todo este high-tech dirigido a inventar el futuro. Sólo pretende aprovechar las ingeniosas mentes de los estudiantes del MIT para solucionar problemas concretos en países en vías de desarrollo, que no es poco. Hay una única condición: hacerlo de manera sencilla y barata para que pueda ser implantada fácilmente por la comunidad que la reciba. La transferencia de tecnología que ellos impulsan no consiste en regalarles molinos eléctricos para triturar el grano y producir harina, sino ayudarles a diseñar un aparato que ellos mismos puedan construir, difundir, y consiga reducir la enorme cantidad de mujeres que pasan largas horas haciendo este proceso de forma manual. Es un verdadero intercambio de conocimiento entre uno de los centros pioneros en la actual revolución tecnológica y algunos rincones del planeta que están todavía lejos de la revolución industrial.
Es tan seductor que la asignatura organizada por el D-Lab es de las más solicitadas por los estudiantes del MIT. Cada año hacen sorteos para seleccionar a los afortunados, cuyo proyecto será analizar las necesidades identificadas por ONG o miembros del D-Lab, buscar soluciones, viajar tres semanas sobre el terreno, trabajar con la gente local para resolver la problemática en cuestión, y recibir la recompensa emocional que supone ayudar de forma noble a personas que lo puedan necesitar. Muchos definen esta asignatura como la más influyente de sus estudios, y algunos han decidido reorientar su carrera profesional hacia el mundo de la cooperación al desarrollo. Y no es un tema baladí, si hablamos de estudiantes brillantes destinados a causar un fuerte impacto en cualquier tarea que desarrollen. El D-Lab ya ha implantado los molinos antes citados en comunidades de Senegal, prótesis más baratas y fáciles de ajustar en la India, un sistema de cloración del agua que se está extendiendo por Honduras, generadores para cocinar con energía solar en Lesotho (África), una desgranadora manual de cacahuetes, incubadoras que no requieren electricidad para realizar análisis bacteriológicos del agua, y muchos otros proyectos que en países pobres no saben cómo abordar, ni hay empresas con interés comercial suficiente para desarrollarlos.
Quien primero me mostró el casi rústico taller del D-Lab fue el ingeniero español Víctor Grau, cuyo proyecto favorito tras varios años como profesor en el D-Lab era la producción de carbón para cocinar a partir de desechos agrícolas. Puede que no te parezca tan impactante; ésa también fue mi primera reacción Pero cuando Víctor te explica que en Haití las familias gastan casi el 25 por ciento de sus recursos en comprar madera para cocinar, que esa madera proviene de una preocupante deforestación, y que a escala global los humos que se respiran en el interior de las casas representan uno de los principales problemas de salud en niños menores de cinco años, te das cuenta de que transformar restos inservibles de mazorcas de maíz en carbón sí puede tener un fuerte impacto. La simple e ingeniosa técnica de carbonización desarrollada por el D-Lab ya ha sido exportada a diferentes rincones del planeta.
Es una tarea encomiable posibilitada por el compromiso y el liderazgo de Amy Smith, una brillante ingeniera que decidió alejarse de ideas futuristas extravagantes y trabajar directamente en solucionar problemas concretos en los países que más lo necesitan. Conocí por primera vez a Amy durante un seminario, y volví a coincidir con ella en diversas ocasiones. Aparece frecuentemente en los medios de comunicación, la solicitan en numerosas conferencias, ha recibido varios premios, y está considerada una de las personas más carismáticas del MIT; pero cuando conversas con ella sólo transmite humildad, honestidad, una profunda vocación por su labor, y percibes esa calma y satisfacción que produce hacer un trabajo bien hecho, del que se siente orgullosa, y que contribuye a avanzar hacia un mundo mejor. Inspiradora. Porque, como dijo en una ocasión, en este reto global the difference between nothing and something is everything, «la diferencia entre algo y nada lo es todo».
6.2 Benedicto XVI: Las evidencias científicas contradicen sus palabras
— ¿Es positivo dar libros a los niños de países en vías de desarrollo para mejorar su educación?
— ¡Sí, claro!
— ¿Cómo lo sabes?
—Hombre, me imagino que.
—No imagines nada. ¿Es más efectivo que proporcionarles un profesor adicional, o darles un desayuno gratuito?
—No lo sé. Una cosa no quita la otra.
—Si tienes un presupuesto ajustado, sí.
—Pero es mejor tener libros que no tenerlos. Yo creo que…
—No creas nada. Es un tema demasiado serio para abordarlo según lo que «creas». Si tu objetivo es mejorar la educación en un país como Kenia, y dispones de unos recursos limitados, deberías tener muy, pero muy claro, cuál es la forma más eficiente de gastarlos.
— ¿Y cómo puedo averiguarlo?
—Selecciona un buen número de escuelas con características similares en una misma región A unas les das libros, a otras les proporcionas profesores, a otras das comida gratis a los alumnos que acudan a clase, en otras regalas uniformes, en otras desparasitas a los niños regularmente, y en otras no haces nada de momento. Intenta controlar todos los factores que puedas, sigue el desarrollo de los alumnos durante uno o dos años, y al final analiza qué impacto real ha tenido cada medida, y cuánto te ha costado.
—Esto me recuerda a los estudios sobre salud. Para ver si el aceite de oliva es bueno para el corazón, y todo eso, ¿no?
— ¡Exacto! Se llama un randomizedtrial, «estudio randomizado», o ensayo aleatorio controlado, y es una metodología propia de los estudios epidemiológicos.
—Me parece un poco exagerado, ¿eso se debe hacer en cada caso?
—No. Si quieres solucionar problemas concretos que ya tienes bien identificados, o cuentas con mucha experiencia sobre el terreno, quizá no es necesario. Pero si pretendes abordar una situación nueva, o tienes dudas sobre si ciertos programas ya implantados son efectivos o no, esos estudios pueden resultar de gran ayuda.
—De todas formas, ¿no es un proceso un poco lento?
—Piensa a medio plazo.
—Entonces… ¿cuál es la mejor forma de mejorar la educación en Kenia?
Éste es el tipo de preguntas que intentan resolver en el Poverty Action Lab del Departamento de Economía del MIT. Ellos mismos definen su objetivo global como: «luchar contra la pobreza asegurando que las decisiones políticas se basan en evidencias científicas». Para ello trabajan en colaboración con ONG y gobiernos, evaluando mediante estudios randomizados el impacto de sus programas sociales contra la pobreza. El ejemplo citado en el diálogo anterior es real. Una serie de estudios realizados en Kenia y la India concluyeron que los libros que estaba suministrando una ONG causaban un ligero impacto sólo en el 5 por ciento de los niños. El profesor adicional era una medida un poco más efectiva, pero con diferencia la más cara. Regalar uniformes al inicio del curso aumentaba la escolarización en un 15 por ciento. Las escuelas que servían desayunos gratuitos reducían el absentismo en un 30 por ciento. Pero los resultados más notorios los obtuvo el programa de desparasitamiento. Además de ser la acción más barata, los niños sin gusanos intestinales perdían menos días de clase y tenían un rendimiento escolar muchísimo mejor. Claramente, desparasitar a los niños era la medida con mejor relación «coste-efecto», y según el Poverty Action Lab debería convertirse en una de las acciones prioritarias a implementarse a gran escala en las escuelas de los países pobres.
Conocí este estudio y al Poverty Action Lab (J-PAL) durante un seminario impartido por su directora, la economista Esther Duflo, en el Departamento de Ciencia, Tecnología y Sociedad del MIT. Me impactó. Una de mis obsesiones es que la ciencia impregne cada vez más la toma de decisiones políticas, y ver que la metodología científica podía ser aplicada en la lucha contra la pobreza me resultó tan interesante que posteriormente me reuní con otros miembros del JPAL para pedirles más información sobre sus evaluaciones. Una de ellas me vino al pelo quince meses después.
Sida en África: ideología versus ciencia
Cuando en marzo de 2009 oí al papa Benedicto XVI decir durante su visita a África que «la distribución de preservativos no soluciona el problema del sida, incluso lo agrava», mi primera reacción fue de estupor y enfurecimiento visceral. ¿Cómo podía alguien tan influyente espetar semejante sandez? ¿Hasta tal punto estaba su ideología por encima de la vida de tantos miles de personas?
Te calmas pensando que podría haber sido un lapsus sacado de contexto. Pero cuando al día siguiente el Vaticano reitera oficialmente dichas palabras, te enervas todavía más al comprobar lo desfasada y peligrosa que puede llegar a ser la Iglesia católica como institución. ¡Que se aparten de una vez por todas!, piensas sofocado.
Entonces te relajas de nuevo, y dudas. A ver si resulta que tendrán algo de razón… ¿Qué sé yo lo que le conviene a África? Recuerdas el estudio que demostraba que repartir libros en escuelas africanas no mejoraba el rendimiento escolar de los alumnos, y constatas que las recetas que funcionan en los países ricos no tienen por qué hacerlo en el complejo mundo en vías de desarrollo. Te asaltan ciertos interrogantes, ¿a ver si me estaré dejando llevar yo también por ideas preconcebidas?
Justo tres semanas atrás había visitado Boston y charlado de nuevo con Esther Duflo, una de las directoras del J-PAL. Recordé su mensaje principal: para atajar los problemas de los países en vías de desarrollo debemos utilizar menos ideología y más ciencia. Empecemos por no asumir tan alegremente que conocemos bien las soluciones y sólo se trata de implantarlas, ya que muchos años y millones de dólares invertidos por instituciones como el Banco Mundial, el FMI o infinidad de ONG… demuestran lo contrario. En África se llevan gastadas cantidades ingentes de dinero en proyectos que no funcionan. De nuevo, la propuesta del J-PAL: ante un problema determinado, utilizar la metodología científica para evaluar cuál es la mejor intervención para solventarlo.
¿Habrán realizado algún estudio randomizado para comparar diferentes políticas de prevención del sida? ¿Habrán evaluado científicamente si potenciar el uso del preservativo disminuye el número de contagios? Búsqueda en su web y… ¡bingo! En 2006 Esther Duflo publicó los resultados de un estudio financiado por el Banco Mundial para analizar la conducta sexual de los adolescentes de Kenia, y justo en enero de 2009 Pascaline Dupas había presentado una ampliación
Información insuficiente en Kenia
En las sesiones sobre prevención del sida que se imparten en las escuelas de Kenia se habla de cómo se transmite el virus, de cómo lidiar con personas infectadas, de abstinencia hasta el matrimonio… pero no se mencionan los preservativos. Sí, es inaudito; según el estudio del J-PAL, el programa educativo diseñado por el gobierno keniata sólo se concentra en la abstinencia. El foco principal no es «reducir el riesgo», sino «evitarlo». ¿Es la mejor estrategia? Eso es lo que pretendían averiguar.
Para ello seleccionaron 328 escuelas con un total de 70.000 adolescentes, las dividieron en grupos de condiciones similares, y a cada uno de ellos aplicaron diferentes intervenciones. Al cabo de dos años contabilizaron el número de embarazos, que en tales edades es un buen indicador del sexo inseguro.
En un grupo de escuelas se entrenó a los maestros para enseñar sólo el programa oficial del gobierno, en otras se debatía abiertamente sobre el uso de los condones, y en otro tomaban medidas para que las adolescentes permanecieran más tiempo en la escuela. En la ampliación del estudio hecha por Dupas también se informaba a las estudiantes de que los hombres de edad avanzada tenían índices de sida mucho mayores (en Kenia es muy habitual que las adolescentes tengan sexo inseguro con personas adultas). También se hicieron tests antes y después del estudio para conocer cómo se había modificado la conducta sexual de los adolescentes.
De los estudios de Duflo y Dupas surgieron una serie de conclusiones: seguir el programa oficial centrado en la abstinencia no disminuía el número de embarazos. Informar sobre el riesgo de mantener relaciones con personas mayores hacía que las niñas modificaran la edad de sus parejas. Informar sobre el uso de preservativos fomentaba su uso sin aumentar el número de relaciones sexuales. Y mantener a las niñas en la escuela también lograba disminuir el número de embarazos.
En concreto, en el estudio de Dupas se observó que la estrategia del gobierno de «eliminar el riesgo» no era efectiva, mientras que la campaña ampliada que proponía «reducir el riesgo» (informar sobre el uso de los preservativos y la distribución del sida por edades) logró aumentar el uso de preservativos sin incrementar el número total de relaciones sexuales. Y como consecuencia, redujo en un 28 por ciento el número de embarazos entre las adolescentes, el parámetro utilizado como referencia al sexo inseguro.
Por lo tanto, estos estudios científicos (y otros que vienen citados en la bibliografía científica) contradicen claramente las palabras de Benedicto XVI. Fomentar el uso del preservativo sí tiene resultados positivos en la lucha contra el sida.
No es un dato nuevo para los que ya saben que no deben hacer mucho caso a lo que diga el Papa, pero por desgracia no todo el mundo es consciente de ello, y resulta que el gobierno de Kenia todavía mantenía un programa de prevención en escuelas centrado en la abstinencia, cuando podrían estar reduciendo en un 28 por ciento el riesgo de contagio entre sus adolescentes.
El J-PAL no es el único ni el primero en hacer evaluaciones de impacto sobre programas sociales, pero sí es el pionero en aplicar un planteamiento tan científico como los estudios randomizados. Con ellos, está obteniendo información muy útil para los gobiernos, las ONG, o el propio Banco Mundial, organizaciones conscientes de que en algunas ocasiones están invirtiendo muchos esfuerzos y recursos sin obtener los resultados que desearían. Desde luego que estos estudios no dan respuestas definitivas, y tienen detractores que se quejan de sus altos costes, de si resultan éticos, y de si sus resultados son realmente extrapolables. Pero están en pleno auge y prometen ser una herramienta tremendamente útil para conocer mejor las problemáticas del mundo en vías de desarrollo, y conseguir intervenciones más efectivas para quizá lograr que ésta sea realmente la primera generación que erradique la pobreza extrema. Imposible no es.
6.3. Somos la generación que puede erradicar la pobreza extrema
«Erradicar la pobreza extrema es el reto moral más importante de este siglo», dijo el ex candidato presidencial John Edwards durante una fabulosa serie de conferencias organizadas en abril de 2008 en el MIT para contrastar perspectivas en la lucha contra esta lacra de nuestra sociedad. «Hombre, mal andaríamos si no fuera así.», pensé al oír su frase. Sí, ya sé que siempre ha existido la pobreza y es un problema endémico cuya solución puede parecer utópica. Pero no lo es. Si superada la crisis actual el mundo desarrollado sigue el ritmo de progreso de las últimas décadas, no se produce ninguna hecatombe o colapso económico, y a finales de este siglo continúan muriendo 20.000 personas al día por no tener lo mínimo para sobrevivir, habremos fracasado estrepitosamente. Sinceramente, no puedo contemplar este escenario, y estoy convencido de que en algún momento de la primera mitad de este siglo se habrá alcanzado el fin de la pobreza extrema.
Antes de que me taches de idealista, déjame que insista en la palabra «extrema». Definida por los organismos internacionales como tener menos de un dólar al día, la pobreza extrema es «la pobreza que mata». Significa no cumplir las necesidades más elementales: hambre crónica, no tener acceso a agua potable, ni a una mínima medicación, ni a una simple mosquitera que redujera drásticamente las posibilidades de padecer malaria. Es inaceptable que 20.000 personas —la mayoría niños— mueran cada día por estos motivos, cuya solución es factible. No se trata sólo de pasividad de los países ricos; y seguro que en el futuro quedarán reductos de pobreza o gobiernos corruptos en los que la ayuda humanitaria será ineficiente. Quizá «erradicar» es una palabra demasiado contundente; pero si dentro de cuarenta años la cifra de 20.000 muertes por pobreza extrema no se ha reducido drásticamente, sí deberemos exigir responsabilidades a nuestros propios gobiernos, organismos multilaterales, y al creciente número de expertos cuya misión directa es gestionar la ayuda al desarrollo y hacer que llegue a quienes más la necesitan.
Una de estas personas que puede convertirse en héroe o villano es Jeffrey Sachs, el director del Proyecto Milenio de las Naciones Unidas cuyo objetivo repitió en una multitudinaria conferencia en el MIT: reducir la pobreza extrema a la mitad en 2015, y erradicarla en 2025.
Sachs fue el invitado estrella del acontecimiento. Su intervención se tuvo que celebrar en un polideportivo porque en el auditorio no había espacio para todos los estudiantes que querían vitorear a la persona que representaba el lema de la conferencia: «Queremos ser la generación que termine con la pobreza».
Todos los participantes habían expuesto sus diferentes perspectivas. Tras denunciar lo poco que estaba haciendo su propio país tanto a escala global como local, el senador John Edwards habló de generar voluntad política, incitó a los jóvenes a involucrarse activamente en movimientos, y pidió a los asistentes: «Vota a quien se comprometa a luchar contra la pobreza». Paul Farmer, fundador de la exitosa organización Partners in Health, pronunció una provocativa charla titulada «Esto no es un hobby: tomarse la pobreza global en serio», en la que se quejó de algunas ONG que «se esparcían como setas» y realizaban tareas minúsculas que no aportaban ningún beneficio real. Para romper el ciclo de la pobreza, argumentó, hace falta ciencia, innovación, liderazgo, gran profesionalidad, gobiernos estables, políticas públicas a gran escala, y cambiar aspectos de nuestra propia cultura; no la de los países pobres. Paul Farmer se centró en temas médicos, Amy Smith del D-Lab en intercambio tecnológico, John Wood en educación, Henrietta Fore en cómo lograr el crecimiento económico a escala local, Ira Magaziner en política pública y en el respeto que debemos tener a los gobiernos locales para no caer en un nuevo neocolonialismo… Pero el colofón vino de la persona cuya misión era dirigir un grupo con 300 de los mejores expertos del mundo para coordinar todos los esfuerzos en lograr que los Objetivos del Milenio se convirtieran en realidad.
El fin de la pobreza
Jeffrey Sachs es una de las personas más poderosas en el campo del desarrollo, y no se anduvo con rodeos: sus esfuerzos se concentran en the poorest of the poor, «los más pobres entre los pobres». Estas personas están atrapadas en una poverty trap, «trampa de pobreza», que les impide plantear cualquier tipo de progreso. «Viven» en unas condiciones tan lamentables que no está en sus manos escapar. Lo que necesitan de nosotros es que les demos un big push, «gran empujón», para sacarles de esa dinámica y que puedan empezar su desarrollo.
«Está en nuestras manos», dice en su libro El fin de la pobreza. «Y sabemos qué debemos hacer», aseguró en su charla: mejorar las técnicas agrícolas y fertilizar suelos, proveer agua potable, dar redes contra la malaria a todos los que estén expuestos, antirretrovirales contra el VIH, escuelas con comida gratuita a los niños, desparasitamiento anual, proveer de electricidad a hospitales y escuelas… Suena tan básico y obvio que parece ridículo. Nadie dice que estas medidas sean fáciles de implementar, pero, según Sachs, eso de que «en realidad no sabemos cómo afrontar el problema» es un mito, y «la corrupción impide actuar de forma eficiente» o «los países ricos ya dedican mucho dinero sin conseguir resultados», excusas. Sachs asegura que los científicos de su equipo saben muy bien cómo mejorar los nutrientes del suelo, los médicos cómo detener la mortalidad infantil, y los hidrólogos cómo hacer llegar agua potable a las comunidades. Ya hay muchos estudios y conocimiento acumulado. Ahora se trata de actuar por fin con contundencia, recursos, inteligencia y dotes para negociar con gobiernos corruptos. El plan está diseñado, lo que falta es muchísimo más dinero para poder llevarlo a cabo y conseguir los Objetivos del Milenio.
Sachs explicó que hace treinta y cinco años los países ricos aceptaron dedicar el 0,7 por ciento del producto nacional bruto a ayudas al desarrollo; en 2002 este consenso volvió a ser firmado en Monterrey, pero de momento sólo Noruega, Suecia, Holanda, Dinamarca y Luxemburgo lo habían cumplido. Otros países europeos tenían planes específicos para hacerlo, pero Estados Unidos ni de cerca. Resulta irritante pensar que, según sus datos, en 2005 el gobierno estadounidense invirtió 500.000 millones de dólares en gasto militar, y menos de 2.000 millones en África. «Está en nuestras manos», «Es el reto más importante de nuestra generación», coreaban brillantes estudiantes de Harvard y el MIT decididos a dirigir toda su capacidad intelectual a luchar contra la pobreza y apartar de su camino a fósiles escépticos apoltronados en sus despachos si era necesario.
Críticas al mesías salvador
Desde luego, hay voces discrepantes con el modelo de los Objetivos del Milenio y esa pretenciosa actitud del hombre rico y listo de Harvard que sabe lo que le conviene al pobre y tosco de África.
La más representativa es la del también economista William Easterly, que en su libro The White Man 's Burden critica agriamente la manera en que los países ricos pretenden ayudar a los más pobres. Su queja principal: el dinero se despilfarra y no llega a quien realmente lo necesita. No está solucionando problemas básicos, y nadie asume responsabilidades de lo fatal que se han gestionado billones de dólares en ayuda al desarrollo durante los últimos sesenta años. ¿Cómo puede ser que tanto tiempo y dinero después todavía estén muriendo 3.000 niños al día por la picadura de un mosquito?, se pregunta Easterly.
No es el arrebato simplista de alguien que desconoce las problemáticas intrínsecas de los países africanos. Más bien todo lo contrario. Easterly ha estado toda su vida vinculado a la ayuda al desarrollo, es profesor de la Universidad de Nueva York, y trabajó durante dieciséis años en el Banco Mundial antes de que la publicación de su primer libro En busca del crecimiento provocara su marcha.
El principal blanco de sus críticas son los —según él— grandilocuentes Objetivos del Milenio dirigidos por el utópico Jeffrey Sachs, que está convencido de poder erradicar la pobreza extrema en África con una buena estrategia técnica y mucho más apoyo económico. En la encarnizada —y mediatizada— lucha que mantienen, Easterly viene a decirle: ¿todavía quieres más dinero? ¿Dónde está todo el que ya os habéis gastado en ayuda al desarrollo durante seis décadas? Ha servido para bien poco. ¿Cómo puede ser que después de haber gastado 2,3 billones de dólares todavía haya niños muriendo porque no reciben medicinas que cuestan 12 céntimos? Si fuera tan fácil, ya lo habríais conseguido. ¿Cuándo aceptaréis que vuestro enfoque tradicional de hombre rico que se empeña en hacer grandes planes y decirle al pobre qué es lo que necesita no funciona? La trampa de la pobreza es una leyenda que lleva repitiéndose desde décadas, y los big plans o «grandes planes» utópicos han hecho más mal que bien. Cuando decís «nuestra», pecáis de la arrogancia inconsciente del hombre blanco que trata al pobre como si fuera un ingenuo que no sabe qué necesita. Salir de la pobreza está en sus manos, no en las tuyas. Sácate de encima esta actitud de mesías que va a salvar el mundo. No busques expertos técnicos de fuera, sino a gente dentro del país. Apóyales a que sean ellos mismos quienes se ayuden. No impongas planes ni propongas soluciones en su nombre. Ve y pregúntales qué necesitan. Sé constructivo y trabaja con un enfoque de abajo arriba en lugar de con grandes planes de arriba abajo. La ayuda al desarrollo ha solucionado algún problema específico, pero la pobreza sólo puede atajarse trabajando desde la base y reformando poco a poco las estructuras sociales, económicas y políticas locales. Estimula el mercado de abajo arriba, sáltate a los gobiernos cuando detectes la mínima corrupción, trabaja a escala local, con gente local, y no tengas prisa en eliminar la pobreza de golpe, porque las prisas nunca han funcionado. Y por favor, asegúrate de que el dinero llegue a quien realmente lo necesita. Hay mucha gente y organizaciones trabajando desde esta perspectiva. Dales más recursos a ellos en lugar de gastarlos en burocracia y gobiernos corruptos.
Sé un searcher, «buscador», en lugar de un planner, «planificador», diferencia Easterly en su libro. Los planificadores conciben la pobreza como un problema técnico que sus expertos son capaces de solucionar Deciden qué es necesario y lo aplican con una mentalidad occidental Los buscadores averiguan qué necesita la gente, y les ayudan a que ellos lo implanten. Asumen que no hay un plan que pueda eliminar la pobreza, sino que se debe ir construyendo poco a poco.
Es abstracto, lo sé. Si quieres atajar un problema de salud, ¿te traes a médicos y tecnología del exterior que salve más vidas en primera instancia, o sigues un proceso más lento que involucre a la gente local desde el principio y sea más eficiente a largo plazo? Si un gobierno es corrupto, ¿continuamos trabajando con él, o buscamos la manera de saltárnoslo? Si quiero mejorar la producción agrícola, ¿traigo expertos y tecnología de fuera, o ayudo a que los locales se desarrollen? Si necesitan redes anti mosquitos, ¿cojo a voluntarios que las repartan gratis, o les hago a ellos partícipes del proceso de distribución y venta? Planteado en términos generales, quizá un planner se sentirá más inclinado a lo primero y un searcher a lo segundo, pero la realidad es que a la práctica estas categorías se diluyen y la situación concreta que afrontes marcará cuál es la mejor actuación a seguir. Y aquí, de nuevo, es donde la ciencia puede ofrecer algunas respuestas.
La perspectiva de la ciencia
¿Qué es más efectivo?, ¿repartir gratuitamente redes anti mosquitos a los poblados africanos aquejados de malaria, o hacerles pagar un precio mínimo, simbólico, para que las valoren más y terminen utilizándolas correctamente? Éste representa uno de los debates que más disputas ha generado. Un searcher como Easterly argumenta que regalar redes anti mosquitos no es eficiente, porque quien la recibe gratis no le da valor, no la cuida, y la termina perdiendo o utilizando para otros fines. En cambio, si las incorporas a su sistema como si fuera otro bien, las subvencionas para que sean muy baratas, y haces que paguen una cantidad módica, conseguirás implantar de verdad su uso. Un planner como Sachs dice: no perdamos más tiempo y démosles redes ya. ¿A qué esperamos? Pero ¿cómo sabemos quién tiene razón? La opción searcher parece más lógica, pero también podríamos argumentar que ese desinterés por lo gratuito es algo bastante occidental.
Hay gente que se aleja a conciencia de las ideas predeterminadas, y tiene otras herramientas para testar hipótesis: los científicos. Y resulta que el Poverty Action Lab del que he hablado unas páginas atrás hizo un estudio en el que comparó dos tipos de intervenciones: dar las redes gratuitamente, y hacer pagar un mínimo por ellas. Tuvo todos los otros condicionantes bajo control, y observó qué ocurría en diferentes aspectos. En el fondo, el planteamiento es parecido a comparar diversos tratamientos para ver cuál es más eficiente frente a una enfermedad. En el estudio de las redes anti mosquitos, no se encontró diferencias en el uso por parte de quienes las habían recibido gratis y los que habían pagado precios bajos. Ambos las utilizaban de manera parecida. En cambio, por muy ínfimo que fuera el coste, hacía que menos gente las adquiriera. Esto era consistente con algunas teorías psico económicas que explican que por irrisorio que sea el precio, hay una diferencia enorme entre gratis y casi gratis. En definitiva, la conclusión final del estudio fue que distribuir redes gratuitamente podía salvar más vidas que hacerlas pagar.
Sería arrogante pretender que, simplemente por tratarse de la aproximación más científica, es lo único que debemos considerar. Es sólo una información más que, en este caso, contradice a Easterly, y en otros le podría corroborar. Solucionar la pobreza extrema es una tarea complejísima, nadie lo niega. Pero no es imposible como parece insinuar Easterly al decir que él no propone ningún plan alternativo a los inalcanzables Objetivos del Milenio porque no hay plan que valga, sino sólo trabajo desde la base.
Merece mucho la pena escuchar la visión crítica de William Easterly, puesto que esconde una lógica aplastante y viene avalada por los innegables malos resultados que ha cosechado la ayuda al desarrollo impulsada desde la década de 1950. Pero sería injusto no reconocer que las cosas están cambiando. Easterly hace una caricatura inmerecida de los planners y organismos internacionales, obvia que la ayuda al desarrollo cada vez es más eficiente y está evaluada, y que los profesionales están mucho mejor capacitados e informados de lo que él deja entrever. Sachs responde a sus quejas diciendo: ¡Estamos haciendo justamente todo lo que solicita! Y tenemos indicios de que eso es así. Confiamos en sus posibilidades, y no perdemos el optimismo propio del científico que sólo ve límites en lo sobrenatural, y cuando se enfrenta a grandes retos mira hacia atrás y ve lo que la ciencia ha conseguido en el último siglo. Una de las lecciones que mejor recuerdo en plena etapa de negatividad adolescente fue cuando mi padre me dijo: «Debes buscar soluciones en lugar de problemas». Eso es lo que hace la gente como Jeffrey Sachs. ¿Utópico? Quizá un poco; lo justo. Yo salí del congreso del MIT convencido de que erradicar la pobreza extrema era algo realmente viable. Contemplábamos los errores del pasado para aprender de ellos y procurar que no se vuelvan a repetir. E incorporábamos el desarrollo científico a la ecuación para que aportara todas las soluciones técnicas, farmacológicas, metodológicas, humildad e irreverencia política, que contribuirían a hacer este sueño realidad por primera vez en la historia. Luego leí a Easterly y llegué a Washington D. C., donde todos mis amigos del Fondo Monetario Internacional, el Banco Mundial y el Banco Interamericano de Desarrollo me explicaban las dificultades que se encontraban en los países de origen, lo atados que estaban por los gobiernos, la lentitud burocrática, la falta de recursos, sus propios problemas de gestión interna… y te hacían tocar tierra. Pero luego, enseguida despegabas de nuevo, te proyectabas hacia el futuro, y lo que te parecía imposible era llegar a viejo y que en el mundo todavía estuvieran muriendo 20.000 personas al día por una evitable pobreza extrema que impide el acceso a comida, medicamentos básicos, una simple red, agua potable, o a un maestro. Es el gran reto de nuestra generación, y lo vamos a conseguir Y no lo digo simplemente como final feliz.
Epílogo
No nos quitemos las gafas de la ciencia
Cada vez que enciendes tu ordenador o te conectas a internet desde un simple teléfono móvil, ves cómo la ciencia y la tecnología están transformando nuestras actividades cotidianas. Cuando acudes al médico constatas cómo la investigación científica mejora nuestra calidad de vida. Al oír hablar de cambio climático o pandemias, no dudas en considerarla la mejor herramienta para intentar solucionar los problemas globales que afectan a toda la humanidad. Y cuando sientes ansias de comprender el mundo que te rodea recurres primero a las gafas de la ciencia para que te regalen respuestas fiables y descubran nuevos conocimientos que sin ellas ni siquiera sabrías de su existencia.
La ciencia ya envuelve tu entorno y forma parte de tu vida. Deja que también impregne tu manera de pensar. No la limites a saciar tu sed de conocimiento y hacerte el día a día más cómodo. Da un paso más, y permite que algunos valores de la ciencia se integren en tus hábitos de pensamiento y te ayuden a reflexionar desde una perspectiva científica. Algunas lecciones extraídas de su metodología y manera de afrontar problemas pueden ser muy positivas para ti y, sin duda, para los dirigentes que nos gobiernan.
§. Pon un poco de ciencia en tu vida
La ciencia es optimista
Ésta es una de las primeras sugerencias que hay que aprovechar. Sin la fuerza del optimismo, los neurocientíficos no pretenderían comprender cómo funciona el cerebro humano, los cosmólogos no investigarían el origen del universo, ni los biólogos lucharían por sortear todas las dificultades en dirigir los avances en células madre hacia unas terapias que en el futuro podrán sanar enfermedades ahora incurables. El entusiasmo les mueve. Pero no a todos; sólo a aquéllos que logran superar las jerarquías armados con sus datos y determinación en superar las adversidades.
Cuando un científico o ingeniero mira al pasado y comprueba todo el conocimiento y las aplicaciones que sus compañeros han sido capaces de construir, siente una renovada confianza y huye del derrotismo y la negatividad que impregnan otros sectores de nuestra sociedad. Con ayuda, tiempo, colaboración, metodología rigurosa, y actitud crítica pero constructiva, no existen problemas irresolubles ni retos inalcanzables. Nadie asume que el camino sea sencillo, pero la confianza y el tener referencias a largo plazo es lo que alimenta sus carreras. Y, sin duda, beneficiaría a quien quisiera tomar ejemplo.
La ciencia piensa a largo plazo
Es algo tremendamente costoso. Nuestro cerebro no ha evolucionado para tomar decisiones en función de qué será mejor de aquí a veinte años. El futuro no estaba garantizado para nuestros antepasados. A título individual, tenemos razones para no desdeñar del todo estas enseñanzas de la selección natural, pero la visión a corto plazo es una de las actitudes más peligrosas de los economistas, los directivos y los líderes políticos. La ciencia está acostumbrada a trabajar a un ritmo lento pero constante, y a hacer predicciones sobre el impacto que sus cometidos tendrán en el futuro. No sabe lo que son las legislaturas de cuatro años. Por eso construye un acelerador de partículas cuyos resultados y beneficios tardarán lustros en llegar, intenta averiguar las consecuencias de fumar un paquete de cigarrillos al día desde los veinte años, construye modelos para prever los efectos de continuar emitiendo dióxido de carbono a la atmósfera, y busca soluciones pensando qué fuente de energía será más rentable a décadas vista. La ciencia ofrece una perspectiva muy valiosa sobre el futuro, que algunos se empeñan en desoír cuando contradice sus creencias o intereses inmediatos.
La ciencia es inconformista
Mira los físicos teóricos que están empecinados en intentar encajar la mecánica cuántica y la relatividad, porque a pesar de que funcionan sumamente bien por separado, cuando las combinan hay algunos detalles que no cuajan por completo. Pero ¡qué diantre les importa! ¿No podrían utilizar una u otra cuando más les conviene y sanseacabó? Pues no; ellos insisten en que algo falla en su comprensión más íntima de la naturaleza, y se inventan supercuerdas o gravedades cuánticas para corregir aquello que no termina de encajarles. Es una actitud loable. De hecho, la misión científica más valiosa no es confirmar lo que ya suponemos, sino desafiar constantemente nuestro conocimiento establecido; buscar flecos y escudriñar en ellos hasta intentar solventarlos. Ese inconformismo, esa irreverencia, ese desafío crítico al orden establecido, es lo que se echa en falta en algunos aspectos de nuestra sociedad cuando claros indicios nos muestran que algo falla en las creencias, las costumbres, o los sistemas que arrastramos de nuestra pesada carga genética o influencia cultural El espíritu contestatario y el no hacer caso de estos nimios desajustes que una vocecita sutil nos insinúa que no encajan es lo que hace crecer a la ciencia, la sociedad, y nuestra riqueza individual.
La ciencia es colaborativa
En plena guerra fría había científicos rusos y estadounidenses que colaboraban, ignorando los conflictos políticos que sus estados mantenían Y lo mismo ocurre ahora con Cuba, Irak, Pakistán, Estados Unidos, o países entre los que en teoría existe más competencia que colaboración. Muchos investigadores están acostumbrados a desdeñar fronteras e intereses nacionales cuando se trata de intercambiar ideas y cooperar en problemas a escala global. Por eso en los últimos años está emergiendo el campo de la diplomacia científica, una disciplina que busca aprovechar las buenas relaciones científicas existentes entre diferentes sociedades para abrir canales de comunicación y pulir asperezas. En los momentos de más tensión de la guerra fría, fueron las organizaciones científicas las que hicieron de puente en el debate sobre el control nuclear. La ciencia es universal por definición, y en su metodología no aparecen las palabras raza, género, religión o nacionalidad. Hay una fuerte motivación en avanzar hacia el bien común y en cooperar siempre que sea posible. Además, debido a su meritocracia y transparencia, goza de una relativa confianza entre la población. La ciencia puede ofrecer esperanza y contribuir a facilitar la diplomacia internacional si conseguimos darle más relevancia en nuestra sociedad.
La ciencia está por encima de la ideología
Todos tenemos ideas, opiniones personales, o hipótesis propias, tanto los científicos como el resto de los mortales. Pero mientras unos las defienden, otros las ponen a prueba experimentalmente. El dogmatismo se basa en atender de manera arbitraria sólo a las evidencias que refuercen tus inflexibles creencias. En cambio, el motor del progreso científico es la predisposición a destronar a tu maestro y rectificar el conocimiento establecido. Es una actitud terriblemente difícil, y que pocos investigadores están preparados para aceptar. Escuchar de manera objetiva, humilde, y reconocer los errores cuando las evidencias te contradicen, sólo está al alcance de aquellos sabios convencidos de que la verdad tiene fecha de caducidad, y que la razón te la otorgan, nunca se impone. Es una lección tan importante a nivel personal y profesional, y que podría beneficiar tantísimo a la sociedad si nuestros políticos la asumieran cuando se enfrentan a problemáticas concretas, que merece un apartado específico.§. El respeto por la verdad: Piensa como un científico, no como un abogado
Ya lo he comentado en apartados anteriores de este libro. Sin intención de ofender a ningún sector profesional, caricaturizamos las categorías de abogado y científico como dos visiones antagónicas a la hora de afrontar conflictos. Es una entelequia, pero lo hacemos para enmarcar ideas e ilustrar nuestra profunda tendencia a actuar como los primeros, y lo positivo que sería tener la mentalidad de los segundos.
¿Qué hace un abogado en su despacho? Llega un cliente y se prepara para defender su caso. ¿Qué ocurre si percibe que su cliente no es del todo inocente? No importa; su trabajo es buscar evidencias que decanten la opinión del juez hasta lograr que su percepción de la realidad sea lo más favorable a su cliente. La «verdad» objetiva detrás del asunto no es lo más importante; se puede distorsionar atendiendo sólo a las pruebas favorables, y esforzándose en desbaratar las de su contendiente, por veraces que sean. «Lo que no está en los autos, no está en el mundo», aprenden en la Facultad de Derecho. Y «hay dos verdades, la real y la del caso», reza otra de sus frases míticas.
No lo percibas como alguien innoble; en realidad es lo que la mayoría solemos hacer —científicos de profesión (que no de alma) incluidos— ante cualquier discusión o circunstancia donde nuestro interés particular esté en juego. Defender tu verdad subjetiva y el beneficio de tus allegados es lo más normal del mundo. Pretender poseer siempre la razón es algo instintivo. Lo extraño es tener alma científica y percibirlo como una falta de respeto a la verdad y un sacrilegio hacia la comprensión íntima de la realidad que subyace en nuestra falaz percepción del mundo. Sin dejarnos arrastrar por visiones utópicas, nuestra sociedad funcionaría considerablemente mejor si lográramos tener más mentalidad de científicos que de abogados. Si huyéramos de ideas predeterminadas y tomáramos decisiones basadas en la evidencia. De nuevo, pedirle a la abuela que no considere a su nieto el más guapo y bondadoso de su pueblo es improcedente. Pero concebir la duda como una aliada metodológica y no como una enemiga pecaminosa es un reflejo de sabiduría. Aprender a escuchar con atención a tus discrepantes es cualquier cosa menos un signo de debilidad. Y mostrarte abierto a rectificar si los datos empíricos así lo sugieren, acortaría discusiones interminables y daría un mayor grado de sensatez a nuestra vida cotidiana. La ciencia ha demostrado holgadamente el éxito de su perspectiva a la hora de resolver problemas y conflictos dejando de lado la ideología y las posiciones inflexibles. Si esta mentalidad científica fuera asumida por una clase política dominada por abogados entrenados en defender a toda costa sus intereses intransigentes, se avecinaría una revolución de impacto sin precedentes.
Como actividad humana que es, la ciencia está contagiada de nuestras propias imperfecciones. No pretendemos idealizarla. Pero en su versión más pura, es una maravillosa fuente de conocimiento y una herramienta que en buenas manos ha estado constantemente incrementando nuestro bienestar. Dejemos que impregne también la cultura, e inmiscuya su proceder en lo más profundo de nuestra sociedad. Otorguémosle por fin el papel central que reclama en la construcción de individuos y comunidades más justas y felices.
§. No nos quitemos las gafas de la ciencia
Se acerca el momento de la despedida. Hemos realizado un viaje atosigado por decenas de ciudades diferentes sin detenernos concienzudamente en ninguna. Ojalá os haya estimulado para regresar con tiempo a aquéllas que deseéis visitar con más calma, o exploréis por vuestra cuenta los nuevos parajes científicos que más interés os susciten. La ciencia no se detiene, y cada vez queda más camino por recorrer. Los investigadores están ampliando nuestro conocimiento sobre el cosmos, la vida, la mente o el funcionamiento de las sociedades a un ritmo imposible de abarcar. Por cada respuesta que cierran, abren nuevas preguntas. Nuestra sensación de desconocimiento crece a un ritmo exponencial ¡Es excitante! El trabajo de los científicos es tan lento y minucioso que en ocasiones ellos mismos pierden la perspectiva de lo apasionantes que son sus descubrimientos. Pero tú tienes la oportunidad de seguirlos a cámara rápida y guiado únicamente por tu propio interés. Aprovéchalo. Disfruta de la ciencia como lo haces del arte, la música o la literatura. Es la verdadera aventura intelectual de este siglo. No nos quitemos las gafas de la ciencia, rasquemos donde no nos pique, y ¡busquemos nuevos destinos en el fascinante océano de la ciencia!
Cuando divagamos sobre cómo la ciencia transformará el mundo en el futuro, siempre solemos sobrestimar su impacto a corto plazo e infravalorarlo a largo plazo.
Está claro que no tendremos un hotel orbitando la Tierra en 2012 como en su momento se predijo, ni veremos regenerar nuestros órganos en los próximos diez años. Pero por ficción que nos parezca, sin duda algún día los humanos plantarán pinos en Marte, tendremos una comunicación directa entre el cerebro y el ordenador, y habrá personas viviendo más de ciento cincuenta años. Pronosticar el futuro es fácil, y difícil a la vez. Resulta sencillo hacer predicciones impactantes a cien años vista, o decir que nada fundamental de nuestras vidas cambiará en el próximo lustro. Por eso escojo una fecha intermedia que me dé tiempo a comprobar en qué he acertado cuando, mezclando confesiones de científicos e intuiciones sin renunciar a cierta ingenuidad, me atrevo a hacer un pronóstico de qué habrá ocurrido y qué no de aquí a 2030 sobre los aspectos científicos tratados en este libro.
- La pobreza extrema se habrá reducido drásticamente.
- La secuenciación del genoma será una prueba rutinaria y formará parte del historial médico de quien lo desee.
- En las perfumerías habrá cosméticos especiales para distintos perfiles genéticos. Viviremos un auge comercial alrededor de la información genética.
- Gracias a la extensión del diagnóstico preimplantacional, enfermedades monogenéticas como el Huntington o el Tay-Sachs estarán al borde de la erradicación.
- Detectados a tiempo, y tratados en función de qué mutación específica los causa, la mayoría de los cánceres tendrán cura.
- Habremos descubierto un planeta lejano con signos de vida, y descartado que la haya en algún rincón del sistema solar que no sea la Tierra.
- No conoceremos cómo se originó el universo, pero sí habremos resuelto el misterio de la energía oscura y sabremos por qué el universo se expande de manera acelerada.
- El gran colisionador de hadrones (LHC) habrá confirmado experimentalmente el bosón de Higgs, descubierto nuevas partículas supersimétricas, y resuelto el misterio de la materia oscura.
- Por capricho, la Luna habrá sido pisada de nuevo. No habremos llegado a Marte todavía.
- La era del petróleo barato habrá finalizado, el mix energético se diversificará, y cada región escogerá en función de sus características geográficas.
- La energía solar empezará a utilizarse a gran escala.
- Los biocombustibles serán más baratos que el petróleo.
- En la mayoría de las regiones, las energías renovables serán económicamente más rentables que la fisión nuclear.
- La fusión nuclear estará más cerca, pero como siempre, a veinte años vista.
- La biodiversidad será una fuente de riqueza, y no proteger el medio ambiente algo inconcebible.
- Los aviones continuarán quemando combustible, pero en las ciudades conduciremos coches exclusivamente eléctricos.
- Las emisiones globales de CO2 a la atmósfera se habrán estancado, pero no descendido lo suficiente para frenar el progresivo calentamiento global
- Los gobiernos ricos invertirán cantidades ingentes de dinero en resolver las consecuencias del cambio climático en los pobres.
- Con herramientas de biología sintética diseñaremos microorganismos sintéticos que serán aplicados en procesos industriales.
- Habremos creado vida puramente artificial
- Entenderemos mejor por qué algunos cerebros funcionan mal, pero seguiremos sin comprender el funcionamiento íntimo de los normales.
- Tendremos mecanismos para potenciar de manera dirigida nuestras capacidades cognitivas.
- No nos conformaremos con estar sanos. Cada vez más gente acudirá al médico para mejorar sus cuerpos, no sólo para curarlos.
- Un número inusitado de personas vivirán más de cien años.
- Continuaremos dándole vueltas y vueltas al eterno debate sobre si los genes influyen más que el entorno, o a la inversa, en diferentes aspectos de nuestro comportamiento.
- La ciencia se apartará cada vez más de la religión, y habrá tensiones continuas.
- Gracias a las células madre algunos paralíticos podrán volver a caminar.
- Leeremos la actividad cerebral con precisión suficiente para dirigir objetos con el pensamiento.
- Lograremos modificar personalidades con estimulación transcraneal
- La ciencia será tratada de manera más crítica en los medios de comunicación, y desde una perspectiva más social
- La química continuará mejorando el mundo, y recobrará el prestigio social que merece.
- La esencia de la vida será investigada por químicos. No biólogos, ni físicos.
- Habrá traductores de voz instantáneos.
- No tendremos robots humanoides en nuestras casas.
- No habrá nacido un ser humano clonado.
- Los ordenadores no serán más inteligentes que nosotros.
- No tendremos todavía ordenadores cuánticos.
- Nuestro cuerpo albergará sensores que transmitirán información a internet, interpretándola.
- Enfermos del corazón, o epilépticos, o incluso personas sanas llevaremos un dispositivo insertado en nuestro cuerpo, que registrará a tiempo real señales cerebrales y monitoreará sustancias químicas en la sangre que nos avisarán instantes antes de sufrir un contratiempo.
- La interpretación científica del mundo continuará ganando terreno a las visiones religiosas.
- Los políticos continuarán siendo economistas y abogados acostumbrados a la relatividad de la verdad, pero escucharán más a los científicos.
- La ciencia tendrá una función más pragmática en la sociedad.
- Con la nueva generación de científicos, la relación patentes/publicaciones científicas en España habrá aumentado significativamente.
- Quien ahora empiece a estudiar ciencia tendrá un buen trabajo y una profesión estimulante.
¿Estás de acuerdo?, ¿añadirías algo?, ¿lo quitarías? ¿Tú qué piensas?
Qué suerte que podremos seguir conversando…
Muchos libros han captado la promiscua atención del ladrón de cerebros durante la gestación de esta obra. Algunos demasiado técnicos, otros muy específicos, presento aquí una selección que no pretende ser exhaustiva pero sí cumplir dos requisitos básicos: uno, me gustaron sobremanera, y dos, confío plenamente en que pueden generar el mismo efecto en un lector no especializado.
Neurociencia y comportamiento humanoAriely, Dan, Las trampas del deseo, Ariel, 2008.
Damasio, Antonio, El error de Descartes, Crítica, 2006.
Dennet, Daniel, Freedom Evolves, Penguin, 2004.
Gazzaniga, Michael, Human: The Science Behind What Makes Us Unique, ECCO, 2008.
—Psychological Science, Norton, 2009.
Gilbert, Daniel, Stumbling on Happiness, Vintage 2007.
Gladwell, Malcolm, Blink: Inteligencia intuitiva. ¿Por qué sabemos la verdad en dos segundos? Taurus, 2005.
Pinker, Steven, The Blank Slate: The Modern Denial of Human Nature, Penguin, 2003.
Ramachandran, V. S., Phantoms in the Brain: Probing the Mysteries of the Human Mnd, Harper Perennial, 1999.
Restak, Richard, The Naked Brain: How the Emerging Neurosociety is Changing How We Live, Work, and Love, Harmony Books, 2006.
Rose, Steven, The Future of the Brain: The Promise and Perils of Tomorrow’s Neuroscience, Oxford University Press, 2006.
Cosmología
Gleick, James, Chaos: Making a New Science, Penguin, 1987.
Grenne, Brian, El universo elegante, Crítica, 2006.
Hawking Stephen W., El universo en una cáscara de nuez, Crítica, 2004.
Isaacson, Walter, Einstein: Su vida y su universo, Debate, 2008.
Kaku, Michio, Física de lo imposible, Debate, 2009.
Kirshner, Robert, The Extravagant Universe: Exploding Stars, Dark Energy, and the Accelerating Cosmos, Princeton Science Library, 2004.
Randall, Lisa, Warped Passages: Unraveling the Mysteries of the Universe’s Hidden Dimensions, Harper, 2006.
Sagan, Carl, Cosmos, Ballantine Books, 1980.
Smolin, Lee, The Trouble With Physics, Mariner Books, 2007.
Strogatz, Steven, Sync: How Order Emerges From Chaos In the Universe, Nature, and Daily Life, Hyperion, 2004.
Biología
Arsuaga Juan Luis, La especie elegida, Temas de Hoy, 1998.
Collins, Francis, The Language of Life: DNA and the Revolution in Personalized Medicine, Harper, 2010.
Dawkins, Richard, The Selfish Gene, Oxford, 1976.
—Destejiendo el arco iris, Tusquets, 2000.
Gould, Stephen Jay, La vida maravillosa, Crítica, 1991.
Lewontin, Richard, Steven Rose y Leon Kamin, No está en los genes: Racismo, genética e ideología, Crítica, 2004.
Margulis, Lynn, y Dorion Sagan, What Is Life, University of California Press, 2000.
Sampedro, Javier, Deconstruyendo a Darwin, Crítica, 2002.
Sandel, Michael, The Case Against Perfection: Ethics in the Age of Genetic Engineering, Harvard University press, 2009.
Wilson, E. O., Sociobiología: la nueva síntesis, Omega 1974.
Zimmer, Carl, Parasite Rex, Arrow Books, 2003.
Interioridades de la ciencia
Buring Julie, y Charles Hennekens, Epidemiology in Medicine, Lippincott Williams & Wilkins, 1987.
Elías, Carlos, La razón estrangulada, Debate, 2008.
Jasanoff, Sheila, States of Knowledge: The Co-production of Science and the Social Order, Routledge, 2004.
Kuhn, Thomas, The Structure of Scientific Revolutions, University of Chicago Press, 1996.
Latour, Bruno, Laboratory Life, Princeton University Press, 1986.
Lemov, Rebecca, World as Laboratory: Experiments with Mce, Mazes, and Men, Hill and Wang 2006.
Monod, Jacques, El azar y la necesidad, Metatemas, 1981.
Popper, Karl, El mito del marco común, Paidós, 1997.
Varmus, Harold, The Art and Politics of Science, Norton, 2010.
Watson, James, La doble hélice, Salvat, 2000.
Rascar donde no pica
Brockman, John, La tercera cultura, Tusquets, 2002.
Bryson, Bill, Una breve historia de casi todo, RBA, 2004.
De Waal, Frans, The Age of Empathy: Nature’s Lessons for a Kinder Society, Crown, 2009.
Diamond, Jared, Armas, gérmenes y acero, Debate, 2006.
Easterly, William, The White Man 's Burden, Penguin, 2007.
Feynman, Richard, Surely You’re Joking, Mr. Feynman!, Norton, 1997.
Fisher, Helen, Why We Love: The Nature and Chemistry of Romantic Love, Holt, 2004.
Hofstadter, Douglas, Godel, Escher, Bach: An Eternal Golden Braid, Penguin, 2000.
Punset, Eduard, Cara a cara con la vida, la mente y el universo, Destino, 2004.
—El viaje a la felicidad, Destino, 2005.
Roach, Mary, Bonk: The Curious Coupling of Science and Sex, Norton, 2009.
Sachs, Jeffrey, The End of Poverty, Penguin, 2006.
Sapolsky, Robert, Monkeyluv, Scribner, 2005.
Schrodinger, Erwin, ¿Qué es la vida?, Tusquets, 1983.
Wagensberg, Jorge, Ideas para la imaginación impura, Tusquets, 2002.
Wood, John, Leaving Microsoft to Change the World, Harper, 2007.
Notas: